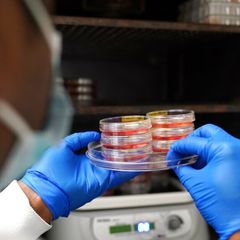

Coronavirus News Review at 10 a.m. EST Daily
Coronavirus Current News:
https://www.inoreader.com/stream/user/1006407045/tag/Coronavirus%20News/view/html?cs=m&sb=y
Selected Articles Review From The News And Times -
https://thenewsandtimes.blogspot.com/
Current Selected Articles: https://www.inoreader.com/stream/user/1006407045/tag/user-favorites/view/html
All Current Articles: https://www.inoreader.com/stream/user/1006407045/tag/all-articles/view/html |
 | SyneuRx completes enrolment in Phase II trial of Covid-19 oral antiviral - Clinical... |
| SyneuRx completes enrolment in Phase II trial of Covid-19 oral antiviral Clinical Trials Arena |
 "Covid-19" - Google News 7m "Covid-19" - Google News 7m |
| Population-level implications of the Israeli booster campaign to curtail COVID-19... |
| submitted by /u/Bifobe [link] [comments] |
 COVID-19 7m COVID-19 7m |
| Coronavirus Omicron variant, vaccine, and case numbers in the United States: April... |
| Coronavirus Omicron variant, vaccine, and case numbers in the United States: April 14, 2022 Medical... |
 "Omicron" - Google News 8m "Omicron" - Google News 8m |
| Disease X-19 Epidemiology from Michael_Novakhov (39 sites): Google Alert - Covid-19:... |
| COVID-19: How to raise resilient children ... The most common cause of premature greying in children... |
 Disease X-19 from Michael_Novakhov (12 sites) 12m Disease X-19 from Michael_Novakhov (12 sites) 12m |
| Disease X-19 Epidemiology from Michael_Novakhov (39 sites): Google Alert - covid-19... |
| The racial health disparities experienced by minority populations in the U.S. during the COVID-19 pandemic... |
 Disease X-19 from Michael_Novakhov (12 sites) 12m Disease X-19 from Michael_Novakhov (12 sites) 12m |
| Disease X-19 Epidemiology from Michael_Novakhov (39 sites): Google Alert - covid-19... |
| 14, 2021, file photo, a health worker administers a dose of a Pfizer COVID-19 vaccine during a vaccination... |
 Disease X-19 from Michael_Novakhov (12 sites) 12m Disease X-19 from Michael_Novakhov (12 sites) 12m |
| Disease X-19 Epidemiology from Michael_Novakhov (39 sites): Google Alert - coronavirus... |
| IMF to lower global growth forecasts due to Ukraine war and Covid. Inflation shock caused by the invasion... |
 Disease X-19 from Michael_Novakhov (12 sites) 12m Disease X-19 from Michael_Novakhov (12 sites) 12m |
| Disease X-19 Epidemiology from Michael_Novakhov (39 sites): Google Alert - covid-19... |
| ... maker Taiko Foods of playing games with an employee's life, after a worker lost the tops of his fingers... |
 Disease X-19 from Michael_Novakhov (12 sites) 12m Disease X-19 from Michael_Novakhov (12 sites) 12m |
| Disease X-19 Publications from Michael_Novakhov (5 sites): Google Alert - coronavirus... |
| The New York Times: New Omicron Subvariants Spreading Fast In New York Two new versions of Omicron, the... |
 Disease X-19 from Michael_Novakhov (12 sites) 12m Disease X-19 from Michael_Novakhov (12 sites) 12m |
| Disease X-19 Epidemiology from Michael_Novakhov (39 sites): Google Alert - coronavirus... |
| A third dose of Pfizer Inc and BioNTech's COVID vaccine produced significant protection against the Omicron... |
 Disease X-19 from Michael_Novakhov (12 sites) 12m Disease X-19 from Michael_Novakhov (12 sites) 12m |
| Disease X-19 Epidemiology from Michael_Novakhov (39 sites): Google Alert - coronavirus... |
| President Hage Geingob yesterday reiterated the need to increase Covid-19 vaccination coverage to achieve... |
 Disease X-19 from Michael_Novakhov (12 sites) 12m Disease X-19 from Michael_Novakhov (12 sites) 12m |
| Disease X-19 Publications from Michael_Novakhov (5 sites): Google Alert - coronavirus... |
| Empty Supermarket Shelves Apology Sign. Covid19 Coronavirus Pandemic affecting supply lines and deliveries... |
 Disease X-19 from Michael_Novakhov (12 sites) 12m Disease X-19 from Michael_Novakhov (12 sites) 12m |
| Disease X-19 Epidemiology from Michael_Novakhov (39 sites): Google Alert - Covid-19:... |
| With the emergence of COVID-19, demands of COVID-related antibodies, proteins and genes product that... |
 Disease X-19 from Michael_Novakhov (12 sites) 12m Disease X-19 from Michael_Novakhov (12 sites) 12m |
| Disease X-19 Epidemiology from Michael_Novakhov (39 sites): Google Alert - covid-19... |
| The latest iteration of APPA's "COVID-19 Pulse Study: Pet Ownership ... Pet owners who reported plans... |
 Disease X-19 from Michael_Novakhov (12 sites) 12m Disease X-19 from Michael_Novakhov (12 sites) 12m |
| Disease X-19 and Security from Michael_Novakhov (10 sites): Google Alert - Coronavirus... |
| If your day doesn't start until you're up to speed on the latest headlines, then let us introduce you... |
 Disease X-19 from Michael_Novakhov (12 sites) 12m Disease X-19 from Michael_Novakhov (12 sites) 12m |
| Disease X-19 Epidemiology from Michael_Novakhov (39 sites): Google Alert - Coronavirus... |
| ... of Health and led Indiana's response to Ebola, Zika and HIV crises. In addition to his recent COVID-19... |
 Disease X-19 from Michael_Novakhov (12 sites) 12m Disease X-19 from Michael_Novakhov (12 sites) 12m |
| Disease X-19 Regions from Michael_Novakhov (8 sites): Google Alert - coronavirus... |
| He's a cardiology professor at the University of Brescia Institute of Cardiology in Italy. More information.... |
 Disease X-19 from Michael_Novakhov (12 sites) 12m Disease X-19 from Michael_Novakhov (12 sites) 12m |
| Disease X-19 Regions from Michael_Novakhov (8 sites): Google Alert - coronavirus... |
| FILE PHOTO: Italian photographer Letizia Battaglia smiles during an ... Stay informed daily on the latest... |
 Disease X-19 from Michael_Novakhov (12 sites) 12m Disease X-19 from Michael_Novakhov (12 sites) 12m |
| Disease X-19 Publications from Michael_Novakhov (5 sites): Google Alert - coronavirus... |
| Elon Musk has made an offer to buy Twitter and take it private, saying he believes it needs to be "transformed."... |
 Disease X-19 from Michael_Novakhov (12 sites) 12m Disease X-19 from Michael_Novakhov (12 sites) 12m |
| Disease X-19 Publications from Michael_Novakhov (5 sites): Google Alert - coronavirus... |
| Search. Please enter a search term. Coronavirus. Pfizer to ask FDA to OK COVID booster for healthy ...... |
 Disease X-19 from Michael_Novakhov (12 sites) 12m Disease X-19 from Michael_Novakhov (12 sites) 12m |
| Disease X-19 Publications from Michael_Novakhov (5 sites): Google Alert - coronavirus... |
| Musk's offer comes after the Tesla and SpaceX CEO became Twitter's largest shareholder. Musk says he... |
 Disease X-19 from Michael_Novakhov (12 sites) 12m Disease X-19 from Michael_Novakhov (12 sites) 12m |
| Disease X-19 Publications from Michael_Novakhov (5 sites): Google Alert - coronavirus... |
| Elon Musk has been a vocal critic of Twitter in recent weeks, ... Much of the rising death toll was caused... |
 Disease X-19 from Michael_Novakhov (12 sites) 12m Disease X-19 from Michael_Novakhov (12 sites) 12m |
| Disease X-19 Publications from Michael_Novakhov (5 sites): Google Alert - coronavirus... |
| Elon Musk offers to buy Twitter, says company needs to be transformed ... Currently, L.A. County requires... |
 Disease X-19 from Michael_Novakhov (12 sites) 12m Disease X-19 from Michael_Novakhov (12 sites) 12m |
 | England's COVID-19 prevalence dips slightly from record high - Reuters UK |
| England's COVID-19 prevalence dips slightly from record high Reuters UK |
 "COVID-19" - Google News 12m "COVID-19" - Google News 12m |
| Coronavirus daily news updates, April 14: What to know today about COVID-19 in the... |
| Coronavirus daily news updates, April 14: What to know today about COVID-19 in the Seattle area, Washington... |
 "coronavirus news" - Google News 19m "coronavirus news" - Google News 19m |
| WHO: COVID cases, deaths in Africa drop to lowest levels yet - News-Gazette.com |
| WHO: COVID cases, deaths in Africa drop to lowest levels yet News-Gazette.com |
 "coronavirus news" - Google News 19m "coronavirus news" - Google News 19m |
| Live Updates | France freezes 33 Russian-owned properties | Coronavirus | news-gazette.com... |
| Live Updates | France freezes 33 Russian-owned properties | Coronavirus | news-gazette.com News-Gazette.com |
 "coronavirus news" - Google News 19m "coronavirus news" - Google News 19m |
| Jim Dey | COVID- numbers way down, but threat remains - News-Gazette.com |
| Jim Dey | COVID- numbers way down, but threat remains News-Gazette.com |
 "coronavirus news" - Google News 19m "coronavirus news" - Google News 19m |
| COVID-related Medicaid coverage extended - for now - for 500,000 Arizonans - Cronkite... |
| COVID-related Medicaid coverage extended - for now - for 500,000 Arizonans Cronkite News |
 "coronavirus news" - Google News 19m "coronavirus news" - Google News 19m |
| COVID cases remain low as new variant emerges in area - News-Press Now |
| COVID cases remain low as new variant emerges in area News-Press Now |
 "coronavirus news" - Google News 19m "coronavirus news" - Google News 19m |
| CDC extends travel mask requirement to May 3 as COVID rises - The Associated Press |
| CDC extends travel mask requirement to May 3 as COVID rises The Associated Press |
 "coronavirus news" - Google News 19m "coronavirus news" - Google News 19m |
| DPH And DOE Encourage Students To Test For COVID-19 Before Returning To School After... |
| DPH And DOE Encourage Students To Test For COVID-19 Before Returning To School After Spring Break - State... |
 "COVID" - Google News 23m "COVID" - Google News 23m |
| Orlando bars lose appeal over COVID-19 shutdown - WKMG News 6 & ClickOrlando |
| Orlando bars lose appeal over COVID-19 shutdown WKMG News 6 & ClickOrlando |
 "COVID" - Google News 23m "COVID" - Google News 23m |
| WHO: COVID cases, deaths in Africa drop to lowest levels yet - FOX 31 Denver |
| WHO: COVID cases, deaths in Africa drop to lowest levels yet FOX 31 Denver |
 "COVID" - Google News 23m "COVID" - Google News 23m |
| Xi Jinping says China must maintain zero tolerance for COVID, even as locked-down... |
| Xi Jinping says China must maintain zero tolerance for COVID, even as locked-down Shanghai residents... |
 "COVID" - Google News 23m "COVID" - Google News 23m |
| SARS-CoV-2 co-infection with influenza viruses, respiratory syncytial virus, or adenoviruses... |
| SARS-CoV-2 co-infection with influenza viruses, respiratory syncytial virus, or adenoviruses The Lancet |
 "Covid-19" - Google News 35m "Covid-19" - Google News 35m |
| Fourth Covid jab found to give strong protection against Omicron variant amid waning... |
| Fourth Covid jab found to give strong protection against Omicron variant amid waning immunity iNews |
 "Omicron" - Google News 38m "Omicron" - Google News 38m |
 | CalciMedica Announces Publication of Results from CARDEA COVID-19 Trial in Critical... |
| CalciMedica Announces Publication of Results from CARDEA COVID-19 Trial in Critical Care PR Newswire |
 "COVID-19" - Google News 42m "COVID-19" - Google News 42m |
 | 50 Marin eighth-graders test positive for COVID-19 after spring break trip to D.C.... |
| 50 Marin eighth-graders test positive for COVID-19 after spring break trip to D.C. The Mercury News |
 "COVID-19" - Google News 42m "COVID-19" - Google News 42m |
 | New COVID-19 vaccine study challenges stereotypes of who is getting the shots - The... |
| New COVID-19 vaccine study challenges stereotypes of who is getting the shots The Boston Globe |
 "COVID-19" - Google News 42m "COVID-19" - Google News 42m |
| WHO: COVID Cases, Deaths in Africa Drop to Lowest Levels Yet - U.S. News & World... |
| WHO: COVID Cases, Deaths in Africa Drop to Lowest Levels Yet U.S. News & World Report |
 "coronavirus news" - Google News 49m "coronavirus news" - Google News 49m |
| Ontario science table to release new COVID-19 modelling today - CP24 Toronto's Breaking... |
| Ontario science table to release new COVID-19 modelling today CP24 Toronto's Breaking News |
 "coronavirus news" - Google News 49m "coronavirus news" - Google News 49m |
| UK plan to fly asylum-seekers to Rwanda draws outrage - Sacramento Bee |
| UK plan to fly asylum-seekers to Rwanda draws outrage Sacramento Bee |
 "covid -19 origins" - Google News 52m "covid -19 origins" - Google News 52m |
| Africa witnesses longest-running decline in COVID-19 cases - World - ReliefWeb |
| Africa witnesses longest-running decline in COVID-19 cases - World ReliefWeb |
 "COVID" - Google News 54m "COVID" - Google News 54m |
| Hong Kong to ease COVID-19 restrictions as infections fall - FOX 31 Denver |
| Hong Kong to ease COVID-19 restrictions as infections fall FOX 31 Denver |
 "COVID" - Google News 54m "COVID" - Google News 54m |
| PA seeing uptick in COVID cases ahead of Easter - WNEP Scranton/Wilkes-Barre |
| PA seeing uptick in COVID cases ahead of Easter WNEP Scranton/Wilkes-Barre |
 "COVID" - Google News 54m "COVID" - Google News 54m |
| Pennsylvania COVID update: Lehigh Valley logs most cases since February, but rate... |
| Pennsylvania COVID update: Lehigh Valley logs most cases since February, but rate still low The Morning... |
 "COVID" - Google News 54m "COVID" - Google News 54m |
| Eldorado Gold flags Omicron hit to quarterly production - MINING.COM - MINING.com |
| Eldorado Gold flags Omicron hit to quarterly production - MINING.COM MINING.com |
 "Omicron" - Google News 1h "Omicron" - Google News 1h |
| British company praised for moving to a four-day week after a trial success - Yahoo... |
| British company praised for moving to a four-day week after a trial success Yahoo New Zealand News |
 "Omicron and rodents" - Google News 1h "Omicron and rodents" - Google News 1h |
| Disease X-19 Epidemiology from Michael_Novakhov (39 sites): Google Alert - coronavirus... |
| The coronavirus pandemic and its ripple effects have snarled supply chains around the world, contributing... |
 Disease X-19 from Michael_Novakhov (12 sites) 1h Disease X-19 from Michael_Novakhov (12 sites) 1h |
| Disease X-19 Epidemiology from Michael_Novakhov (39 sites): Google Alert - coronavirus... |
| A sign warns Colorado River Indian Tribes members to stay home due to COVID-19 in Parker, Ariz., in 2021.... |
 Disease X-19 from Michael_Novakhov (12 sites) 1h Disease X-19 from Michael_Novakhov (12 sites) 1h |
| Disease X-19 Epidemiology from Michael_Novakhov (39 sites): Google Alert - coronavirus... |
| Until the whole world is vaccinated or otherwise has some immunity to the coronavirus, new, more contagious... |
 Disease X-19 from Michael_Novakhov (12 sites) 1h Disease X-19 from Michael_Novakhov (12 sites) 1h |
| Disease X-19 Epidemiology from Michael_Novakhov (39 sites): Google Alert - Covid-19... |
| The new treatment is being advanced to human clinical trials to treat Covid after promising results in... |
 Disease X-19 from Michael_Novakhov (12 sites) 1h Disease X-19 from Michael_Novakhov (12 sites) 1h |
| Disease X-19 Epidemiology from Michael_Novakhov (39 sites): Google Alert - Covid-19... |
| ... clinical trials to treat Covid after promising results in rodents. ... proteins which target "vulnerable... |
 Disease X-19 from Michael_Novakhov (12 sites) 1h Disease X-19 from Michael_Novakhov (12 sites) 1h |
| Disease X-19 Epidemiology from Michael_Novakhov (39 sites): Google Alert - coronavirus... |
| Poorer nations have refused tens of millions of AstraZeneca COVID-19 vaccines from the global programme... |
 Disease X-19 from Michael_Novakhov (12 sites) 1h Disease X-19 from Michael_Novakhov (12 sites) 1h |
| Disease X-19 Epidemiology from Michael_Novakhov (39 sites): Google Alert - coronavirus... |
| British authorities have authorized a coronavirus vaccine for adults made by French drugmaker Valneva.... |
 Disease X-19 from Michael_Novakhov (12 sites) 1h Disease X-19 from Michael_Novakhov (12 sites) 1h |
| Disease X-19 Epidemiology from Michael_Novakhov (39 sites): Google Alert - coronavirus... |
| Three studies from Brazil, Sweden and the UK all found that natural immunity that is boosted by vaccines... |
 Disease X-19 from Michael_Novakhov (12 sites) 1h Disease X-19 from Michael_Novakhov (12 sites) 1h |
| Disease X-19 Epidemiology from Michael_Novakhov (39 sites): Google Alert - coronavirus... |
| Philadelphia's indoor mask mandate was triggered by the city's COVID risk measurement system. ... The... |
 Disease X-19 from Michael_Novakhov (12 sites) 1h Disease X-19 from Michael_Novakhov (12 sites) 1h |
| Disease X-19 Epidemiology from Michael_Novakhov (39 sites): Google Alert - coronavirus... |
| Classic herd immunity, which leads to eradication or elimination of ... It bothers Rodney Russell when... |
 Disease X-19 from Michael_Novakhov (12 sites) 1h Disease X-19 from Michael_Novakhov (12 sites) 1h |
| Porsche sales stumble on supply chain snarls, COVID restrictions - Automotive News... |
| Porsche sales stumble on supply chain snarls, COVID restrictions Automotive News Europe |
 "coronavirus news" - Google News 1h "coronavirus news" - Google News 1h |
| Health department reports rising COVID-19 cases in Erie County - Spectrum News |
| Health department reports rising COVID-19 cases in Erie County Spectrum News |
 "coronavirus news" - Google News 1h "coronavirus news" - Google News 1h |
| Boston Health Commission Urges Safety in Coming Days With COVID Cases Rising - NBC10... |
| Boston Health Commission Urges Safety in Coming Days With COVID Cases Rising NBC10 Boston |
 "COVID" - Google News 1h "COVID" - Google News 1h |
| U.S. FDA delays decision on Regeneron/Roche COVID antibody therapy - Reuters |
| U.S. FDA delays decision on Regeneron/Roche COVID antibody therapy Reuters |
 "COVID" - Google News 1h "COVID" - Google News 1h |
| Low hospitalizations, more treatments temper alarm as COVID cases rise across Northeast... |
| Low hospitalizations, more treatments temper alarm as COVID cases rise across Northeast Healio |
 "COVID" - Google News 1h "COVID" - Google News 1h |
 | Erie County moves from low to medium COVID-19 Community Level following increase... |
| Erie County moves from low to medium COVID-19 Community Level following increase in new cases WKBW 7... |
 "Covid-19" - Google News 1h "Covid-19" - Google News 1h |
| Pfizer and BioNTech Announce Data Demonstrating High Immune Response Following a... |
| submitted by /u/doedalus [link] [comments] |
 COVID-19 1h COVID-19 1h |
| HK detects first Omicron BA.5 infection, adds 1043 Covid cases - Hong Kong Standard |
| HK detects first Omicron BA.5 infection, adds 1043 Covid cases Hong Kong Standard |
 "Omicron" - Google News 1h "Omicron" - Google News 1h |
| Brand Fur Market Maximum Benefit and Growth Potential of Key Players 2028- Dennis... |
| Brand Fur Market Maximum Benefit and Growth Potential of Key Players 2028- Dennis Basso, Vinicio Pajaro,... |
 "Coronavirus in mink" - Google News 1h "Coronavirus in mink" - Google News 1h |
 | 3 tips for doctors on using Evusheld for COVID-19 protection - American Medical Association |
| 3 tips for doctors on using Evusheld for COVID-19 protection American Medical Association |
 "COVID-19" - Google News 1h "COVID-19" - Google News 1h |
 | Covid-19 is here to stay. Should you still try to avoid it? - Inverse |
| Covid-19 is here to stay. Should you still try to avoid it? Inverse |
 "COVID-19" - Google News 1h "COVID-19" - Google News 1h |
 | GW needs to enforce masking to limit COVID-19 cases - GW Hatchet |
| GW needs to enforce masking to limit COVID-19 cases GW Hatchet |
 "COVID-19" - Google News 1h "COVID-19" - Google News 1h |
 | Almost 160 new COVID-19 cases reported in Douglas County in 2 days; test positivity... |
| Almost 160 new COVID-19 cases reported in Douglas County in 2 days; test positivity above 11% The Lawrence... |
 "COVID-19" - Google News 1h "COVID-19" - Google News 1h |
| Tank: Sask. move to COVID weekly reporting is really weakly reporting - Saskatoon... |
| Tank: Sask. move to COVID weekly reporting is really weakly reporting Saskatoon Star-Phoenix |
 "Omicron and rodents" - Google News 1h "Omicron and rodents" - Google News 1h |
| Disease X-19 Regions from Michael_Novakhov (8 sites): Google Alert - coronavirus... |
| 5 things to know for April 14: Subway shooting, Ukraine, Covid, Groceries, South Africa. By Alexandra... |
 Disease X-19 from Michael_Novakhov (12 sites) 1h Disease X-19 from Michael_Novakhov (12 sites) 1h |
| Disease X-19 Regions from Michael_Novakhov (8 sites): Google Alert - coronavirus... |
| 5 things to know for April 14: Subway shooting, Ukraine, Covid, Groceries, South Africa. By Alexandra... |
 Disease X-19 from Michael_Novakhov (12 sites) 1h Disease X-19 from Michael_Novakhov (12 sites) 1h |
| Disease X-19 Regions from Michael_Novakhov (8 sites): Google Alert - coronavirus... |
| News of a provisional compromise to waive intellectual property rights for COVID-19 vaccines between... |
 Disease X-19 from Michael_Novakhov (12 sites) 1h Disease X-19 from Michael_Novakhov (12 sites) 1h |
| Disease X-19 Regions from Michael_Novakhov (8 sites): Google Alert - coronavirus... |
| 1. Subway shooting · 2. Ukraine · 3. Coronavirus · 4. Grocery prices · 5. South Africa floods. Google... |
 Disease X-19 from Michael_Novakhov (12 sites) 1h Disease X-19 from Michael_Novakhov (12 sites) 1h |
| Disease X-19 Regions from Michael_Novakhov (8 sites): Google Alert - coronavirus... |
| South Africans now have until 24 April, rather than this Easter Friday, the 15th, to comment on new health... |
 Disease X-19 from Michael_Novakhov (12 sites) 1h Disease X-19 from Michael_Novakhov (12 sites) 1h |
| Disease X-19 Regions from Michael_Novakhov (8 sites): Google Alert - coronavirus... |
| New York doesn't include self-reported positive at-home tests in its official daily case count. Google... |
 Disease X-19 from Michael_Novakhov (12 sites) 1h Disease X-19 from Michael_Novakhov (12 sites) 1h |
| Disease X-19 Regions from Michael_Novakhov (8 sites): Google Alert - coronavirus... |
| Sign up below to get the latest updates on the coronavirus. ... The health organization said scientists... |
 Disease X-19 from Michael_Novakhov (12 sites) 1h Disease X-19 from Michael_Novakhov (12 sites) 1h |
| Disease X-19 Regions from Michael_Novakhov (8 sites): Google Alert - coronavirus... |
| JOHANNESBURG (AP) — Migrants in South Africa are living in fear of attacks and ... CDC extends travel... |
 Disease X-19 from Michael_Novakhov (12 sites) 1h Disease X-19 from Michael_Novakhov (12 sites) 1h |
| Covid levels starting to fall in UK, says ONS - BBC |
| Covid levels starting to fall in UK, says ONS BBC |
 "coronavirus news" - Google News 1h "coronavirus news" - Google News 1h |
| Fosun Diagnostics Receives China NMPA Approval for Its Independently Developed Novel... |
| Fosun Diagnostics Receives China NMPA Approval for Its Independently Developed Novel Coronavirus Antigen... |
 "coronavirus news" - Google News 1h "coronavirus news" - Google News 1h |
| End is near for UW COVID-19 testing | Coronavirus | wyomingnews.com - Wyoming Tribune |
| End is near for UW COVID-19 testing | Coronavirus | wyomingnews.com Wyoming Tribune |
 "coronavirus news" - Google News 1h "coronavirus news" - Google News 1h |
| Coronavirus: L.A. County reported 973 new cases and 11 more deaths, April 13 - The... |
| Coronavirus: L.A. County reported 973 new cases and 11 more deaths, April 13 The Pasadena Star-News |
 "coronavirus news" - Google News 1h "coronavirus news" - Google News 1h |
| Chinese EV maker Nio says it's gradually resuming production after Covid halt - CNBC |
| Chinese EV maker Nio says it's gradually resuming production after Covid halt CNBC |
 "COVID" - Google News 1h "COVID" - Google News 1h |
| Wizz Air to beat expectations despite Omicron and Ukraine war - The Independent |
| Wizz Air to beat expectations despite Omicron and Ukraine war The Independent |
 "Omicron" - Google News 2h "Omicron" - Google News 2h |
| What do we know about two new versions of Omicron variant spreading in New York -... |
| What do we know about two new versions of Omicron variant spreading in New York Yahoo News |
 "Omicron" - Google News 2h "Omicron" - Google News 2h |
| Omicron Symptoms 2 Days Shorter Than Delta - WebMD |
| Omicron Symptoms 2 Days Shorter Than Delta WebMD |
 "Omicron" - Google News 2h "Omicron" - Google News 2h |
| New nasal spray to protect people from all Covid variants to start human trials -... |
| New nasal spray to protect people from all Covid variants to start human trials Cambridgeshire Live |
 "Omicron and rodents" - Google News 2h "Omicron and rodents" - Google News 2h |
| Disease X-19 Publications from Michael_Novakhov (5 sites): Google Alert - new york... |
| New York State has become a new COVID-19 epicenter because of two new versions of the omicron variant,... |
 Disease X-19 from Michael_Novakhov (12 sites) 2h Disease X-19 from Michael_Novakhov (12 sites) 2h |
| Disease X-19 Publications from Michael_Novakhov (5 sites): Google Alert - coronavirus... |
| The New York Times and New York Post, each citing law enforcement sources, reported that James himself... |
 Disease X-19 from Michael_Novakhov (12 sites) 2h Disease X-19 from Michael_Novakhov (12 sites) 2h |
| Disease X-19 Publications from Michael_Novakhov (5 sites): Google Alert - new york... |
| (The New York Times/Brittainy Newman). WASHINGTON -- The Biden administration ... Sign up below to get... |
 Disease X-19 from Michael_Novakhov (12 sites) 2h Disease X-19 from Michael_Novakhov (12 sites) 2h |
| Disease X-19 and Security from Michael_Novakhov (10 sites): Google Alert - coronavirus... |
| WHO: COVID cases and deaths fall for 3rd consecutive … 2 sought in Middleborough school ... Coronavirus:... |
 Disease X-19 from Michael_Novakhov (12 sites) 2h Disease X-19 from Michael_Novakhov (12 sites) 2h |
| Disease X-19 as the Bio-weapon from Michael_Novakhov (3 sites): Google Alert - sars... |
| In the video, Dr. Bryan Ardis unveiled a shocking connection between this pandemic and the eternal battle... |
 Disease X-19 from Michael_Novakhov (12 sites) 2h Disease X-19 from Michael_Novakhov (12 sites) 2h |
| Disease X-19 Publications from Michael_Novakhov (5 sites): Google Alert - coronavirus... |
| Barry Manilow is the latest star to contract COVID-19. ... In summer 2020, The New York Times coordinated... |
 Disease X-19 from Michael_Novakhov (12 sites) 2h Disease X-19 from Michael_Novakhov (12 sites) 2h |
| Disease X-19 and Security from Michael_Novakhov (10 sites): Google Alert - coronavirus... |
| Investigators said the suspects they identified were associated with the protest movement against coronavirus... |
 Disease X-19 from Michael_Novakhov (12 sites) 2h Disease X-19 from Michael_Novakhov (12 sites) 2h |
| Disease X-19 Publications from Michael_Novakhov (5 sites): Google Alert - coronavirus... |
| Trump told The Washington Post that he had offered his daughter and son-in-law ... This article originally... |
 Disease X-19 from Michael_Novakhov (12 sites) 2h Disease X-19 from Michael_Novakhov (12 sites) 2h |
| Disease X-19 and Security from Michael_Novakhov (10 sites): Google Alert - Coronavirus... |
| Russia is likely to deploy a range of cyber weapons on the United States and its election systems during... |
 Disease X-19 from Michael_Novakhov (12 sites) 2h Disease X-19 from Michael_Novakhov (12 sites) 2h |
| Covid levels rising in New Orleans wastewater. Experts say that is ‘definitely... |
| Covid levels rising in New Orleans wastewater. Experts say that is 'definitely concerning' NOLA.com |
 "COVID" - Google News 2h "COVID" - Google News 2h |
| China's Covid Deaths Data Questioned as Tally Lags Other Nations - Bloomberg |
| China's Covid Deaths Data Questioned as Tally Lags Other Nations Bloomberg |
 "COVID" - Google News 2h "COVID" - Google News 2h |
 | Africa Covid-19 New Infections at Lowest Since April 2020 - Bloomberg |
| Africa Covid-19 New Infections at Lowest Since April 2020 Bloomberg |
 "Covid-19" - Google News 2h "Covid-19" - Google News 2h |
| COVID vaccine that could protect against Omicron and other variants - Drug Target... |
| COVID vaccine that could protect against Omicron and other variants Drug Target Review |
 "Omicron" - Google News 2h "Omicron" - Google News 2h |
 | Mask mandates return across the country amid increase in COVID-19 cases - The Daily... |
| Mask mandates return across the country amid increase in COVID-19 cases The Daily Pennsylvanian |
 "COVID-19" - Google News 2h "COVID-19" - Google News 2h |
| New nasal spray which could protect against ALL Covid variants on trial run - The... |
| New nasal spray which could protect against ALL Covid variants on trial run The Mirror |
 "Omicron and rodents" - Google News 2h "Omicron and rodents" - Google News 2h |
| New nasal spray to protect people from all Covid variants to start human trials -... |
| New nasal spray to protect people from all Covid variants to start human trials Wales Online |
 "Omicron and rodents" - Google News 2h "Omicron and rodents" - Google News 2h |
| Disease X-19 Epidemiology from Michael_Novakhov (39 sites): Google Alert - coronavirus... |
| What should you do if you take a coronavirus test, and it's positive? ... Bebtelovimab is a monoclonal... |
 Disease X-19 from Michael_Novakhov (12 sites) 2h Disease X-19 from Michael_Novakhov (12 sites) 2h |
| Disease X-19 Epidemiology from Michael_Novakhov (39 sites): Google Alert - coronavirus... |
| Confirmed or suspected coronavirus deaths in Scotland fell by 33 to 139 in the week to Sunday, according... |
 Disease X-19 from Michael_Novakhov (12 sites) 2h Disease X-19 from Michael_Novakhov (12 sites) 2h |
| Disease X-19 Epidemiology from Michael_Novakhov (39 sites): Google Alert - coronavirus... |
| ... something that is not always done in Orthodox communities. ... the model Naomi Campbell, a longtime... |
 Disease X-19 from Michael_Novakhov (12 sites) 2h Disease X-19 from Michael_Novakhov (12 sites) 2h |
| Disease X-19 Epidemiology from Michael_Novakhov (39 sites): Google Alert - coronavirus... |
| In "CORONAVIRUS". Share: Rate: 1 2 3 4 5. PreviousFort Defiance native scheduled for May 11 execution... |
 Disease X-19 from Michael_Novakhov (12 sites) 2h Disease X-19 from Michael_Novakhov (12 sites) 2h |
| Disease X-19 Epidemiology from Michael_Novakhov (39 sites): Google Alert - coronavirus... |
| No one has died of COVID-19 in Cuyahoga County in the past three weeks. That is just one piece of good... |
 Disease X-19 from Michael_Novakhov (12 sites) 2h Disease X-19 from Michael_Novakhov (12 sites) 2h |
| Disease X-19 Epidemiology from Michael_Novakhov (39 sites): Google Alert - coronavirus... |
| Sewerage and Water Board Carollton plant. The Sewerage and Water Board's Carrollton plant in New Orleans... |
 Disease X-19 from Michael_Novakhov (12 sites) 2h Disease X-19 from Michael_Novakhov (12 sites) 2h |
| UK clears 6th COVID shot despite canceling deal for doses - ABC News |
| UK clears 6th COVID shot despite canceling deal for doses ABC News |
 "coronavirus news" - Google News 2h "coronavirus news" - Google News 2h |
| Worldwide COVID cases surpass 500 mln as Omicron variant BA.2 surges - Reuters |
| Worldwide COVID cases surpass 500 mln as Omicron variant BA.2 surges Reuters |
 "COVID" - Google News 2h "COVID" - Google News 2h |
| Poorer nations shun AstraZeneca COVID vaccine - document - Reuters |
| Poorer nations shun AstraZeneca COVID vaccine - document Reuters |
 "COVID" - Google News 2h "COVID" - Google News 2h |
| Should I get a second booster shot to protect against COVID? - NJ.com |
| Should I get a second booster shot to protect against COVID? NJ.com |
 "COVID" - Google News 2h "COVID" - Google News 2h |
| Hong Kong to Ease COVID-19 Restrictions as Infections Fall - U.S. News & World Report |
| Hong Kong to Ease COVID-19 Restrictions as Infections Fall U.S. News & World Report |
 "COVID" - Google News 2h "COVID" - Google News 2h |
| COVID-19, Ukraine & Other Global Health Issues Virtual Press conference transcript... |
| COVID-19, Ukraine & Other Global Health Issues Virtual Press conference transcript - 13 April 2022 World... |
 "Covid-19" - Google News 3h "Covid-19" - Google News 3h |
| Covid-19 booster raises antibody levels against Omicron for children ages 5 through... |
| Covid-19 booster raises antibody levels against Omicron for children ages 5 through 11, Pfizer and BioNTech... |
 "Omicron" - Google News 3h "Omicron" - Google News 3h |
| Coronavirus tally: Two new versions of omicron variant are spreading fast in New... |
| Coronavirus tally: Two new versions of omicron variant are spreading fast in New York, state officials... |
 "Omicron" - Google News 3h "Omicron" - Google News 3h |
| Worldwide COVID Cases Surpass 500 Million as Omicron Variant BA.2 Surges - U.S. News... |
| Worldwide COVID Cases Surpass 500 Million as Omicron Variant BA.2 Surges U.S. News & World Report |
 "Omicron" - Google News 3h "Omicron" - Google News 3h |
| Off the News: Isles' weekly COVID stats show spread - Honolulu Star-Advertiser |
| Off the News: Isles' weekly COVID stats show spread Honolulu Star-Advertiser |
 "coronavirus news" - Google News 3h "coronavirus news" - Google News 3h |
| The preclinical potential of S. miltiorrhiza extracts for the treatment of COVID-19... |
| The preclinical potential of S. miltiorrhiza extracts for the treatment of COVID-19 News-Medical.Net |
 "coronavirus news" - Google News 3h "coronavirus news" - Google News 3h |
| Ukraine says it damaged Russian flagship, crew evacuates - News-Gazette.com |
| Ukraine says it damaged Russian flagship, crew evacuates News-Gazette.com |
 "coronavirus news" - Google News 3h "coronavirus news" - Google News 3h |
| Disease X-19 Symptoms from Michael_Novakhov (16 sites): Google Alert - gastrointestinal... |
| India logged 1007 new coronavirus infections, taking the total tally of COVID-19 cases ... which could... |
 Disease X-19 from Michael_Novakhov (12 sites) 3h Disease X-19 from Michael_Novakhov (12 sites) 3h |
| Disease X-19 Regions from Michael_Novakhov (8 sites): Google Alert - coronavirus... |
| An International Olympic Committee member from Israel who also previously served as a senior vice president... |
 Disease X-19 from Michael_Novakhov (12 sites) 3h Disease X-19 from Michael_Novakhov (12 sites) 3h |
| Disease X-19 Regions from Michael_Novakhov (8 sites): Google Alert - coronavirus... |
| Omicron XE, a new coronavirus mashup of the omicron BA.2 subvariant and the original BA.1 omicron strain,... |
 Disease X-19 from Michael_Novakhov (12 sites) 3h Disease X-19 from Michael_Novakhov (12 sites) 3h |
| Disease X-19 Regions from Michael_Novakhov (8 sites): Google Alert - coronavirus... |
| DUBAI – The killing of all American leaders would not be enough to avenge the U.S. assassination of Iran's... |
 Disease X-19 from Michael_Novakhov (12 sites) 3h Disease X-19 from Michael_Novakhov (12 sites) 3h |
| Disease X-19 Regions from Michael_Novakhov (8 sites): Google Alert - coronavirus... |
| Israelis over the age of 60 who have gotten vaccinated against the coronavirus with four doses are 64%... |
 Disease X-19 from Michael_Novakhov (12 sites) 3h Disease X-19 from Michael_Novakhov (12 sites) 3h |
| Disease X-19 Regions from Michael_Novakhov (8 sites): Google Alert - coronavirus... |
| Iran is starting to operate a new workshop at Natanz that will make parts for ... amid the coronavirus... |
 Disease X-19 from Michael_Novakhov (12 sites) 3h Disease X-19 from Michael_Novakhov (12 sites) 3h |
| Disease X-19 Regions from Michael_Novakhov (8 sites): Google Alert - coronavirus... |
| UNCOVER ISRAEL - Get the ISRAEL21c. Weekly Edition free by email · Sign Up Now! Viruses like Covid-19... |
 Disease X-19 from Michael_Novakhov (12 sites) 3h Disease X-19 from Michael_Novakhov (12 sites) 3h |
| Disease X-19 Regions from Michael_Novakhov (8 sites): Google Alert - Coronavirus... |
| WASHINGTON D.C. — Many of us are using those at-home rapid COVID-19 tests more often, especially as new... |
 Disease X-19 from Michael_Novakhov (12 sites) 3h Disease X-19 from Michael_Novakhov (12 sites) 3h |
| NY's true COVID infection rate unclear as many at-home tests go unreported. What... |
| NY's true COVID infection rate unclear as many at-home tests go unreported. What to know The Journal... |
 "COVID" - Google News 3h "COVID" - Google News 3h |
| China's GDP growth seen slowing to 5.0% in 2022 on COVID hit - Reuters |
| China's GDP growth seen slowing to 5.0% in 2022 on COVID hit Reuters |
 "COVID" - Google News 3h "COVID" - Google News 3h |
| Wood County resident among new COVID deaths | News, Sports, Jobs - Parkersburg News |
| Wood County resident among new COVID deaths | News, Sports, Jobs Parkersburg News |
 "COVID" - Google News 3h "COVID" - Google News 3h |
| Covid Prevents Barry Manilow From Attending Opening Night Of His New Musical 'Harmony':... |
| Covid Prevents Barry Manilow From Attending Opening Night Of His New Musical 'Harmony': "Cruelest Thing... |
 "COVID" - Google News 3h "COVID" - Google News 3h |
| Michigan reports 7,725 new COVID cases, 81 deaths over past week - WDIV ClickOnDetroit |
| Michigan reports 7,725 new COVID cases, 81 deaths over past week WDIV ClickOnDetroit |
 "COVID" - Google News 3h "COVID" - Google News 3h |
 | Got a positive COVID-19 test? New treatments can help keep you out of the hospital... |
| Got a positive COVID-19 test? New treatments can help keep you out of the hospital Detroit Free Press |
 "Covid-19" - Google News 3h "Covid-19" - Google News 3h |
 | Embry Health closes 60 COVID-19 test sites across Arizona, citing lack of funds -... |
| Embry Health closes 60 COVID-19 test sites across Arizona, citing lack of funds The Arizona Republic |
 "Covid-19" - Google News 3h "Covid-19" - Google News 3h |
| Wisconsin farms, GOP push back on mink industry ban - Wisconsin Public Radio |
| Wisconsin farms, GOP push back on mink industry ban Wisconsin Public Radio |
 "Coronavirus in mink" - Google News 3h "Coronavirus in mink" - Google News 3h |
| UK clears 6th COVID shot despite canceling deal for doses - Verve Times |
| UK clears 6th COVID shot despite canceling deal for doses Verve Times |
 "Coronavirus in meat plants" - Google News 3h "Coronavirus in meat plants" - Google News 3h |
| High cholesterol: Plant-sterol yoghurt could slash your levels by 10% – 'Great' -... |
| High cholesterol: Plant-sterol yoghurt could slash your levels by 10% – 'Great' Verve Times |
 "Coronavirus in meat plants" - Google News 3h "Coronavirus in meat plants" - Google News 3h |
| Disease X-19 Epidemiology from Michael_Novakhov (39 sites): Google Alert - coronavirus... |
| What we know (and don't know) about at-home COVID tests in NY ... 19.5 million tests to nursing homes... |
 Disease X-19 from Michael_Novakhov (12 sites) 3h Disease X-19 from Michael_Novakhov (12 sites) 3h |
| Disease X-19 Epidemiology from Michael_Novakhov (39 sites): Google Alert - coronavirus... |
| I would like to receive relevant information via email from McKnight's Long-Term Care . By registering... |
 Disease X-19 from Michael_Novakhov (12 sites) 3h Disease X-19 from Michael_Novakhov (12 sites) 3h |
| Disease X-19 Epidemiology from Michael_Novakhov (39 sites): Google Alert - coronavirus... |
| But the program was suspended in 2020 at the onset of the coronavirus pandemic, which shuttered the library... |
 Disease X-19 from Michael_Novakhov (12 sites) 3h Disease X-19 from Michael_Novakhov (12 sites) 3h |
| Disease X-19 Epidemiology from Michael_Novakhov (39 sites): Google Alert - coronavirus... |
| ... their respective new years with colorful processions and musical soirees as the coronavirus pandemic... |
 Disease X-19 from Michael_Novakhov (12 sites) 3h Disease X-19 from Michael_Novakhov (12 sites) 3h |
| Disease X-19 Epidemiology from Michael_Novakhov (39 sites): Google Alert - coronavirus... |
| Transdermal delivery systems for anti-severe acute respiratory syndrome coronavirus 2 (anti-SARS-CoV-2)... |
 Disease X-19 from Michael_Novakhov (12 sites) 3h Disease X-19 from Michael_Novakhov (12 sites) 3h |
| Disease X-19 Regions from Michael_Novakhov (8 sites): Google Alert - coronavirus... |
| Civic organisation, Dear South Africa, says government should not rush to implement permanent laws addressing... |
 Disease X-19 from Michael_Novakhov (12 sites) 3h Disease X-19 from Michael_Novakhov (12 sites) 3h |
| Disease X-19 Epidemiology from Michael_Novakhov (39 sites): Google Alert - coronavirus... |
| Will dietary supplements become the new weapon against Covid-19? ... supplement could enhance immunity... |
 Disease X-19 from Michael_Novakhov (12 sites) 3h Disease X-19 from Michael_Novakhov (12 sites) 3h |
| Disease X-19 Epidemiology from Michael_Novakhov (39 sites): Google Alert - coronavirus... |
| On Wednesday, April 13, the pharma giant's CEO Albert Bourla spoke of the new vaccine against the Omicron... |
 Disease X-19 from Michael_Novakhov (12 sites) 3h Disease X-19 from Michael_Novakhov (12 sites) 3h |
| Disease X-19 Epidemiology from Michael_Novakhov (39 sites): Google Alert - Coronavirus... |
| Understand the influence of the Animal And Pet Food Flavors Market with detailed analysis is provided... |
 Disease X-19 from Michael_Novakhov (12 sites) 3h Disease X-19 from Michael_Novakhov (12 sites) 3h |
| Disease X-19 Epidemiology from Michael_Novakhov (39 sites): Google Alert - covid-19... |
| Nebraska is home to facilities run by JBS, Tyson, Smithfield, and Costco and to large ... that have been... |
 Disease X-19 from Michael_Novakhov (12 sites) 3h Disease X-19 from Michael_Novakhov (12 sites) 3h |
| Disease X-19 Epidemiology from Michael_Novakhov (39 sites): Google Alert - covid-19... |
| On Wednesday, April 13, the pharma giant's CEO Albert Bourla spoke of the new vaccine against the Omicron... |
 Disease X-19 from Michael_Novakhov (12 sites) 3h Disease X-19 from Michael_Novakhov (12 sites) 3h |
| Disease X-19 Publications from Michael_Novakhov (5 sites): Google Alert - covid-19... |
| ... positive for COVID-19... just HOURS before the opening night of his musical Harmony in New York City.... |
 Disease X-19 from Michael_Novakhov (12 sites) 3h Disease X-19 from Michael_Novakhov (12 sites) 3h |
| Disease X-19 Regions from Michael_Novakhov (8 sites): Google Alert - coronavirus... |
| Speranza said 90 percent of the Italian population aged over 12 have now had at least the first two doses... |
 Disease X-19 from Michael_Novakhov (12 sites) 3h Disease X-19 from Michael_Novakhov (12 sites) 3h |
| Disease X-19 and Security from Michael_Novakhov (10 sites): Google Alert - Coronavirus... |
| US must lend a hand in prosecuting Russian war crimes. A bipartisan effort to clear ... How to achieve... |
 Disease X-19 from Michael_Novakhov (12 sites) 3h Disease X-19 from Michael_Novakhov (12 sites) 3h |
| Disease X-19 Publications from Michael_Novakhov (5 sites): Google Alert - coronavirus... |
| Los Angeles Dodgers ace Clayton Kershaw made his first start of the season Wednesday and was working... |
 Disease X-19 from Michael_Novakhov (12 sites) 3h Disease X-19 from Michael_Novakhov (12 sites) 3h |
| Disease X-19 Regions from Michael_Novakhov (8 sites): Google Alert - coronavirus... |
| The WHO combined 151 studies published on Covid-19 antibody rates across Africa in the period under review.... |
 Disease X-19 from Michael_Novakhov (12 sites) 3h Disease X-19 from Michael_Novakhov (12 sites) 3h |
| Disease X-19 and Security from Michael_Novakhov (10 sites): Google Alert - Coronavirus... |
| The military package, according to the Pentagon, aims to provide Ukraine with weapons that would 'give... |
 Disease X-19 from Michael_Novakhov (12 sites) 3h Disease X-19 from Michael_Novakhov (12 sites) 3h |
| Disease X-19 Regions from Michael_Novakhov (8 sites): Google Alert - coronavirus... |
| Vaccines have roughly halved COVID-19 deaths in Italy, its National Health Institute estimates. ASIA-PACIFIC.... |
 Disease X-19 from Michael_Novakhov (12 sites) 3h Disease X-19 from Michael_Novakhov (12 sites) 3h |
| Nanoparticles Could Enable a More Sensitive and Durable Rapid COVID-19 Test - Technology... |
| Nanoparticles Could Enable a More Sensitive and Durable Rapid COVID-19 Test Technology Networks |
 "COVID" - Google News 3h "COVID" - Google News 3h |
| They lost loved ones to COVID. Can their suits overcome state immunity for nursing... |
| They lost loved ones to COVID. Can their suits overcome state immunity for nursing homes? NorthJersey.com |
 "COVID" - Google News 3h "COVID" - Google News 3h |
 | Covid-19 Live Updates: China, Omicron and Vaccine News - The New York Times |
| Covid-19 Live Updates: China, Omicron and Vaccine News The New York Times |
 "Covid-19" - Google News 3h "Covid-19" - Google News 3h |
 | Study finds dexamethasone and remdesivir treatment in hospitalized COVID-19 patients... |
| Study finds dexamethasone and remdesivir treatment in hospitalized COVID-19 patients is associated with... |
 "Covid-19" - Google News 3h "Covid-19" - Google News 3h |
| Latah County ends COVID-19 emergency | Local | dnews.com - Moscow-Pullman Daily News |
| Latah County ends COVID-19 emergency | Local | dnews.com Moscow-Pullman Daily News |
 "COVID-19" - Google News 4h "COVID-19" - Google News 4h |
| Warren County man heads home after 7-month battle with COVID-19 - Local 5 - weareiowa.com |
| Warren County man heads home after 7-month battle with COVID-19 Local 5 - weareiowa.com |
 "COVID-19" - Google News 4h "COVID-19" - Google News 4h |
| Covid Live News and Updates - The New York Times |
| Covid Live News and Updates The New York Times |
 "coronavirus news" - Google News 4h "coronavirus news" - Google News 4h |
| How the pandemic altered the relationship between Philly restaurants and diners -... |
| How the pandemic altered the relationship between Philly restaurants and diners The Philadelphia Inquirer |
 "Coronavirus in fish and seafood" - Google News 4h "Coronavirus in fish and seafood" - Google News 4h |
| [Exclusive] Korea sequenced less than 0.1% of cases over omicron outbreak - The Korea... |
| [Exclusive] Korea sequenced less than 0.1% of cases over omicron outbreak The Korea Herald |
 "Omicron" - Google News 4h "Omicron" - Google News 4h |
 | COVID-19 activity remains low in Spokane County, with case backlog affecting numbers... |
| COVID-19 activity remains low in Spokane County, with case backlog affecting numbers The Spokesman Review |
 "COVID-19" - Google News 4h "COVID-19" - Google News 4h |
| COVID-19 vaccines will not be required for entry in Washington schools - wenatcheeworld.com |
| COVID-19 vaccines will not be required for entry in Washington schools wenatcheeworld.com |
 "COVID-19" - Google News 4h "COVID-19" - Google News 4h |
 | Churches overcome pandemic grief, welcome Easter renewal - GoErie.com |
| Churches overcome pandemic grief, welcome Easter renewal GoErie.com |
 "COVID-19" - Google News 4h "COVID-19" - Google News 4h |
| All NETN counties now have 'moderate' or 'low' COVID-19 community spread - WJHL-TV... |
| All NETN counties now have 'moderate' or 'low' COVID-19 community spread WJHL-TV News Channel 11 |
 "COVID-19" - Google News 4h "COVID-19" - Google News 4h |
| Celebrate May Morning with public art Crowdfunder - Oxford City Council News |
| Celebrate May Morning with public art Crowdfunder Oxford City Council News |
 "covid -19 origins" - Google News 4h "covid -19 origins" - Google News 4h |
 | Novel transdermal vaccine delivery for COVID-19 and cancer - News-Medical.Net |
| Novel transdermal vaccine delivery for COVID-19 and cancer News-Medical.Net |
 "Covid-19" - Google News 4h "Covid-19" - Google News 4h |
| Driven by Spike Among Grad Students, Harvard On-Campus Covid Cases Rise | News -... |
| Driven by Spike Among Grad Students, Harvard On-Campus Covid Cases Rise | News Harvard Crimson |
 "COVID" - Google News 5h "COVID" - Google News 5h |
| CDC extends mask mandate on public transportation until May as COVID cases rise -... |
| CDC extends mask mandate on public transportation until May as COVID cases rise Western Massachusetts... |
 "COVID" - Google News 5h "COVID" - Google News 5h |
| 'This just might kill me': Residents at East Tampa apartment complex live in black... |
| 'This just might kill me': Residents at East Tampa apartment complex live in black mold and rodent 'nightmare' Creative... |
 "aggressive rats in new york city" - Google News 5h "aggressive rats in new york city" - Google News 5h |
| What's Going Around: Flu, COVID-19, stomach bug - ABC27 |
| What's Going Around: Flu, COVID-19, stomach bug ABC27 |
 "COVID-19" - Google News 5h "COVID-19" - Google News 5h |
| COVID-19 (Coronavirus) statistics - News - NSW Health |
| COVID-19 (Coronavirus) statistics - News NSW Health |
 "coronavirus news" - Google News 5h "coronavirus news" - Google News 5h |
| Disease X-19 General Issues from Michael_Novakhov (5 sites): Google Alert - sars... |
| The tests use antibodies against SARS-CoV-2 for detection, which can't withstand wide ranges of temperature... |
 Disease X-19 from Michael_Novakhov (12 sites) 5h Disease X-19 from Michael_Novakhov (12 sites) 5h |
| Disease X-19 General Issues from Michael_Novakhov (5 sites): Google Alert - coronavirus:... |
| Virus control measures must be strictly implemented" in strict adherence to science, President Xi Jinping... |
 Disease X-19 from Michael_Novakhov (12 sites) 5h Disease X-19 from Michael_Novakhov (12 sites) 5h |
| Disease X-19 Epidemiology from Michael_Novakhov (39 sites): Google Alert - coronavirus... |
| Range of accusations against Bat Sheva Marcus, sex therapist and former board chair of the Jewish Orthodox... |
 Disease X-19 from Michael_Novakhov (12 sites) 5h Disease X-19 from Michael_Novakhov (12 sites) 5h |
| Disease X-19 Epidemiology from Michael_Novakhov (39 sites): Google Alert - coronavirus... |
| ... has a large Orthodox Jewish population — Zangari said that the display ... and the menorah there... |
 Disease X-19 from Michael_Novakhov (12 sites) 5h Disease X-19 from Michael_Novakhov (12 sites) 5h |
| Disease X-19 General Issues from Michael_Novakhov (5 sites): Google Alert - Latest... |
| The Michigan Department of Health and Human Services reported 7725 newly confirmed COVID-19 cases from... |
 Disease X-19 from Michael_Novakhov (12 sites) 5h Disease X-19 from Michael_Novakhov (12 sites) 5h |
| Disease X-19 General Issues from Michael_Novakhov (5 sites): Google Alert - sars... |
| The tests use antibodies against SARS-CoV-2 for detection, which can't withstand wide ranges of temperature... |
 Disease X-19 from Michael_Novakhov (12 sites) 5h Disease X-19 from Michael_Novakhov (12 sites) 5h |
| Disease X-19 Publications from Michael_Novakhov (5 sites): Google Alert - coronavirus... |
| Prince Albert diagnosed with COVID-19 · More from this section · (0) comments · Welcome to the discussion.... |
 Disease X-19 from Michael_Novakhov (12 sites) 5h Disease X-19 from Michael_Novakhov (12 sites) 5h |
| Disease X-19 Epidemiology from Michael_Novakhov (39 sites): Google Alert - Coronavirus... |
| They also suggested upcoming Easter and Passover celebrations be moved outdoors to reduce infection risk.... |
 Disease X-19 from Michael_Novakhov (12 sites) 5h Disease X-19 from Michael_Novakhov (12 sites) 5h |
| Disease X-19 Epidemiology from Michael_Novakhov (39 sites): Google Alert - coronavirus... |
| It is the sixth Covid-19 vaccine to be granted an MHRA authorisation. It came as the number of deaths... |
 Disease X-19 from Michael_Novakhov (12 sites) 5h Disease X-19 from Michael_Novakhov (12 sites) 5h |
| Disease X-19 Publications from Michael_Novakhov (5 sites): Google Alert - coronavirus... |
| Today, it is over 5,000, according to the New York Times. The total number of new positive cases today,... |
 Disease X-19 from Michael_Novakhov (12 sites) 5h Disease X-19 from Michael_Novakhov (12 sites) 5h |
| Disease X-19 Publications from Michael_Novakhov (5 sites): Google Alert - covid-19... |
| Victorian Premier Daniel Andrews has flagged major changes to the state's vaccine mandate. Andrews says... |
 Disease X-19 from Michael_Novakhov (12 sites) 5h Disease X-19 from Michael_Novakhov (12 sites) 5h |
| Disease X-19 General Issues from Michael_Novakhov (5 sites): Google Alert - sars... |
| CE mark for Eurobio Scientific's new proprietary test for the detection of Omicron BA.x, BA.2 and Delta... |
 Disease X-19 from Michael_Novakhov (12 sites) 5h Disease X-19 from Michael_Novakhov (12 sites) 5h |
| Uniqlo owner sees big profit drop in China due to COVID restrictions - Reuters |
| Uniqlo owner sees big profit drop in China due to COVID restrictions Reuters |
 "COVID" - Google News 5h "COVID" - Google News 5h |
| Watching Shanghai's covid lockdown from my quarantine hotel as a journalist in China... |
| Watching Shanghai's covid lockdown from my quarantine hotel as a journalist in China The Washington... |
 "COVID" - Google News 5h "COVID" - Google News 5h |
| Hong Kong confirms it will ease COVID restrictions from April 21 - Reuters |
| Hong Kong confirms it will ease COVID restrictions from April 21 Reuters |
 "COVID" - Google News 5h "COVID" - Google News 5h |
 | Hong Kong to ease COVID-19 restrictions as infections fall - WSLS 10 |
| Hong Kong to ease COVID-19 restrictions as infections fall WSLS 10 |
 "COVID-19" - Google News 5h "COVID-19" - Google News 5h |
| COVID-19: Valneva vaccine granted regulatory approval by the MHRA - Sky News |
| COVID-19: Valneva vaccine granted regulatory approval by the MHRA Sky News |
 "coronavirus news" - Google News 5h "coronavirus news" - Google News 5h |
| Disease X-19 and Security from Michael_Novakhov (10 sites): Google Alert - Coronavirus... |
| President Joe Biden announced $800 million in additional U.S. military aid for Ukraine and the European... |
 Disease X-19 from Michael_Novakhov (12 sites) 5h Disease X-19 from Michael_Novakhov (12 sites) 5h |
| Disease X-19 and Security from Michael_Novakhov (10 sites): Google Alert - Coronavirus... |
| Helicopters, howitzers: Details of $800 million US military aid for Ukraine · Visual Stories · PLAY EXCITING... |
 Disease X-19 from Michael_Novakhov (12 sites) 5h Disease X-19 from Michael_Novakhov (12 sites) 5h |
| Disease X-19 Regions from Michael_Novakhov (8 sites): Google Alert - coronavirus... |
| East and Horn of Africa prep for worst drought in decades ... WHO: COVID cases and deaths fall for 3rd... |
 Disease X-19 from Michael_Novakhov (12 sites) 5h Disease X-19 from Michael_Novakhov (12 sites) 5h |
| Covid cases among Washington power brokers put new focus on White House's protocols... |
| Covid cases among Washington power brokers put new focus on White House's protocols for Biden CNN |
 "COVID" - Google News 6h "COVID" - Google News 6h |
 | Hong Kong to ease COVID-19 restrictions as infections fall - ABC News |
| Hong Kong to ease COVID-19 restrictions as infections fall ABC News |
 "COVID-19" - Google News 6h "COVID-19" - Google News 6h |
| House Green Lights Extension of COVID-19 Laws - CT News Junkie |
| House Green Lights Extension of COVID-19 Laws CT News Junkie |
 "coronavirus news" - Google News 6h "coronavirus news" - Google News 6h |
| Disease X-19 Epidemiology from Michael_Novakhov (39 sites): Google Alert - Coronavirus... |
| State-controlled outlets describe a successful campaign to provide food and other supplies and counseled... |
 Disease X-19 from Michael_Novakhov (12 sites) 6h Disease X-19 from Michael_Novakhov (12 sites) 6h |
| Disease X-19 Epidemiology from Michael_Novakhov (39 sites): Google Alert - Covid-19:... |
| Due to current high levels of community spread of COVID-19 in the Central Florida region, visitation... |
 Disease X-19 from Michael_Novakhov (12 sites) 6h Disease X-19 from Michael_Novakhov (12 sites) 6h |
| Disease X-19 Epidemiology from Michael_Novakhov (39 sites): Google Alert - Coronavirus,... |
| Tuesday's morning-rush-hour attack at a Brooklyn subway station marks the 41st mass shooting in New York... |
 Disease X-19 from Michael_Novakhov (12 sites) 6h Disease X-19 from Michael_Novakhov (12 sites) 6h |
| Disease X-19 Epidemiology from Michael_Novakhov (39 sites): Google Alert - Sars-Cov-2... |
| Compared to last week: Feeder steers and heifers sold 2.00-5.00 higher. Demand good for all classes of... |
 Disease X-19 from Michael_Novakhov (12 sites) 6h Disease X-19 from Michael_Novakhov (12 sites) 6h |
| Disease X-19 Epidemiology from Michael_Novakhov (39 sites): Google Alert - Sars Cov-2... |
| NEW YORK (AP) — Brandon Taylor's "Filthy Animals" has won the Story ... Stay informed daily on the latest... |
 Disease X-19 from Michael_Novakhov (12 sites) 6h Disease X-19 from Michael_Novakhov (12 sites) 6h |
| Disease X-19 Epidemiology from Michael_Novakhov (39 sites): Google Alert - Coronavirus... |
| If a dog owner misses a payment, the dog could be repossessed by the pet store, Healey's office said.... |
 Disease X-19 from Michael_Novakhov (12 sites) 6h Disease X-19 from Michael_Novakhov (12 sites) 6h |
| Disease X-19 Epidemiology from Michael_Novakhov (39 sites): Google Alert - Coronavirus,... |
| LOS ANGELES — California is no longer recommending a five-day quarantine period for people who are exposed... |
 Disease X-19 from Michael_Novakhov (12 sites) 6h Disease X-19 from Michael_Novakhov (12 sites) 6h |
| Disease X-19 Epidemiology from Michael_Novakhov (39 sites): Google Alert - covid-19... |
| Who said we could eat meat? ... much more than Covid-19 has, and most of those instances of illness and... |
 Disease X-19 from Michael_Novakhov (12 sites) 6h Disease X-19 from Michael_Novakhov (12 sites) 6h |
| Disease X-19 Epidemiology from Michael_Novakhov (39 sites): Google Alert - coronavirus... |
| "If you did the right thing and got vaccinated last year, you protected yourself during the last surge.... |
 Disease X-19 from Michael_Novakhov (12 sites) 6h Disease X-19 from Michael_Novakhov (12 sites) 6h |
| Shanghai cases hit record as Xi reiterates urgency of COVID curbs - Reuters |
| Shanghai cases hit record as Xi reiterates urgency of COVID curbs Reuters |
 "COVID" - Google News 6h "COVID" - Google News 6h |
| State's COVID-19 cases rising again | News | newburyportnews.com - The Daily News... |
| State's COVID-19 cases rising again | News | newburyportnews.com The Daily News of Newburyport |
 "COVID" - Google News 6h "COVID" - Google News 6h |
| Nebraska Receives Grade of A+ for Coronavirus Pandemic Response - Governor Pete Ricketts |
| Nebraska Receives Grade of A+ for Coronavirus Pandemic Response Governor Pete Ricketts |
 "coronavirus news" - Google News 6h "coronavirus news" - Google News 6h |
 | Barry Manilow tests positive for COVID-19; to miss New York opening of his musical,... |
| Barry Manilow tests positive for COVID-19; to miss New York opening of his musical, 'Harmony' Desert... |
 "Covid-19" - Google News 6h "Covid-19" - Google News 6h |
 | Louis restaurant reflects on 75 years, impact of COVID-19 - The Brown Daily Herald |
| Louis restaurant reflects on 75 years, impact of COVID-19 The Brown Daily Herald |
 "Covid-19" - Google News 6h "Covid-19" - Google News 6h |
| Disease X-19 Epidemiology from Michael_Novakhov (39 sites): Google Alert - covid-19... |
| A 6-year-old therapy dog has made his return to Holy Name Medical Center as the hospital restarts its... |
 Disease X-19 from Michael_Novakhov (12 sites) 6h Disease X-19 from Michael_Novakhov (12 sites) 6h |
| Disease X-19 Epidemiology from Michael_Novakhov (39 sites): Google Alert - coronavirus... |
| Gov. Ron DeSantis proposed a congressional map that likely gives Republicans four more seats and cuts... |
 Disease X-19 from Michael_Novakhov (12 sites) 6h Disease X-19 from Michael_Novakhov (12 sites) 6h |
| Disease X-19 Epidemiology from Michael_Novakhov (39 sites): Google Alert - coronavirus... |
| An approval has been granted after the Valneva COVID-19 vaccine was found to meet the required safety,... |
 Disease X-19 from Michael_Novakhov (12 sites) 6h Disease X-19 from Michael_Novakhov (12 sites) 6h |
| Disease X-19 Regions from Michael_Novakhov (8 sites): Google Alert - coronavirus... |
| The New York State Department of Public Health today announced the rapid ... the most highly-transmissible... |
 Disease X-19 from Michael_Novakhov (12 sites) 6h Disease X-19 from Michael_Novakhov (12 sites) 6h |
| Disease X-19 Epidemiology from Michael_Novakhov (39 sites): Google Alert - mink:... |
| Pudding & Mink Drugs Case Update : Police To Interrogate Victims For 4 Days | V6 News\వడ్లు కొనం... |
 Disease X-19 from Michael_Novakhov (12 sites) 6h Disease X-19 from Michael_Novakhov (12 sites) 6h |
| Disease X-19 Epidemiology from Michael_Novakhov (39 sites): Google Alert - mink:... |
| నేడు కస్టడీకి పబ్ కేసు నిందితుడు | Pudding and Mink Pub Case Latest Updates | hmtv #Pudding #MinkPub... |
 Disease X-19 from Michael_Novakhov (12 sites) 6h Disease X-19 from Michael_Novakhov (12 sites) 6h |
| Disease X-19 Epidemiology from Michael_Novakhov (39 sites): Google Alert - coronavirus... |
| For example, lateral flow tests use biological antibodies to trap and detect the Covid-19 virus, whereas... |
 Disease X-19 from Michael_Novakhov (12 sites) 6h Disease X-19 from Michael_Novakhov (12 sites) 6h |
| Disease X-19 Regions from Michael_Novakhov (8 sites): Google Alert - coronavirus... |
| 14-year-old boy among three killed by Israeli security forces amid continuing violence. Google Alert... |
 Disease X-19 from Michael_Novakhov (12 sites) 6h Disease X-19 from Michael_Novakhov (12 sites) 6h |
| Disease X-19 Epidemiology from Michael_Novakhov (39 sites): Google Alert - coronavirus... |
| Expanding drought leaves western US scrambling for water. by: SUSAN MONTOYA BRYAN, ... WHO: COVID cases... |
 Disease X-19 from Michael_Novakhov (12 sites) 6h Disease X-19 from Michael_Novakhov (12 sites) 6h |
| Disease X-19 Epidemiology from Michael_Novakhov (39 sites): Google Alert - mink:... |
| ... Koti Industrial and Technical Brushes , ABC TOOLS SPA , Bordo Industrial Pty ltd , Brush Research... |
 Disease X-19 from Michael_Novakhov (12 sites) 6h Disease X-19 from Michael_Novakhov (12 sites) 6h |
| Disease X-19 Epidemiology from Michael_Novakhov (39 sites): Google Alert - Coronavirus... |
| This is a protein found on the outside of the novel coronavirus that ... A healthcare worker holds a... |
 Disease X-19 from Michael_Novakhov (12 sites) 6h Disease X-19 from Michael_Novakhov (12 sites) 6h |
| Disease X-19 Epidemiology from Michael_Novakhov (39 sites): Google Alert - coronavirus... |
| Aspirus Health says it will comply with federal COVID-19 vaccine mandate. Updated Nov 4, 2021. Google... |
 Disease X-19 from Michael_Novakhov (12 sites) 6h Disease X-19 from Michael_Novakhov (12 sites) 6h |
| Disease X-19 Regions from Michael_Novakhov (8 sites): Google Alert - coronavirus... |
| The global coronavirus caseload has topped 501.5 million, ... Italy (161,187), Indonesia (155,746), France... |
 Disease X-19 from Michael_Novakhov (12 sites) 6h Disease X-19 from Michael_Novakhov (12 sites) 6h |
| WA Board of Health votes against adding COVID vaccines to K-12 school-required immunizations... |
| WA Board of Health votes against adding COVID vaccines to K-12 school-required immunizations The Seattle... |
 "COVID" - Google News 7h "COVID" - Google News 7h |
| COVID-19 case decline has bottomed out as omicron subvariant spreads through region... |
| COVID-19 case decline has bottomed out as omicron subvariant spreads through region Cadillac News |
 "Omicron" - Google News 7h "Omicron" - Google News 7h |
| New COVID-19 cases below 150,000 as Omicron wave wanes - 코리아타임스 |
| New COVID-19 cases below 150,000 as Omicron wave wanes 코리아타임스 |
 "Omicron" - Google News 7h "Omicron" - Google News 7h |
| What is Omicron BA.2? - NECN |
| What is Omicron BA.2? NECN |
 "Omicron" - Google News 7h "Omicron" - Google News 7h |
| Iowa COVID-19 cases hold steady; hospitalizations rise | News, Sports, Jobs - Marshalltown... |
| Iowa COVID-19 cases hold steady; hospitalizations rise | News, Sports, Jobs Marshalltown Times Republican |
 "coronavirus news" - Google News 7h "coronavirus news" - Google News 7h |
| Hong Kong Confirms It Will Ease COVID Restrictions From April 21 - U.S. News & World... |
| Hong Kong Confirms It Will Ease COVID Restrictions From April 21 U.S. News & World Report |
 "coronavirus news" - Google News 7h "coronavirus news" - Google News 7h |
 | Global COVID-19 cases and deaths fall for 3rd consecutive week, WHO says - FOX 5... |
| Global COVID-19 cases and deaths fall for 3rd consecutive week, WHO says FOX 5 Atlanta |
 "Covid-19" - Google News 7h "Covid-19" - Google News 7h |
| Disease X-19 General Issues from Michael_Novakhov (5 sites): Google Alert - Covid-19:... |
| Alaska Regional Hospital in Anchorage over the weekend had zero COVID-19 patients for the first time... |
 Disease X-19 from Michael_Novakhov (12 sites) 7h Disease X-19 from Michael_Novakhov (12 sites) 7h |
| Disease X-19 General Issues from Michael_Novakhov (5 sites): Google Alert - Covid-19:... |
| This file photograph shows medical assistant Frencesca Delprete takes care of a driver during COVID-19... |
 Disease X-19 from Michael_Novakhov (12 sites) 7h Disease X-19 from Michael_Novakhov (12 sites) 7h |
| Disease X-19 General Issues from Michael_Novakhov (5 sites): Google Alert - Covid-19:... |
| Time is running out for China to switch to a more sustainable strategy for containing the virus. A woman... |
 Disease X-19 from Michael_Novakhov (12 sites) 7h Disease X-19 from Michael_Novakhov (12 sites) 7h |
| Disease X-19 and Security from Michael_Novakhov (10 sites): Google Alert - coronavirus... |
| Investigators combed bombed-out towns and freshly dug graves in Ukraine yesterday for evidence of war... |
 Disease X-19 from Michael_Novakhov (12 sites) 7h Disease X-19 from Michael_Novakhov (12 sites) 7h |
| Disease X-19 and Security from Michael_Novakhov (10 sites): Google Alert - coronavirus... |
| With graveyards filling up, and the dead not getting to rest easily in Pakistan's Karachi, shady crews... |
 Disease X-19 from Michael_Novakhov (12 sites) 7h Disease X-19 from Michael_Novakhov (12 sites) 7h |
| Disease X-19 Publications from Michael_Novakhov (5 sites): Google Alert - Coronavirus... |
| Jeonghan of SEVENTEEN has tested positive for the coronavirus, ... News of Jeonghan's diagnosis comes... |
 Disease X-19 from Michael_Novakhov (12 sites) 7h Disease X-19 from Michael_Novakhov (12 sites) 7h |
| Disease X-19 General Issues from Michael_Novakhov (5 sites): Google Alert - Covid-19:... |
| Quarantining after an exposure to someone who has COVID-19 is still recommended in high-risk settings... |
 Disease X-19 from Michael_Novakhov (12 sites) 7h Disease X-19 from Michael_Novakhov (12 sites) 7h |
 | Valneva COVID-19 vaccine approved by MHRA |
| submitted by /u/civicode [link] [comments] |
 COVID-19 7h COVID-19 7h |
| Valneva Covid Vaccine Gets Approval from U.K. Regulator - Bloomberg |
| Valneva Covid Vaccine Gets Approval from U.K. Regulator Bloomberg |
 "COVID" - Google News 7h "COVID" - Google News 7h |
| Hahn pushes booster shots amid rising LA County COVID numbers - LA Daily News |
| Hahn pushes booster shots amid rising LA County COVID numbers LA Daily News |
 "COVID" - Google News 7h "COVID" - Google News 7h |
| VB holding free COVID vax clinic Friday - WAVY.com |
| VB holding free COVID vax clinic Friday WAVY.com |
 "COVID" - Google News 7h "COVID" - Google News 7h |
| Dr. Kelly Victory discusses the BA.2 omicron variant on the rise - - KUSI |
| Dr. Kelly Victory discusses the BA.2 omicron variant on the rise - KUSI |
 "Omicron" - Google News 7h "Omicron" - Google News 7h |
| 15 new Omicron community cases in Cambodia - The Phnom Penh Post |
| 15 new Omicron community cases in Cambodia The Phnom Penh Post |
 "Omicron" - Google News 7h "Omicron" - Google News 7h |
| What is Omicron BA.2? - NBC Chicago |
| What is Omicron BA.2? NBC Chicago |
 "Omicron" - Google News 7h "Omicron" - Google News 7h |
| 1st trace of new omicron subvariant detected in Onondaga County - The Daily Orange |
| 1st trace of new omicron subvariant detected in Onondaga County The Daily Orange |
 "Omicron" - Google News 7h "Omicron" - Google News 7h |
| What to Know about Stealth Omicron Subvariant BA.2 in Seattle - Seattle Met |
| What to Know about Stealth Omicron Subvariant BA.2 in Seattle Seattle Met |
 "Omicron" - Google News 7h "Omicron" - Google News 7h |
 | California lifts five-day quarantine rule for people exposed to COVID-19 but show... |
| California lifts five-day quarantine rule for people exposed to COVID-19 but show no symptoms San Francisco... |
 "Covid-19" - Google News 7h "Covid-19" - Google News 7h |
 | Students React to Changing 2022-23 COVID-19 Policy - Cornell University The Cornell... |
| Students React to Changing 2022-23 COVID-19 Policy Cornell University The Cornell Daily Sun |
 "Covid-19" - Google News 7h "Covid-19" - Google News 7h |
| Disease X-19 Epidemiology from Michael_Novakhov (39 sites): Google Alert - Coronavirus... |
| "The goal is to make human sources of food harder for a bear to get than ... Removing bird feeders, securing... |
 Disease X-19 from Michael_Novakhov (12 sites) 7h Disease X-19 from Michael_Novakhov (12 sites) 7h |
| Disease X-19 Epidemiology from Michael_Novakhov (39 sites): Google Alert - Coronavirus... |
| The main reason for the increase in deaths in 2021 was COVID-19, the AP reported, as new coronavirus... |
 Disease X-19 from Michael_Novakhov (12 sites) 7h Disease X-19 from Michael_Novakhov (12 sites) 7h |
| Disease X-19 Epidemiology from Michael_Novakhov (39 sites): Google Alert - coronavirus... |
| Dr. Ashish Jha, who started his new role on Monday, said he plans to speak "openly and plainly" to Americans... |
 Disease X-19 from Michael_Novakhov (12 sites) 7h Disease X-19 from Michael_Novakhov (12 sites) 7h |
| Disease X-19 Epidemiology from Michael_Novakhov (39 sites): Google Alert - Coronavirus... |
| Philadelphia brought back an indoor mask mandate, and the virus is spreading across U.S. cities. But... |
 Disease X-19 from Michael_Novakhov (12 sites) 7h Disease X-19 from Michael_Novakhov (12 sites) 7h |
| Disease X-19 Epidemiology from Michael_Novakhov (39 sites): Google Alert - Coronavirus... |
| In the video above, what the spreading COVID-19 subvariant really means for the coming months. Watch... |
 Disease X-19 from Michael_Novakhov (12 sites) 7h Disease X-19 from Michael_Novakhov (12 sites) 7h |
| Disease X-19 Epidemiology from Michael_Novakhov (39 sites): Google Alert - covid-19... |
| Ontario reported 1,332 people in hospital with COVID-19 on Wednesday and 182 in intensive care, compared... |
 Disease X-19 from Michael_Novakhov (12 sites) 7h Disease X-19 from Michael_Novakhov (12 sites) 7h |
| Disease X-19 Epidemiology from Michael_Novakhov (39 sites): Google Alert - coronavirus... |
| 66.8% of residents have received at least one dose of a vaccine. MDHSS will only report statewide COVID-19... |
 Disease X-19 from Michael_Novakhov (12 sites) 7h Disease X-19 from Michael_Novakhov (12 sites) 7h |
| Disease X-19 Epidemiology from Michael_Novakhov (39 sites): Google Alert - coronavirus... |
| Victorian Premier Daniel Andrews says the state's vaccine economy will likely end as soon as the peak... |
 Disease X-19 from Michael_Novakhov (12 sites) 7h Disease X-19 from Michael_Novakhov (12 sites) 7h |
| Disease X-19 Epidemiology from Michael_Novakhov (39 sites): Google Alert - covid-19... |
| Arizona coronavirus: LIVE news updates on COVID-19 pandemic ... Raw chorizo stored above cilantro and... |
 Disease X-19 from Michael_Novakhov (12 sites) 7h Disease X-19 from Michael_Novakhov (12 sites) 7h |
| Boston health officials say to 'remain vigilant' about COVID during Easter, Passover... |
| Boston health officials say to 'remain vigilant' about COVID during Easter, Passover amid rising cases Boston.com |
 "COVID" - Google News 8h "COVID" - Google News 8h |
| Oregon Shakespeare Festival seeks accessibility focus as it emerges from the COVID... |
| Oregon Shakespeare Festival seeks accessibility focus as it emerges from the COVID pandemic Oregon Public... |
 "COVID" - Google News 8h "COVID" - Google News 8h |
| WA Board of Health votes 'no' on including COVID vaccine in child immunizations -... |
| WA Board of Health votes 'no' on including COVID vaccine in child immunizations FOX 13 Seattle |
 "COVID" - Google News 8h "COVID" - Google News 8h |
| What's the new Omicron XE variant and should I be worried? - The Conversation |
| What's the new Omicron XE variant and should I be worried? The Conversation |
 "Omicron" - Google News 8h "Omicron" - Google News 8h |
| April 13 NH DHHS COVID-19 update: 263 positive results with 20 in Manchester; no... |
| April 13 NH DHHS COVID-19 update: 263 positive results with 20 in Manchester; no deaths reported Manchester... |
 "coronavirus news" - Google News 8h "coronavirus news" - Google News 8h |
 | COVID-19 Bulletin (04/14/22) - D Magazine |
| COVID-19 Bulletin (04/14/22) D Magazine |
 "Covid-19" - Google News 8h "Covid-19" - Google News 8h |
| Disease X-19 Publications from Michael_Novakhov (5 sites): Google Alert - coronavirus... |
| Joe Rogan invited "Real Time" host Bill Maher on "The Joe Rogan Experience" this week, where the two... |
 Disease X-19 from Michael_Novakhov (12 sites) 8h Disease X-19 from Michael_Novakhov (12 sites) 8h |
| Disease X-19 Publications from Michael_Novakhov (5 sites): Google Alert - new york... |
| But everyone in the bureaucratic system knows where the priority lies. Read the story here. —Li Yuan,... |
 Disease X-19 from Michael_Novakhov (12 sites) 8h Disease X-19 from Michael_Novakhov (12 sites) 8h |
| Disease X-19 Publications from Michael_Novakhov (5 sites): Google Alert - coronavirus... |
| Facebook · Twitter. Moderna's coronavirus vaccine, which is now marketed as Spikevax, was approved by... |
 Disease X-19 from Michael_Novakhov (12 sites) 8h Disease X-19 from Michael_Novakhov (12 sites) 8h |
| Disease X-19 Publications from Michael_Novakhov (5 sites): Google Alert - coronavirus... |
| Could text messages nudge people toward COVID vaccines? ... and limiting the impact of the next coronavirus... |
 Disease X-19 from Michael_Novakhov (12 sites) 8h Disease X-19 from Michael_Novakhov (12 sites) 8h |
| DOH: Slight rise in COVID cases tied to highly contagious 'stealth Omicron' - Hawaii... |
| DOH: Slight rise in COVID cases tied to highly contagious 'stealth Omicron' Hawaii News Now |
 "Omicron" - Google News 8h "Omicron" - Google News 8h |
 | Alaska reports 1,290 COVID-19 cases over a 7-day period as hospitalizations remain... |
| Alaska reports 1,290 COVID-19 cases over a 7-day period as hospitalizations remain low Anchorage Daily... |
 "Covid-19" - Google News 8h "Covid-19" - Google News 8h |
| Disease X-19 Epidemiology from Michael_Novakhov (39 sites): Google Alert - covid-19... |
| Bar owner of Wo Bar, Jacky Ip, 33, poses at a bar, amidst the coronavirus disease (COVID-19) pandemic,... |
 Disease X-19 from Michael_Novakhov (12 sites) 9h Disease X-19 from Michael_Novakhov (12 sites) 9h |
| Disease X-19 Regions from Michael_Novakhov (8 sites): Google Alert - coronavirus... |
| Subscribe to our newsletter here. Onondaga County is the first in New York state to have cases of the... |
 Disease X-19 from Michael_Novakhov (12 sites) 9h Disease X-19 from Michael_Novakhov (12 sites) 9h |
| Disease X-19 Epidemiology from Michael_Novakhov (39 sites): Google Alert - coronavirus... |
| Wastewater being used to detect COVID-19 hotspots ... so that the waste water where people don't have... |
 Disease X-19 from Michael_Novakhov (12 sites) 9h Disease X-19 from Michael_Novakhov (12 sites) 9h |
| Disease X-19 Epidemiology from Michael_Novakhov (39 sites): Google Alert - mink:... |
| Reagan Minks—elected Alabama State Vice President. Konnor Hutto—Math 7—4th Place. Jianne Holcombe—Math... |
 Disease X-19 from Michael_Novakhov (12 sites) 9h Disease X-19 from Michael_Novakhov (12 sites) 9h |
| Disease X-19 Epidemiology from Michael_Novakhov (39 sites): Google Alert - Sars Cov-2... |
| SARS-CoV-2-related coronaviruses were identified in eight of the 30 samples, ... from the 30 animals... |
 Disease X-19 from Michael_Novakhov (12 sites) 9h Disease X-19 from Michael_Novakhov (12 sites) 9h |
| Disease X-19 Epidemiology from Michael_Novakhov (39 sites): Google Alert - coronavirus... |
| The Arizona Department of Health Services has stopped reporting some information on COVID-19 hospitalizations.... |
 Disease X-19 from Michael_Novakhov (12 sites) 9h Disease X-19 from Michael_Novakhov (12 sites) 9h |
| Disease X-19 Epidemiology from Michael_Novakhov (39 sites): Google Alert - coronavirus... |
| SFD crews called to Washburn St. for fire · Neighbors in disbelief after alleged serial rapist … · Water... |
 Disease X-19 from Michael_Novakhov (12 sites) 9h Disease X-19 from Michael_Novakhov (12 sites) 9h |
| Disease X-19 Epidemiology from Michael_Novakhov (39 sites): Google Alert - covid-19... |
| Atchison Hospital Association - $414,800 will go toward reimbursement for lost revenue in 2020 due to... |
 Disease X-19 from Michael_Novakhov (12 sites) 9h Disease X-19 from Michael_Novakhov (12 sites) 9h |
| Disease X-19 Epidemiology from Michael_Novakhov (39 sites): Google Alert - coronavirus... |
| Omicron XE, a new coronavirus mashup of the omicron BA.2 subvariant and ... and a list of restrictions... |
 Disease X-19 from Michael_Novakhov (12 sites) 9h Disease X-19 from Michael_Novakhov (12 sites) 9h |
| Disease X-19 Epidemiology from Michael_Novakhov (39 sites): Google Alert - coronavirus... |
| The state's journey throughout the Covid-19 pandemic has been full of peaks and valleys. At several points,... |
 Disease X-19 from Michael_Novakhov (12 sites) 9h Disease X-19 from Michael_Novakhov (12 sites) 9h |
| Disease X-19 Epidemiology from Michael_Novakhov (39 sites): Google Alert - Coronavirus,... |
| NEW YORK — Faulty computer systems prevented surveillance cameras at two Brooklyn stations from getting... |
 Disease X-19 from Michael_Novakhov (12 sites) 9h Disease X-19 from Michael_Novakhov (12 sites) 9h |
| Disease X-19 Regions from Michael_Novakhov (8 sites): Google Alert - coronavirus... |
| BINGHAMTON, NY (WSKG) — Broome County's COVID-19 numbers are rising again. County Executive Jason Garnar... |
 Disease X-19 from Michael_Novakhov (12 sites) 9h Disease X-19 from Michael_Novakhov (12 sites) 9h |
| Disease X-19 Regions from Michael_Novakhov (8 sites): Google Alert - coronavirus... |
| SYRACUSE, N.Y. (WSYR-TV) — Onondaga County Executive Ryan McMahon held a COVID-19 briefing on April 13... |
 Disease X-19 from Michael_Novakhov (12 sites) 9h Disease X-19 from Michael_Novakhov (12 sites) 9h |
| Neighbors back Ukraine, demand accountability for war crimes - News-Gazette.com |
| Neighbors back Ukraine, demand accountability for war crimes News-Gazette.com |
 "coronavirus news" - Google News 9h "coronavirus news" - Google News 9h |
| Why You Need COVID Travel Insurance for Summer Trips - Verywell Health |
| Why You Need COVID Travel Insurance for Summer Trips Verywell Health |
 "coronavirus news" - Google News 9h "coronavirus news" - Google News 9h |
 | Several COVID-19 policies extended through June in emergency bill - The Connecticut... |
| Several COVID-19 policies extended through June in emergency bill The Connecticut Mirror |
 "Covid-19" - Google News 9h "Covid-19" - Google News 9h |
 | A guide to accessing crucial COVID-19 treatments in Maine - Bangor Daily News |
| A guide to accessing crucial COVID-19 treatments in Maine Bangor Daily News |
 "Covid-19" - Google News 9h "Covid-19" - Google News 9h |
 | Diagnostic test determines if Covid-19 antibodies are from vaccination or infection... |
| Diagnostic test determines if Covid-19 antibodies are from vaccination or infection MedCity News |
 "Covid-19" - Google News 9h "Covid-19" - Google News 9h |
| Disease X-19 and Security from Michael_Novakhov (10 sites): Google Alert - coronavirus... |
| On Wednesday, the "Copacabana" musician released a statement telling fans he contracted COVID and wouldn't... |
 Disease X-19 from Michael_Novakhov (12 sites) 9h Disease X-19 from Michael_Novakhov (12 sites) 9h |
| Disease X-19 and Security from Michael_Novakhov (10 sites): Google Alert - coronavirus... |
| The Chinese commercial capital of Shanghai warned on Wednesday that anyone who violates COVID-19 lockdown... |
 Disease X-19 from Michael_Novakhov (12 sites) 9h Disease X-19 from Michael_Novakhov (12 sites) 9h |
| Disease X-19 and Security from Michael_Novakhov (10 sites): Google Alert - coronavirus... |
| The Jiyanpur police in Azamgarh on Wednesday attached the properties created with illegal earnings by... |
 Disease X-19 from Michael_Novakhov (12 sites) 9h Disease X-19 from Michael_Novakhov (12 sites) 9h |
| Disease X-19 Regions from Michael_Novakhov (8 sites): Google Alert - coronavirus... |
| It's a staple in the neighborhood that's known for its daily made fresh cheeses and a variety of other... |
 Disease X-19 from Michael_Novakhov (12 sites) 9h Disease X-19 from Michael_Novakhov (12 sites) 9h |
| Hong Kong questions costs of COVID rules on mental health, livelihoods - Reuters |
| Hong Kong questions costs of COVID rules on mental health, livelihoods Reuters |
 "COVID" - Google News 9h "COVID" - Google News 9h |
| Truckers Caught in Covid Controls Snarl China's Supply Chains - Bloomberg |
| Truckers Caught in Covid Controls Snarl China's Supply Chains Bloomberg |
 "COVID" - Google News 9h "COVID" - Google News 9h |
| An Exit Interview With COVID Czar Jeff Zients - New York Magazine |
| An Exit Interview With COVID Czar Jeff Zients New York Magazine |
 "COVID" - Google News 9h "COVID" - Google News 9h |
| CDC extends travel mask requirement to May 3 as COVID rises - MLive.com |
| CDC extends travel mask requirement to May 3 as COVID rises MLive.com |
 "COVID" - Google News 9h "COVID" - Google News 9h |
 | COVID symptoms: Major COVID-19 symptom linked to brain damage - Deseret News |
| COVID symptoms: Major COVID-19 symptom linked to brain damage Deseret News |
 "Covid-19" - Google News 9h "Covid-19" - Google News 9h |
| Disease X-19 Epidemiology from Michael_Novakhov (39 sites): Google Alert - coronavirus... |
| "It's not clear why some infected people have GI symptoms," Bhatt said. "But other coronaviruses are... |
 Disease X-19 from Michael_Novakhov (12 sites) 10h Disease X-19 from Michael_Novakhov (12 sites) 10h |
| Disease X-19 Epidemiology from Michael_Novakhov (39 sites): Google Alert - Coronavirus... |
| The Centers for Disease Control and Prevention is continuing to monitor the effects of the variant on... |
 Disease X-19 from Michael_Novakhov (12 sites) 10h Disease X-19 from Michael_Novakhov (12 sites) 10h |
| Disease X-19 Epidemiology from Michael_Novakhov (39 sites): Google Alert - coronavirus... |
| The 9Round Fitness Center knows how to pack a punch, but this time, it's going toward a cause benefitting... |
 Disease X-19 from Michael_Novakhov (12 sites) 10h Disease X-19 from Michael_Novakhov (12 sites) 10h |
| Disease X-19 Epidemiology from Michael_Novakhov (39 sites): Google Alert - Coronavirus... |
| The PHO Order required all health authority employees to be vaccinated against COVID-19 in order to be... |
 Disease X-19 from Michael_Novakhov (12 sites) 10h Disease X-19 from Michael_Novakhov (12 sites) 10h |
| Disease X-19 Epidemiology from Michael_Novakhov (39 sites): Google Alert - coronavirus... |
| There are now 1,754 current COVID-19 cases diagnosed in New Hampshire. ... All American Assisted Living... |
 Disease X-19 from Michael_Novakhov (12 sites) 10h Disease X-19 from Michael_Novakhov (12 sites) 10h |
| Disease X-19 Epidemiology from Michael_Novakhov (39 sites): Google Alert - coronavirus... |
| "The concern is that even with all our vaccinations and people getting immunity, if the virus can be... |
 Disease X-19 from Michael_Novakhov (12 sites) 10h Disease X-19 from Michael_Novakhov (12 sites) 10h |
| Disease X-19 Epidemiology from Michael_Novakhov (39 sites): Google Alert - saliva... |
| Executive Summary: The latest COVID-19 Saliva Screening Test market research report offers a comprehensive... |
 Disease X-19 from Michael_Novakhov (12 sites) 10h Disease X-19 from Michael_Novakhov (12 sites) 10h |
| Disease X-19 Epidemiology from Michael_Novakhov (39 sites): Google Alert - Coronavirus... |
| In this Jan. 7, 2021, file photo, a health care worker prepares the Pfizer-BioNTech COVID-19 vaccine... |
 Disease X-19 from Michael_Novakhov (12 sites) 10h Disease X-19 from Michael_Novakhov (12 sites) 10h |
| Disease X-19 Epidemiology from Michael_Novakhov (39 sites): Google Alert - Coronavirus... |
| The COVID-19 vaccine and booster doses also are available in many healthcare providers' offices and pharmacies... |
 Disease X-19 from Michael_Novakhov (12 sites) 10h Disease X-19 from Michael_Novakhov (12 sites) 10h |
| Disease X-19 Epidemiology from Michael_Novakhov (39 sites): Google Alert - coronavirus... |
| Layered controls can significantly curb exposure to COVID-19 ... /Health and medicine/Epidemiology/Pathogens/Viruses/Coronavirus/SARS... |
 Disease X-19 from Michael_Novakhov (12 sites) 10h Disease X-19 from Michael_Novakhov (12 sites) 10h |
| Disease X-19 General Issues from Michael_Novakhov (5 sites): Google Alert - coronavirus:... |
| ... Wednesday that it is extending the nationwide mask requirement for public transit for 15 days as... |
 Disease X-19 from Michael_Novakhov (12 sites) 10h Disease X-19 from Michael_Novakhov (12 sites) 10h |
| Disease X-19 General Issues from Michael_Novakhov (5 sites): Google Alert - sars... |
| Abstract Coronavirus disease 2019 (COVID-19) is caused by severe acute respiratory syndrome coronavirus-2... |
 Disease X-19 from Michael_Novakhov (12 sites) 10h Disease X-19 from Michael_Novakhov (12 sites) 10h |
| Hong Kong to Relax Dining Restrictions as Deadly Covid Wave Ebbs - Bloomberg |
| Hong Kong to Relax Dining Restrictions as Deadly Covid Wave Ebbs Bloomberg |
 "COVID" - Google News 10h "COVID" - Google News 10h |
| Bay Area COVID cases are rising. How worried are public health officials? - San Francisco... |
| Bay Area COVID cases are rising. How worried are public health officials? San Francisco Chronicle |
 "COVID" - Google News 10h "COVID" - Google News 10h |
| Covid Cancellations Hit Broadway as BA.2 Variant Spreads - Bloomberg |
| Covid Cancellations Hit Broadway as BA.2 Variant Spreads Bloomberg |
 "COVID" - Google News 10h "COVID" - Google News 10h |
 | Gwen Moore has tested positive for COVID-19. Earlier in the day, she attended Cavalier... |
| Gwen Moore has tested positive for COVID-19. Earlier in the day, she attended Cavalier Johnson's inauguration. Milwaukee... |
 "COVID-19" - Google News 10h "COVID-19" - Google News 10h |
 | COVID-19 may affect a group of biochemical reactions called one-carbon metabolism... |
| COVID-19 may affect a group of biochemical reactions called one-carbon metabolism News-Medical.Net |
 "COVID-19" - Google News 10h "COVID-19" - Google News 10h |
| New York's Surging Covid Cases Driven by New Omicron Subvariants - Bloomberg Law |
| New York's Surging Covid Cases Driven by New Omicron Subvariants Bloomberg Law |
 "Omicron" - Google News 10h "Omicron" - Google News 10h |
| Harvard Has Pared Down Most Covid Restrictions. Is Mandatory Testing Next? | News... |
| Harvard Has Pared Down Most Covid Restrictions. Is Mandatory Testing Next? | News Harvard Crimson |
 "coronavirus news" - Google News 10h "coronavirus news" - Google News 10h |
| US health officials cite new COVID strain in mask mandate extension on planes, public... |
| US health officials cite new COVID strain in mask mandate extension on planes, public transit WKMG News... |
 "coronavirus news" - Google News 10h "coronavirus news" - Google News 10h |
| COVID therapeutics become more available at testing sites - Spectrum News 1 |
| COVID therapeutics become more available at testing sites Spectrum News 1 |
 "coronavirus news" - Google News 10h "coronavirus news" - Google News 10h |
| Scientific evidence does not support ivermectin as a treatment for COVID-19 - PolitiFact |
| Scientific evidence does not support ivermectin as a treatment for COVID-19 PolitiFact |
 "coronavirus news" - Google News 10h "coronavirus news" - Google News 10h |
 | Hard to say how big COVID-19 wave gets, experts say - Spectrum News 1 |
| Hard to say how big COVID-19 wave gets, experts say Spectrum News 1 |
 "Covid-19" - Google News 10h "Covid-19" - Google News 10h |
 | Murphy Signs Executive Order Clarifying COVID-19 Vaccine Requirements - InsiderNJ |
| Murphy Signs Executive Order Clarifying COVID-19 Vaccine Requirements InsiderNJ |
 "Covid-19" - Google News 10h "Covid-19" - Google News 10h |
| Disease X-19 General Issues from Michael_Novakhov (5 sites): Google Alert - Latest... |
| The state also reported 286 hospitalized COVID-19 patients. Here's the data reported ... Stay up to date... |
 Disease X-19 from Michael_Novakhov (12 sites) 10h Disease X-19 from Michael_Novakhov (12 sites) 10h |
| Disease X-19 General Issues from Michael_Novakhov (5 sites): Google Alert - Covid-19:... |
| Critics have seized on the fact that states have rolled back rules requiring masks in restaurants, stores... |
 Disease X-19 from Michael_Novakhov (12 sites) 10h Disease X-19 from Michael_Novakhov (12 sites) 10h |
| Disease X-19 and Security from Michael_Novakhov (10 sites): Google Alert - Coronavirus... |
| KPMG has been selected to develop 5G prototype application for a US Marine Corps (USMC) smart warehouse... |
 Disease X-19 from Michael_Novakhov (12 sites) 10h Disease X-19 from Michael_Novakhov (12 sites) 10h |
| Disease X-19 and Security from Michael_Novakhov (10 sites): Google Alert - Coronavirus... |
| "CDC continues to monitor the spread of the Omicron Covid-19 variant, especially the BA.2 subvariant... |
 Disease X-19 from Michael_Novakhov (12 sites) 10h Disease X-19 from Michael_Novakhov (12 sites) 10h |
| Disease X-19 and Security from Michael_Novakhov (10 sites): Google Alert - Coronavirus... |
| Now, according to an expert on Russian intelligence services, ... the Fifth Service for failures in this... |
 Disease X-19 from Michael_Novakhov (12 sites) 10h Disease X-19 from Michael_Novakhov (12 sites) 10h |
| Disease X-19 General Issues from Michael_Novakhov (5 sites): Google Alert - Latest... |
| The next COVID update from the state will be April 20. Advertisement. Copyright 2022 WILX. All rights... |
 Disease X-19 from Michael_Novakhov (12 sites) 10h Disease X-19 from Michael_Novakhov (12 sites) 10h |
| Savannah-Chatham schools decide how to use $99 million COVID relief fund - WTOC |
| Savannah-Chatham schools decide how to use $99 million COVID relief fund WTOC |
 "COVID" - Google News 10h "COVID" - Google News 10h |
| Cardiac Issues After COVID Infection and Vaccination: New Data - Medscape |
| Cardiac Issues After COVID Infection and Vaccination: New Data Medscape |
 "COVID" - Google News 10h "COVID" - Google News 10h |
| FDA expected to OK additional Covid-19 booster shots for adults 50 and over this... |
| FDA expected to OK additional Covid-19 booster shots for adults 50 and over this week CNN |
 "COVID" - Google News 10h "COVID" - Google News 10h |
| State health officials say COVID-19 transmission rising - KTLA Los Angeles |
| State health officials say COVID-19 transmission rising KTLA Los Angeles |
 "COVID-19" - Google News 10h "COVID-19" - Google News 10h |
 | Nanoparticles could enable a more sensitive and durable rapid COVID-19 test - Science... |
| Nanoparticles could enable a more sensitive and durable rapid COVID-19 test Science Daily |
 "COVID-19" - Google News 10h "COVID-19" - Google News 10h |
| WA past Omicron peak, national cases rise - Bega District News |
| WA past Omicron peak, national cases rise Bega District News |
 "Omicron" - Google News 10h "Omicron" - Google News 10h |
| Dietary influences on long COVID in children - News-Medical.Net |
| Dietary influences on long COVID in children News-Medical.Net |
 "coronavirus news" - Google News 10h "coronavirus news" - Google News 10h |
| COVID-19 cases rising again | News | eagletribune.com - Eagle-Tribune |
| COVID-19 cases rising again | News | eagletribune.com Eagle-Tribune |
 "coronavirus news" - Google News 10h "coronavirus news" - Google News 10h |
 | Thomasville hospital facing closure due to COVID-19 bureaucracy - NBC 15 WPMI |
| Thomasville hospital facing closure due to COVID-19 bureaucracy NBC 15 WPMI |
 "Covid-19" - Google News 10h "Covid-19" - Google News 10h |
 | Broome County COVID-19 cases are rising again - WSKG.org |
| Broome County COVID-19 cases are rising again WSKG.org |
 "Covid-19" - Google News 10h "Covid-19" - Google News 10h |
| Xi Says China Must Persist With Covid Zero Even as Costs Mount - Bloomberg |
| Xi Says China Must Persist With Covid Zero Even as Costs Mount Bloomberg |
 "COVID" - Google News 11h "COVID" - Google News 11h |
| School Mask Mandates and the New COVID Variant: What to Watch - Edweek.org |
| School Mask Mandates and the New COVID Variant: What to Watch Edweek.org |
 "COVID" - Google News 11h "COVID" - Google News 11h |
| Illinois Still In 'Pretty Good Place' As COVID Cases Tick Up, Gov. Pritzker Says... |
| Illinois Still In 'Pretty Good Place' As COVID Cases Tick Up, Gov. Pritzker Says Block Club Chicago |
 "COVID" - Google News 11h "COVID" - Google News 11h |
| Disease X-19 Regions from Michael_Novakhov (8 sites): Google Alert - coronavirus... |
| Researchers, led by Ori Magen, MD, Clalit Research Institute, Innovation Division, Clalit Health Services,... |
 Disease X-19 from Michael_Novakhov (12 sites) 11h Disease X-19 from Michael_Novakhov (12 sites) 11h |
| Disease X-19 Regions from Michael_Novakhov (8 sites): Google Alert - coronavirus... |
| Cross River New Jersey team joined Heroes to Heroes before their departure to Israel at Newark Liberty... |
 Disease X-19 from Michael_Novakhov (12 sites) 11h Disease X-19 from Michael_Novakhov (12 sites) 11h |
| Disease X-19 Regions from Michael_Novakhov (8 sites): Google Alert - coronavirus... |
| Israeli troops open fire as crowd pelts them with rocks and incendiary devices in Nablus after clashes... |
 Disease X-19 from Michael_Novakhov (12 sites) 11h Disease X-19 from Michael_Novakhov (12 sites) 11h |
 | New COVID-19 nasal spray outperforms current antibody treatments in mice: A single... |
| New COVID-19 nasal spray outperforms current antibody treatments in mice: A single inhaled dose treated... |
 "COVID-19" - Google News 11h "COVID-19" - Google News 11h |
 | COVID-19 vaccines will not be required for school entry in Washington state - The... |
| COVID-19 vaccines will not be required for school entry in Washington state The Spokesman Review |
 "COVID-19" - Google News 11h "COVID-19" - Google News 11h |
| WA past Omicron peak, national cases rise - The Canberra Times |
| WA past Omicron peak, national cases rise The Canberra Times |
 "Omicron" - Google News 11h "Omicron" - Google News 11h |
| April 13 coronavirus statistics | News | thedailycitizen.com - Searcy Daily Citizen |
| April 13 coronavirus statistics | News | thedailycitizen.com Searcy Daily Citizen |
 "coronavirus news" - Google News 11h "coronavirus news" - Google News 11h |
| CCHD reports first flu death of 2021-2022 season; 2 COVID-19 deaths reported after... |
| CCHD reports first flu death of 2021-2022 season; 2 COVID-19 deaths reported after 3 weeks of no deaths Montana... |
 "Covid-19" - Google News 11h "Covid-19" - Google News 11h |
| Erie County moves to 'medium' COVID-19 Community Levels category - WGRZ.com |
| Erie County moves to 'medium' COVID-19 Community Levels category WGRZ.com |
 "Covid-19" - Google News 11h "Covid-19" - Google News 11h |
| The Omicron (B.1.1.529) SARS-CoV-2 variant of concern also affects companion animals |
| The recent emergence of the Omicron variant (B.1.1.529) has brought with it a large increase in the incidence... |
 bioRxiv Channel: COVID-19 SARS-CoV-2 preprints from medRxiv and bioRxiv 11h bioRxiv Channel: COVID-19 SARS-CoV-2 preprints from medRxiv and bioRxiv 11h |
| Markers of Fungal Translocation Are Elevated During Post-Acute Sequelae of SARS-CoV-2... |
| Long COVID, a type of Post-Acute Sequelae of SARS CoV-2 infection (PASC), has been associated with sustained... |
 bioRxiv Channel: COVID-19 SARS-CoV-2 preprints from medRxiv and bioRxiv 11h bioRxiv Channel: COVID-19 SARS-CoV-2 preprints from medRxiv and bioRxiv 11h |
 | Effectiveness of COVID-19 vaccines against hospitalization and death in Canada: A... |
| submitted by /u/afk05 [link] [comments] |
| |
| COVID-19 cases ticked upward last week, even as numbers remain far below infection... |
| COVID-19 cases ticked upward last week, even as numbers remain far below infection peaks Tennessean |
 "COVID" - Google News 11h "COVID" - Google News 11h |
| Disease X-19 Publications from Michael_Novakhov (5 sites): Google Alert - coronavirus... |
| On the heels of joining NBC Sports to be a part of the network's USFL broadcast team, former Dallas Cowboys... |
 Disease X-19 from Michael_Novakhov (12 sites) 11h Disease X-19 from Michael_Novakhov (12 sites) 11h |
| Disease X-19 Publications from Michael_Novakhov (5 sites): Google Alert - coronavirus... |
| Unlike many other Big Tech firms, Twitter doesn't have a dual-share class system, and it could wish it... |
 Disease X-19 from Michael_Novakhov (12 sites) 11h Disease X-19 from Michael_Novakhov (12 sites) 11h |
 | Honolulu Mayor Rick Blangiardi tests positive for COVID-19 - Honolulu Star-Advertiser |
| Honolulu Mayor Rick Blangiardi tests positive for COVID-19 Honolulu Star-Advertiser |
 "Covid-19" - Google News 11h "Covid-19" - Google News 11h |
| Historic Theater Sheltering Mariupol Civilians Hit By Air Strike, Number Of Casualties... |
| Historic Theater Sheltering Mariupol Civilians Hit By Air Strike, Number Of Casualties Unknown Radio... |
 "Coronavirus Origins Are Still Uncertain - US Intel Probe" - Google News 11h "Coronavirus Origins Are Still Uncertain - US Intel Probe" - Google News 11h |
| Structural and biochemical mechanism for increased infectivity and immune evasion... |
| The Omicron BA.2 variant has become a dominant infective strain worldwide. Receptor binding studies reveal... |
 bioRxiv Channel: COVID-19 SARS-CoV-2 preprints from medRxiv and bioRxiv 11h bioRxiv Channel: COVID-19 SARS-CoV-2 preprints from medRxiv and bioRxiv 11h |
 | Coachella 2022: Fans talk about return to festival in post-COVID-19 environment -... |
| Coachella 2022: Fans talk about return to festival in post-COVID-19 environment Press-Enterprise |
 "COVID-19" - Google News 12h "COVID-19" - Google News 12h |
| Global COVID cases fall as CDC extends travel mask order - CIDRAP |
| Global COVID cases fall as CDC extends travel mask order CIDRAP |
 "COVID" - Google News 12h "COVID" - Google News 12h |
| CDC extends public transit mask requirement to May 3 as COVID cases tick up - PBS... |
| CDC extends public transit mask requirement to May 3 as COVID cases tick up PBS NewsHour |
 "COVID" - Google News 12h "COVID" - Google News 12h |
| Former Democratic presidential nominee Hillary Clinton tests positive for COVID-19... |
| Former Democratic presidential nominee Hillary Clinton tests positive for COVID-19 USA TODAY |
 "COVID" - Google News 12h "COVID" - Google News 12h |
| Disease X-19 Epidemiology from Michael_Novakhov (39 sites): Google Alert - coronavirus... |
| The review which was spear-headed by epidemiologist and public health ... Article heading image for New... |
 Disease X-19 from Michael_Novakhov (12 sites) 12h Disease X-19 from Michael_Novakhov (12 sites) 12h |
| Fewer hospital admissions and death were seen with SARS-CoV-2 Delta (B.1.617.2) compared... |
| Fewer hospital admissions and death were seen with SARS-CoV-2 Delta (B.1.617.2) compared to Omicron (B.1.1.529)... |
 "Omicron" - Google News 12h "Omicron" - Google News 12h |
| S. Korea's new COVID-19 cases below 150,000 as omicron wave wanes - The Korea Herald |
| S. Korea's new COVID-19 cases below 150,000 as omicron wave wanes The Korea Herald |
 "Omicron" - Google News 12h "Omicron" - Google News 12h |
| Why 'let it rip' not the right approach to Omicron - China Daily |
| Why 'let it rip' not the right approach to Omicron China Daily |
 "Omicron" - Google News 12h "Omicron" - Google News 12h |
| Healthcare services coping in south as Omicron wave lingers - RNZ |
| Healthcare services coping in south as Omicron wave lingers RNZ |
 "Omicron" - Google News 12h "Omicron" - Google News 12h |
| SARS-CoV-2 Delta breakthrough infections in vaccinated patients |
| The continuous emergence of SARS-CoV-2 variants with increased transmission and immune evasion has caused... |
 bioRxiv Channel: COVID-19 SARS-CoV-2 preprints from medRxiv and bioRxiv 12h bioRxiv Channel: COVID-19 SARS-CoV-2 preprints from medRxiv and bioRxiv 12h |
| Broadly neutralizing and protective nanobodies against diverse sarbecoviruses |
| As SARS-CoV-2 Omicron and other variants of concern continue spreading around the world, development... |
 bioRxiv Channel: COVID-19 SARS-CoV-2 preprints from medRxiv and bioRxiv 12h bioRxiv Channel: COVID-19 SARS-CoV-2 preprints from medRxiv and bioRxiv 12h |
| Honolulu Mayor Rick Blangiardi tests positive for COVID-19 - KITV Honolulu |
| Honolulu Mayor Rick Blangiardi tests positive for COVID-19 KITV Honolulu |
 "COVID-19" - Google News 12h "COVID-19" - Google News 12h |
 | 3 doses of COVID-19 vaccine important for patients who undergo solid organ transplants... |
| 3 doses of COVID-19 vaccine important for patients who undergo solid organ transplants – Washington University... |
 "COVID-19" - Google News 12h "COVID-19" - Google News 12h |
| COVID: 50 Marin students infected on spring break trip - Marin Independent Journal |
| COVID: 50 Marin students infected on spring break trip Marin Independent Journal |
 "COVID" - Google News 12h "COVID" - Google News 12h |
| Vermont COVID patient reunites with family after 6 months in hospital - WCAX |
| Vermont COVID patient reunites with family after 6 months in hospital WCAX |
 "COVID" - Google News 12h "COVID" - Google News 12h |
| Disease X-19 Epidemiology from Michael_Novakhov (39 sites): Google Alert - coronavirus... |
| A 15-year-old girl has died from COVID-19, making her the second person under the age of 18 to die during... |
 Disease X-19 from Michael_Novakhov (12 sites) 12h Disease X-19 from Michael_Novakhov (12 sites) 12h |
| Disease X-19 Epidemiology from Michael_Novakhov (39 sites): Google Alert - coronavirus... |
| Your body naturally makes antibodies to fight infection. ... Individuals who have tested positive for... |
 Disease X-19 from Michael_Novakhov (12 sites) 12h Disease X-19 from Michael_Novakhov (12 sites) 12h |
| Disease X-19 Epidemiology from Michael_Novakhov (39 sites): Google Alert - saliva... |
| The advent of portable genetic test for COVID-19 enables to run test on demand and eliminate waiting... |
 Disease X-19 from Michael_Novakhov (12 sites) 12h Disease X-19 from Michael_Novakhov (12 sites) 12h |
| Disease X-19 Epidemiology from Michael_Novakhov (39 sites): Google Alert - Coronavirus,... |
| With COVID cases ticking up again, the Centers for Disease Control will extend the mask requirements... |
 Disease X-19 from Michael_Novakhov (12 sites) 12h Disease X-19 from Michael_Novakhov (12 sites) 12h |
| Disease X-19 Epidemiology from Michael_Novakhov (39 sites): Google Alert - Coronavirus,... |
| ... surveillance cameras at two Brooklyn stations from getting pictures of the gunman who sprayed bullets... |
 Disease X-19 from Michael_Novakhov (12 sites) 12h Disease X-19 from Michael_Novakhov (12 sites) 12h |
| Disease X-19 Epidemiology from Michael_Novakhov (39 sites): Google Alert - Coronavirus,... |
| Seven months ago, the MTA announced that all 472 subway stations were now outfitted with security cameras.... |
 Disease X-19 from Michael_Novakhov (12 sites) 12h Disease X-19 from Michael_Novakhov (12 sites) 12h |
| Disease X-19 Epidemiology from Michael_Novakhov (39 sites): Google Alert - coronavirus... |
| Probable cases include individuals who have symptoms consistent with COVID-19 and an epidemiologic link... |
 Disease X-19 from Michael_Novakhov (12 sites) 12h Disease X-19 from Michael_Novakhov (12 sites) 12h |
| Disease X-19 Regions from Michael_Novakhov (8 sites): Google Alert - coronavirus... |
| Iran's foreign minister said Wednesday that a preliminary deal had been reached with a foreign bank over... |
 Disease X-19 from Michael_Novakhov (12 sites) 12h Disease X-19 from Michael_Novakhov (12 sites) 12h |
| Disease X-19 Epidemiology from Michael_Novakhov (39 sites): Google Alert - Coronavirus... |
| The Texas Department of State Health Services confirmed Tuesday that the ... and allows that staff to... |
 Disease X-19 from Michael_Novakhov (12 sites) 12h Disease X-19 from Michael_Novakhov (12 sites) 12h |
| Disease X-19 Epidemiology from Michael_Novakhov (39 sites): Google Alert - coronavirus... |
| A new protein-based antiviral nasal spray is being advanced to Phase I human clinical trials to treat... |
 Disease X-19 from Michael_Novakhov (12 sites) 12h Disease X-19 from Michael_Novakhov (12 sites) 12h |
| Disease X-19 Epidemiology from Michael_Novakhov (39 sites): Google Alert - coronavirus... |
| Decline in reported chlamydia cases is likely due to decreased STD screening and underdiagnosis during... |
 Disease X-19 from Michael_Novakhov (12 sites) 12h Disease X-19 from Michael_Novakhov (12 sites) 12h |
| Disease X-19 Regions from Michael_Novakhov (8 sites): Google Alert - Coronavirus... |
| The state also reported 286 hospitalized COVID-19 patients. Here's the data reported ... Brooklyn subway... |
 Disease X-19 from Michael_Novakhov (12 sites) 12h Disease X-19 from Michael_Novakhov (12 sites) 12h |
| Disease X-19 General Issues from Michael_Novakhov (5 sites): Google Alert - Latest... |
| Image: People walk through a mall in New York City on April 4, 2022 ... As key Covid indicators such... |
 Disease X-19 from Michael_Novakhov (12 sites) 12h Disease X-19 from Michael_Novakhov (12 sites) 12h |
| Disease X-19 General Issues from Michael_Novakhov (5 sites): Google Alert - Latest... |
| Manilow was scheduled to attend the opening night of his new Broadway show "Harmony: A New Musical,"... |
 Disease X-19 from Michael_Novakhov (12 sites) 12h Disease X-19 from Michael_Novakhov (12 sites) 12h |
| Disease X-19 General Issues from Michael_Novakhov (5 sites): Google Alert - Latest... |
| New data on cardiac complications linked to COVID-19 show that such issues are ... Editor's note: Find... |
 Disease X-19 from Michael_Novakhov (12 sites) 12h Disease X-19 from Michael_Novakhov (12 sites) 12h |
| Disease X-19 General Issues from Michael_Novakhov (5 sites): Google Alert - Latest... |
| Cuyahoga County has a low level of community transmission of COVID-19, and is averaging 50 new cases... |
 Disease X-19 from Michael_Novakhov (12 sites) 12h Disease X-19 from Michael_Novakhov (12 sites) 12h |
| Disease X-19 Regions from Michael_Novakhov (8 sites): Google Alert - Coronavirus... |
| April 13, 2022 Brooklyn Eagle Staff. Active working space at the BioBAT research and manufacturing facility... |
 Disease X-19 from Michael_Novakhov (12 sites) 12h Disease X-19 from Michael_Novakhov (12 sites) 12h |
| COVID cases spread after NC high school prom, forcing temporary return to masking... |
| COVID cases spread after NC high school prom, forcing temporary return to masking Raleigh News &... |
 "coronavirus news" - Google News 12h "coronavirus news" - Google News 12h |
| Coronavirus: L.A. County reported 973 new cases and 11 more deaths, April 13 - LA... |
| Coronavirus: L.A. County reported 973 new cases and 11 more deaths, April 13 LA Daily News |
 "coronavirus news" - Google News 12h "coronavirus news" - Google News 12h |
| CDC study highlights effectiveness of COVID-19 booster vaccination against reinfection... |
| CDC study highlights effectiveness of COVID-19 booster vaccination against reinfection and hospitalization News-Medical.Net |
 "coronavirus news" - Google News 12h "coronavirus news" - Google News 12h |
| The Most Common BA.2 & Omicron Symptoms In Quebec Aren't The Ones You Might Expect... |
| The Most Common BA.2 & Omicron Symptoms In Quebec Aren't The Ones You Might Expect MTL Blog |
 "Omicron" - Google News 12h "Omicron" - Google News 12h |
 | Larimer County COVID-19 data on April 13, 2022 - Loveland Reporter-Herald |
| Larimer County COVID-19 data on April 13, 2022 Loveland Reporter-Herald |
 "COVID-19" - Google News 13h "COVID-19" - Google News 13h |
 | Why feds are pointing out limitations to wastewater tests for COVID-19 - Deseret... |
| Why feds are pointing out limitations to wastewater tests for COVID-19 Deseret News |
 "COVID-19" - Google News 13h "COVID-19" - Google News 13h |
| Show them the money: Pay the vaccine-hesitant to get their COVID-19 shots - Science... |
| Show them the money: Pay the vaccine-hesitant to get their COVID-19 shots Science Daily |
 "COVID" - Google News 13h "COVID" - Google News 13h |
| Illinois COVID Update Today: IL reports 2,060 new cases, 10 deaths - WLS-TV |
| Illinois COVID Update Today: IL reports 2,060 new cases, 10 deaths WLS-TV |
 "COVID" - Google News 13h "COVID" - Google News 13h |
| BA.2 variant of COVID: These are the symptoms to look out for - NJ.com |
| BA.2 variant of COVID: These are the symptoms to look out for NJ.com |
 "COVID" - Google News 13h "COVID" - Google News 13h |
| WHO: COVID cases and deaths fall for 3rd consecutive week - The Associated Press |
| WHO: COVID cases and deaths fall for 3rd consecutive week The Associated Press |
 "COVID" - Google News 13h "COVID" - Google News 13h |
| Disease X-19 Epidemiology from Michael_Novakhov (39 sites): Google Alert - covid-19... |
| You'll need an electric meat slicer to make the perfect charcuterie board at home. ... KXAN is tracking... |
 Disease X-19 from Michael_Novakhov (12 sites) 13h Disease X-19 from Michael_Novakhov (12 sites) 13h |
| Disease X-19 Epidemiology from Michael_Novakhov (39 sites): Google Alert - covid-19... |
| Losing skilled meat workers to employment overseas is a challenge for the Meat and Industries Board.... |
 Disease X-19 from Michael_Novakhov (12 sites) 13h Disease X-19 from Michael_Novakhov (12 sites) 13h |
| Disease X-19 Epidemiology from Michael_Novakhov (39 sites): Google Alert - coronavirus... |
| Even as the Centre allowed booster or precaution vaccine doses for Covid-19 in private hospitals from... |
 Disease X-19 from Michael_Novakhov (12 sites) 13h Disease X-19 from Michael_Novakhov (12 sites) 13h |
| Disease X-19 Epidemiology from Michael_Novakhov (39 sites): Google Alert - covid-19... |
| In January, the chairman of the House of Representatives subcommittee on economic and consumer policy... |
 Disease X-19 from Michael_Novakhov (12 sites) 13h Disease X-19 from Michael_Novakhov (12 sites) 13h |
| Disease X-19 Epidemiology from Michael_Novakhov (39 sites): Google Alert - covid-19... |
| In January, the chairman of the House of Representatives subcommittee on economic and consumer policy... |
 Disease X-19 from Michael_Novakhov (12 sites) 13h Disease X-19 from Michael_Novakhov (12 sites) 13h |
| Disease X-19 Epidemiology from Michael_Novakhov (39 sites): Google Alert - coronavirus... |
| Pharmacists take over COVID-19 shots as province shuts down vaccine clinics. New Brunswick is also deviating... |
 Disease X-19 from Michael_Novakhov (12 sites) 13h Disease X-19 from Michael_Novakhov (12 sites) 13h |
| Disease X-19 Epidemiology from Michael_Novakhov (39 sites): Google Alert - covid-19... |
| The right meat slicer can help you slice cold cuts, artisan bread and raw meat for ... All NETN counties... |
 Disease X-19 from Michael_Novakhov (12 sites) 13h Disease X-19 from Michael_Novakhov (12 sites) 13h |
| Disease X-19 Epidemiology from Michael_Novakhov (39 sites): Google Alert - covid-19... |
| The retail industry in Fresno, California has more workers now than it did before the coronavirus pandemic.... |
 Disease X-19 from Michael_Novakhov (12 sites) 13h Disease X-19 from Michael_Novakhov (12 sites) 13h |
| Disease X-19 Epidemiology from Michael_Novakhov (39 sites): Google Alert - coronavirus... |
| Cute baby bunnies are a staple of Easter, but the North Carolina Wildlife Resources Commission said taking... |
 Disease X-19 from Michael_Novakhov (12 sites) 13h Disease X-19 from Michael_Novakhov (12 sites) 13h |
| Disease X-19 Epidemiology from Michael_Novakhov (39 sites): Google Alert - Covid-19:... |
| New Jersey state epidemiologist Dr. Christina Tan helps dispel some of the top myths she's encountered... |
 Disease X-19 from Michael_Novakhov (12 sites) 13h Disease X-19 from Michael_Novakhov (12 sites) 13h |
| Here are the latest COVID-19 numbers confirmed Wednesday in Washington state - Tacoma... |
| Here are the latest COVID-19 numbers confirmed Wednesday in Washington state Tacoma News Tribune |
 "coronavirus news" - Google News 13h "coronavirus news" - Google News 13h |
| COVID-19 case numbers from around the states and territories - ABC News |
| COVID-19 case numbers from around the states and territories ABC News |
 "coronavirus news" - Google News 13h "coronavirus news" - Google News 13h |
| News Wrap: CDC extends COVID mask mandate for air travel - PBS NewsHour |
| News Wrap: CDC extends COVID mask mandate for air travel PBS NewsHour |
 "coronavirus news" - Google News 13h "coronavirus news" - Google News 13h |
| France's Macron hits back at rival over 'killer' chants - Arab News |
| France's Macron hits back at rival over 'killer' chants Arab News |
 "aggressive squirrels in new york city" - Google News 13h "aggressive squirrels in new york city" - Google News 13h |
| What is Omicron BA.2? - NBC10 Boston |
| What is Omicron BA.2? NBC10 Boston |
 "Omicron" - Google News 13h "Omicron" - Google News 13h |
| New 'highly contagious' omicron BA.2.12 and BA.2.12.1 subvariants detected in NY... |
| New 'highly contagious' omicron BA.2.12 and BA.2.12.1 subvariants detected in NY City & State |
 "Omicron" - Google News 13h "Omicron" - Google News 13h |
 | Molecularly Imprinted Polymer Nanoparticles Enable Rapid, Reliable, and Robust Point-of-Care... |
| submitted by /u/Peeecee7896 [link] [comments] |
| |
 | Key benefits of dexamethasone and antibody treatment in COVID-19 hamster models revealed... |
| submitted by /u/Peeecee7896 [link] [comments] |
| |
 | Vaccine hesitancy and monetary incentives |
| submitted by /u/Peeecee7896 [link] [comments] |
| |
 | U.S. CDC to shrink COVID-19 int'l travel avoidance list - Reuters |
| U.S. CDC to shrink COVID-19 int'l travel avoidance list Reuters |
 "COVID-19" - Google News 13h "COVID-19" - Google News 13h |
| Mass. reports 1,969 new COVID-19 cases, 1 new death - Boston.com |
| Mass. reports 1,969 new COVID-19 cases, 1 new death Boston.com |
 "COVID" - Google News 13h "COVID" - Google News 13h |
| COVID in Northeast Ohio: Health leaders react as cases begin to increase around the... |
| COVID in Northeast Ohio: Health leaders react as cases begin to increase around the nation WKYC.com |
 "COVID" - Google News 13h "COVID" - Google News 13h |
| White House taps top HHS lawyer as No. 2 Covid response official - CNN |
| White House taps top HHS lawyer as No. 2 Covid response official CNN |
 "COVID" - Google News 13h "COVID" - Google News 13h |
| Disease X-19 and Security from Michael_Novakhov (10 sites): Google Alert - Coronavirus... |
| The U.S. was already in a mental health crisis, with suicide rates climbing and chronic problems accessing... |
 Disease X-19 from Michael_Novakhov (12 sites) 13h Disease X-19 from Michael_Novakhov (12 sites) 13h |
| Disease X-19 and Security from Michael_Novakhov (10 sites): Google Alert - Coronavirus... |
| ... the U.S. Navy hospital ship that was deployed in Los Angeles harbor to ... COVID-19 pandemic was... |
 Disease X-19 from Michael_Novakhov (12 sites) 13h Disease X-19 from Michael_Novakhov (12 sites) 13h |
| Disease X-19 and Security from Michael_Novakhov (10 sites): Google Alert - Coronavirus... |
| President Biden on Wednesday approved $800 million in new military assistance to Ukraine, including weaponry... |
 Disease X-19 from Michael_Novakhov (12 sites) 13h Disease X-19 from Michael_Novakhov (12 sites) 13h |
| Disease X-19 and Security from Michael_Novakhov (10 sites): Google Alert - Coronavirus... |
| Although the legislative session began amid a resurgent coronavirus pandemic in January, nearly all General... |
 Disease X-19 from Michael_Novakhov (12 sites) 13h Disease X-19 from Michael_Novakhov (12 sites) 13h |
| Disease X-19 and Security from Michael_Novakhov (10 sites): Google Alert - Coronavirus... |
| U.S. · Biden approves another $800M in US military aid to Ukraine, including howitzers, helicopters and... |
 Disease X-19 from Michael_Novakhov (12 sites) 13h Disease X-19 from Michael_Novakhov (12 sites) 13h |
| Disease X-19 General Issues from Michael_Novakhov (5 sites): Google Alert - coronavirus:... |
| A woman receives a dose of the vaccine against the coronavirus disease (COVID-19 at a Red Cross vaccination... |
 Disease X-19 from Michael_Novakhov (12 sites) 13h Disease X-19 from Michael_Novakhov (12 sites) 13h |
| Disease X-19 General Issues from Michael_Novakhov (5 sites): Google Alert - sars... |
| This partnership comes at the same time as a $6.1 million investment led by Marko Bogievski and K One... |
 Disease X-19 from Michael_Novakhov (12 sites) 13h Disease X-19 from Michael_Novakhov (12 sites) 13h |
| Disease X-19 and Security from Michael_Novakhov (10 sites): Google Alert - coronavirus... |
| They weren't authorized to discuss the ongoing investigation and spoke on condition of anonymity. Chief... |
 Disease X-19 from Michael_Novakhov (12 sites) 13h Disease X-19 from Michael_Novakhov (12 sites) 13h |
| Disease X-19 and Security from Michael_Novakhov (10 sites): Google Alert - coronavirus... |
| And therefore I am greatly humbled to join Nadia's Initiative and the Institute for International Criminal... |
 Disease X-19 from Michael_Novakhov (12 sites) 13h Disease X-19 from Michael_Novakhov (12 sites) 13h |
| Disease X-19 and Security from Michael_Novakhov (10 sites): Google Alert - Coronavirus... |
| But they could provide insight into what's going on during a COVID-19 ... 'America is power:' US Army... |
 Disease X-19 from Michael_Novakhov (12 sites) 13h Disease X-19 from Michael_Novakhov (12 sites) 13h |
| Disease X-19 and Security from Michael_Novakhov (10 sites): Google Alert - coronavirus... |
| The number of new coronavirus cases and deaths reported to the World Health Organization fell for a third... |
 Disease X-19 from Michael_Novakhov (12 sites) 13h Disease X-19 from Michael_Novakhov (12 sites) 13h |
 | The companies making billions from COVID-19 - SupChina |
| The companies making billions from COVID-19 SupChina |
 "Covid-19" - Google News 13h "Covid-19" - Google News 13h |
 | Poloncarz reports jump in Covid-19 cases, but no changes in current virus protocols... |
| Poloncarz reports jump in Covid-19 cases, but no changes in current virus protocols Buffalo News |
 "Covid-19" - Google News 13h "Covid-19" - Google News 13h |
 | State Board of Health votes against requiring COVID-19 vaccinations for schoolchildren... |
| State Board of Health votes against requiring COVID-19 vaccinations for schoolchildren NCWLIFE News |
 "Covid-19" - Google News 13h "Covid-19" - Google News 13h |
 | COVID-19 Statistics | April 13, 2022 - Lost Coast Outpost |
| COVID-19 Statistics | April 13, 2022 Lost Coast Outpost |
 "Covid-19" - Google News 13h "Covid-19" - Google News 13h |
 | COVID-19 UPDATE: Travel Mask Mandate Extended; IDPH No Longer Posting Test Positivity... |
| COVID-19 UPDATE: Travel Mask Mandate Extended; IDPH No Longer Posting Test Positivity Rates; 2060 New... |
 "Covid-19" - Google News 13h "Covid-19" - Google News 13h |
 | No spike in Cuyahoga County COVID-19 cases amid concerns elsewhere over new variant... |
| No spike in Cuyahoga County COVID-19 cases amid concerns elsewhere over new variant cleveland.com |
 "Covid-19" - Google News 13h "Covid-19" - Google News 13h |
 | New COVID-19 nasal spray outperforms current antibody treatments in mice - Northwestern... |
| New COVID-19 nasal spray outperforms current antibody treatments in mice Northwestern Now |
 "Covid-19" - Google News 13h "Covid-19" - Google News 13h |
 | Protecting Children From COVID-19 Had Unintended Negative Consequences - Infection... |
| Protecting Children From COVID-19 Had Unintended Negative Consequences Infection Control Today |
 "Covid-19" - Google News 13h "Covid-19" - Google News 13h |
 | NC officials concerned COVID-19 case count may rise again - WSOC Charlotte |
| NC officials concerned COVID-19 case count may rise again WSOC Charlotte |
 "Covid-19" - Google News 13h "Covid-19" - Google News 13h |
| COVID therapeutics become more available at testing sites - Spectrum News 1 |
| COVID therapeutics become more available at testing sites Spectrum News 1 |
 "coronavirus news" - Google News 13h "coronavirus news" - Google News 13h |
| Connecticut Attorney General Tong tests positive for COVID-19 - theday.com |
| Connecticut Attorney General Tong tests positive for COVID-19 theday.com |
 "coronavirus news" - Google News 13h "coronavirus news" - Google News 13h |
| North Carolina's COVID cases have increased in April - WRAL News |
| North Carolina's COVID cases have increased in April WRAL News |
 "coronavirus news" - Google News 13h "coronavirus news" - Google News 13h |
| Indiana reports 1051 new COVID cases, 8 deaths in past week - WISH TV Indianapolis,... |
| Indiana reports 1051 new COVID cases, 8 deaths in past week WISH TV Indianapolis, IN |
 "coronavirus news" - Google News 13h "coronavirus news" - Google News 13h |
| What is Omicron BA.2? - NBC4 Washington |
| What is Omicron BA.2? NBC4 Washington |
 "Omicron" - Google News 13h "Omicron" - Google News 13h |
 | Washington Board of Health opts against COVID-19 school vaccine requirement - The... |
| Washington Board of Health opts against COVID-19 school vaccine requirement The Columbian |
 "Covid-19" - Google News 14h "Covid-19" - Google News 14h |
| Disease X-19 Regions from Michael_Novakhov (8 sites): Google Alert - Coronavirus... |
| Get insights and coverage of sports from our top editors and reporters. Coronavirus Newsletter. Google... |
 Disease X-19 from Michael_Novakhov (12 sites) 14h Disease X-19 from Michael_Novakhov (12 sites) 14h |
| Disease X-19 Regions from Michael_Novakhov (8 sites): Google Alert - coronavirus... |
| Air travellers wearing protective face masks, amid the coronavirus ... Singapore, Hong Kong, Israel and... |
 Disease X-19 from Michael_Novakhov (12 sites) 14h Disease X-19 from Michael_Novakhov (12 sites) 14h |
| Disease X-19 Regions from Michael_Novakhov (8 sites): Google Alert - coronavirus... |
| The Italian immigration authority has announced that it will be ... COVID-19: Entry requirements for... |
 Disease X-19 from Michael_Novakhov (12 sites) 14h Disease X-19 from Michael_Novakhov (12 sites) 14h |
| Disease X-19 Regions from Michael_Novakhov (8 sites): Google Alert - coronavirus... |
| Hamas, the Islamist group that runs the Gaza strip, then joined in, firing rockets at Israel for 12 days,... |
 Disease X-19 from Michael_Novakhov (12 sites) 14h Disease X-19 from Michael_Novakhov (12 sites) 14h |
| Disease X-19 Regions from Michael_Novakhov (8 sites): Google Alert - Coronavirus... |
| The number of new coronavirus cases and deaths reported to the World Health ... Man wanted in Brooklyn... |
 Disease X-19 from Michael_Novakhov (12 sites) 14h Disease X-19 from Michael_Novakhov (12 sites) 14h |
| Disease X-19 Publications from Michael_Novakhov (5 sites): Google Alert - coronavirus... |
| "My fellow New Yorkers — We got him," said New York City Mayor Eric Adams. ... positive for COVID-19... |
 Disease X-19 from Michael_Novakhov (12 sites) 14h Disease X-19 from Michael_Novakhov (12 sites) 14h |
| Disease X-19 Publications from Michael_Novakhov (5 sites): Google Alert - coronavirus... |
| Dave Sanders for The New York Times ... The shift to remote work that seems poised to outlive the coronavirus... |
 Disease X-19 from Michael_Novakhov (12 sites) 14h Disease X-19 from Michael_Novakhov (12 sites) 14h |
| Disease X-19 Regions from Michael_Novakhov (8 sites): Google Alert - coronavirus... |
| The Israeli military said that during "counterterrorist operations," it faced violent protests in a number... |
 Disease X-19 from Michael_Novakhov (12 sites) 14h Disease X-19 from Michael_Novakhov (12 sites) 14h |
| Disease X-19 Regions from Michael_Novakhov (8 sites): Google Alert - coronavirus... |
| It has been renewed each quarter since and was due to expire on April 16. Italy reports 62,037 coronavirus... |
 Disease X-19 from Michael_Novakhov (12 sites) 14h Disease X-19 from Michael_Novakhov (12 sites) 14h |
| Disease X-19 Regions from Michael_Novakhov (8 sites): Google Alert - coronavirus... |
| A fourth dose of the Pfizer COVID-19 vaccine provided modest protection ... SARS-CoV-2 infection using... |
 Disease X-19 from Michael_Novakhov (12 sites) 14h Disease X-19 from Michael_Novakhov (12 sites) 14h |
| Disease X-19 Regions from Michael_Novakhov (8 sites): Google Alert - coronavirus... |
| Israeli and US scientists say a new analysis shows fourth Covid jabs offer better protection than three... |
 Disease X-19 from Michael_Novakhov (12 sites) 14h Disease X-19 from Michael_Novakhov (12 sites) 14h |
| Disease X-19 Publications from Michael_Novakhov (5 sites): Google Alert - coronavirus... |
| The New York Post ... order has allowed border agents to expel thousands of migrants without hearing... |
 Disease X-19 from Michael_Novakhov (12 sites) 14h Disease X-19 from Michael_Novakhov (12 sites) 14h |
| San Antonio Metro Health monitoring new dominant Omicron subvariant amid rise in... |
| San Antonio Metro Health monitoring new dominant Omicron subvariant amid rise in COVID-19 cases nationally KSAT... |
 "Omicron" - Google News 14h "Omicron" - Google News 14h |
| What do we know about two new versions of Omicron variant spreading in New York -... |
| What do we know about two new versions of Omicron variant spreading in New York The Independent |
 "Omicron" - Google News 14h "Omicron" - Google News 14h |
| Second COVID-19 Pediatric Death Reported - countynewscenter.com |
| Second COVID-19 Pediatric Death Reported countynewscenter.com |
 "coronavirus news" - Google News 14h "coronavirus news" - Google News 14h |
| CDC Extends Travel Mask Requirement to May 3 as COVID Rises - U.S. News & World Report |
| CDC Extends Travel Mask Requirement to May 3 as COVID Rises U.S. News & World Report |
 "coronavirus news" - Google News 14h "coronavirus news" - Google News 14h |
| WEDNESDAY UPDATES: Boone County reports largest single COVID case increase since... |
| WEDNESDAY UPDATES: Boone County reports largest single COVID case increase since Feb. 28 - ABC17NEWS ABC17News.com |
 "coronavirus news" - Google News 14h "coronavirus news" - Google News 14h |
| Erie County now at "medium risk" of COVID transmission - WIVB.com - News 4 |
| Erie County now at "medium risk" of COVID transmission WIVB.com - News 4 |
 "coronavirus news" - Google News 14h "coronavirus news" - Google News 14h |
| Bob Walsmith: Six Things to Do in April For a Worry-Free Summer - Noozhawk |
| Bob Walsmith: Six Things to Do in April For a Worry-Free Summer Noozhawk |
 "Coronavirus in rodents" - Google News 14h "Coronavirus in rodents" - Google News 14h |
 | Groveland Council on Aging to Distribute Free At-Home COVID-19 Tests to Residents... |
| Groveland Council on Aging to Distribute Free At-Home COVID-19 Tests to Residents Aged 60 and Up John... |
 "Covid-19" - Google News 14h "Covid-19" - Google News 14h |
| CDC to shrink COVID-19 international travel avoidance list - wenatcheeworld.com |
| CDC to shrink COVID-19 international travel avoidance list wenatcheeworld.com |
 "Covid-19" - Google News 14h "Covid-19" - Google News 14h |
| Transportation Sales Tax Initiative Relaunched After COVID Delays - Orange County... |
| Transportation Sales Tax Initiative Relaunched After COVID Delays Orange County Government, Florida |
 "COVID" - Google News 14h "COVID" - Google News 14h |
| CDC extends travel mask requirement as COVID rises - KWCH |
| CDC extends travel mask requirement as COVID rises KWCH |
 "COVID" - Google News 14h "COVID" - Google News 14h |
| A million empty spaces: Chronicling COVID's cruel US toll - The Seattle Times |
| A million empty spaces: Chronicling COVID's cruel US toll The Seattle Times |
 "COVID" - Google News 14h "COVID" - Google News 14h |
| Washington DOH Unveils Long-Term COVID Response Plan - Patch |
| Washington DOH Unveils Long-Term COVID Response Plan Patch |
 "COVID" - Google News 14h "COVID" - Google News 14h |
| Low COVID-19 levels in Minnesota dominated by omicron subvariant - Star Tribune |
| Low COVID-19 levels in Minnesota dominated by omicron subvariant Star Tribune |
 "Omicron" - Google News 14h "Omicron" - Google News 14h |
| Disease X-19 Epidemiology from Michael_Novakhov (39 sites): Google Alert - Coronavirus:... |
| The Centers for Disease Control and Prevention said it was extending the ... Severe illnesses and deaths... |
 Disease X-19 from Michael_Novakhov (12 sites) 14h Disease X-19 from Michael_Novakhov (12 sites) 14h |
| Disease X-19 Epidemiology from Michael_Novakhov (39 sites): Google Alert - Coronavirus:... |
| Facebook · Twitter · Email · Coronavirus Pandemic ... Severe illnesses and deaths tend to lag infections... |
 Disease X-19 from Michael_Novakhov (12 sites) 14h Disease X-19 from Michael_Novakhov (12 sites) 14h |
| Disease X-19 Symptoms from Michael_Novakhov (16 sites): Google Alert - coronavirus... |
| New data on cardiac complications linked to COVID-19 show that such ... On admission, chest pain and... |
 Disease X-19 from Michael_Novakhov (12 sites) 14h Disease X-19 from Michael_Novakhov (12 sites) 14h |
| Disease X-19 Epidemiology from Michael_Novakhov (39 sites): Google Alert - Coronavirus... |
| The pet store owner added that many people adopted pets during the pandemic when they were lonely and... |
 Disease X-19 from Michael_Novakhov (12 sites) 14h Disease X-19 from Michael_Novakhov (12 sites) 14h |
| Disease X-19 Symptoms from Michael_Novakhov (16 sites): Google Alert - coronavirus... |
| Chest pain and dyspnoea were the most common symptoms at presentation. None of those included in the... |
 Disease X-19 from Michael_Novakhov (12 sites) 14h Disease X-19 from Michael_Novakhov (12 sites) 14h |
| Disease X-19 Epidemiology from Michael_Novakhov (39 sites): Google Alert - coronavirus... |
| ... health news website STAT reported on Wednesday. ... Here's what you need to know about the coronavirus... |
 Disease X-19 from Michael_Novakhov (12 sites) 14h Disease X-19 from Michael_Novakhov (12 sites) 14h |
| Disease X-19 Epidemiology from Michael_Novakhov (39 sites): Google Alert - Coronavirus... |
| Best women's hooded bathrobe · Best electric tiller · Best fonio flour · Best Funko Pop bobblehead ·... |
 Disease X-19 from Michael_Novakhov (12 sites) 14h Disease X-19 from Michael_Novakhov (12 sites) 14h |
| Disease X-19 Epidemiology from Michael_Novakhov (39 sites): Google Alert - Coronavirus:... |
| Several virologists in India have said that it is not clear that the ... of the covid cases, it doesn't... |
 Disease X-19 from Michael_Novakhov (12 sites) 14h Disease X-19 from Michael_Novakhov (12 sites) 14h |
 | COVID-19 therapy: Better in combination than alone: How a well-known drug can become... |
| COVID-19 therapy: Better in combination than alone: How a well-known drug can become a game changer Science... |
 "Covid-19" - Google News 15h "Covid-19" - Google News 15h |
 | Arizona reports 2,777 COVID-19 cases, 142 deaths in weekly update - The Arizona Republic |
| Arizona reports 2,777 COVID-19 cases, 142 deaths in weekly update The Arizona Republic |
 "Covid-19" - Google News 15h "Covid-19" - Google News 15h |
 | Mask mandate for air travel, public transit extended as COVID-19 cases tick up -... |
| Mask mandate for air travel, public transit extended as COVID-19 cases tick up OregonLive |
 "Covid-19" - Google News 15h "Covid-19" - Google News 15h |
 | BA.2 variant causes slight uptick in Vermont COVID-19 cases. Here's what to know.... |
| BA.2 variant causes slight uptick in Vermont COVID-19 cases. Here's what to know. Burlington Free Press |
 "Covid-19" - Google News 15h "Covid-19" - Google News 15h |
| Here are the latest COVID-19 numbers in Pennsylvania for Wednesday, April 13 - WNEP... |
| Here are the latest COVID-19 numbers in Pennsylvania for Wednesday, April 13 WNEP Scranton/Wilkes-Barre |
 "COVID" - Google News 15h "COVID" - Google News 15h |
| COVID clinics coming to Six Flags England, trampoline parks, zoos next week during... |
| COVID clinics coming to Six Flags England, trampoline parks, zoos next week during school vacation MassLive.com |
 "COVID" - Google News 15h "COVID" - Google News 15h |
| CDC extends travel mask requirement to May 3 as COVID rises - Reading Eagle |
| CDC extends travel mask requirement to May 3 as COVID rises Reading Eagle |
 "COVID" - Google News 15h "COVID" - Google News 15h |
| As U.S. Cases Rise, White House Covid Czar Says It's Not a Moment to be 'Excessively... |
| As U.S. Cases Rise, White House Covid Czar Says It's Not a Moment to be 'Excessively Concerned' The... |
 "COVID" - Google News 15h "COVID" - Google News 15h |
| JCC of Youngstown to host COVID-19 vaccination clinic - Mahoning Matters |
| JCC of Youngstown to host COVID-19 vaccination clinic Mahoning Matters |
 "coronavirus news" - Google News 15h "coronavirus news" - Google News 15h |
| Bipartisan push on mental health crisis that COVID worsened - The Associated Press |
| Bipartisan push on mental health crisis that COVID worsened The Associated Press |
 "coronavirus news" - Google News 15h "coronavirus news" - Google News 15h |
| COVID-19 cases inching up in NH due to 'stealth omicron' variant - The Laconia Daily... |
| COVID-19 cases inching up in NH due to 'stealth omicron' variant The Laconia Daily Sun |
 "Omicron" - Google News 15h "Omicron" - Google News 15h |
| Feral cats have invaded the Oakland Coliseum - The Oaklandside |
| Feral cats have invaded the Oakland Coliseum The Oaklandside |
 "Coronavirus in rodents" - Google News 15h "Coronavirus in rodents" - Google News 15h |
 | COVID-19: Taylor County adds 1 case Wednesday - Abilene Reporter-News |
| COVID-19: Taylor County adds 1 case Wednesday Abilene Reporter-News |
 "COVID-19" - Google News 15h "COVID-19" - Google News 15h |
 | What to know about getting COVID-19-related care covered if you're uninsured in N.H.... |
| What to know about getting COVID-19-related care covered if you're uninsured in N.H. New Hampshire Public... |
 "Covid-19" - Google News 15h "Covid-19" - Google News 15h |
 | Wastewater collection data could help track COVID-19 spread in Tampa - FOX 13 Tampa |
| Wastewater collection data could help track COVID-19 spread in Tampa FOX 13 Tampa |
 "Covid-19" - Google News 15h "Covid-19" - Google News 15h |
 | Alaska no longer top state for new COVID-19 case rate; 1,290 new cases reported in... |
| Alaska no longer top state for new COVID-19 case rate; 1,290 new cases reported in past 7 days Alaska's... |
 "Covid-19" - Google News 15h "Covid-19" - Google News 15h |
| Church leaders give COVID-19 guidelines ahead of Easter - WJBF-TV |
| Church leaders give COVID-19 guidelines ahead of Easter WJBF-TV |
 "Covid-19" - Google News 15h "Covid-19" - Google News 15h |
 | UW-Oshkosh study: What we can learn from COVID-19 response - Spectrum News 1 |
| UW-Oshkosh study: What we can learn from COVID-19 response Spectrum News 1 |
 "Covid-19" - Google News 15h "Covid-19" - Google News 15h |
| How are at-home COVID test results impacting overall case numbers? - WDIV ClickOnDetroit |
| How are at-home COVID test results impacting overall case numbers? WDIV ClickOnDetroit |
 "COVID" - Google News 15h "COVID" - Google News 15h |
| CDC extends travel mask requirement to May 3 as COVID rises - Star Tribune |
| CDC extends travel mask requirement to May 3 as COVID rises Star Tribune |
 "COVID" - Google News 15h "COVID" - Google News 15h |
| How to find COVID-19 anti-viral medication - The Mercury News |
| How to find COVID-19 anti-viral medication The Mercury News |
 "COVID" - Google News 15h "COVID" - Google News 15h |
| Blangiardi tests positive for COVID, is experiencing mild symptoms - Hawaii News... |
| Blangiardi tests positive for COVID, is experiencing mild symptoms Hawaii News Now |
 "COVID" - Google News 15h "COVID" - Google News 15h |
| COVID and Drug Overdoses Contributed to Highest US Death Toll - WebMD |
| COVID and Drug Overdoses Contributed to Highest US Death Toll WebMD |
 "COVID" - Google News 15h "COVID" - Google News 15h |
| Gibson City hospital to receive federal grant for lab equipment - News-Gazette.com |
| Gibson City hospital to receive federal grant for lab equipment News-Gazette.com |
 "coronavirus news" - Google News 15h "coronavirus news" - Google News 15h |
| New top WH COVID official: US at 'better place' with virus - Spectrum News NY1 |
| New top WH COVID official: US at 'better place' with virus Spectrum News NY1 |
 "coronavirus news" - Google News 15h "coronavirus news" - Google News 15h |
| US-NEWS-CORONAVIRUS-EMERGENCY-GET | Public Service News | nny360.com - NNY360 |
| US-NEWS-CORONAVIRUS-EMERGENCY-GET | Public Service News | nny360.com NNY360 |
 "coronavirus news" - Google News 15h "coronavirus news" - Google News 15h |
| Wichita County's COVID new cases flat; Texas cases surge 21.3% - Times Record News |
| Wichita County's COVID new cases flat; Texas cases surge 21.3% Times Record News |
 "coronavirus news" - Google News 15h "coronavirus news" - Google News 15h |
| Global COVID-19 cases reach 500 million - UPI News |
| Global COVID-19 cases reach 500 million UPI News |
 "coronavirus news" - Google News 15h "coronavirus news" - Google News 15h |
| Omicron XE symptoms: How do you know if you're at risk? - Deseret News |
| Omicron XE symptoms: How do you know if you're at risk? Deseret News |
 "Omicron" - Google News 15h "Omicron" - Google News 15h |
| Swiss to unfreeze $430M as Egypt money laundering probe ends - Yahoo! Voices |
| Swiss to unfreeze $430M as Egypt money laundering probe ends Yahoo! Voices |
 "aggressive squirrels in new york city" - Google News 15h "aggressive squirrels in new york city" - Google News 15h |
| Disease X-19 Epidemiology from Michael_Novakhov (39 sites): Google Alert - coronavirus... |
| Antiviral drugs must be used early in an infection to reduce disease outcomes. At present, to receive... |
 Disease X-19 from Michael_Novakhov (12 sites) 15h Disease X-19 from Michael_Novakhov (12 sites) 15h |
| Disease X-19 Epidemiology from Michael_Novakhov (39 sites): Google Alert - coronavirus... |
| State public health officials reported 1 new confirmed death and 1969 new confirmed COVID-19 cases in... |
 Disease X-19 from Michael_Novakhov (12 sites) 15h Disease X-19 from Michael_Novakhov (12 sites) 15h |
| Disease X-19 Epidemiology from Michael_Novakhov (39 sites): Google Alert - coronavirus... |
| CLEVELAND, Ohio — Rising COVID-19 case rates are causing concern in parts of the United States, but not... |
 Disease X-19 from Michael_Novakhov (12 sites) 15h Disease X-19 from Michael_Novakhov (12 sites) 15h |
| Disease X-19 Epidemiology from Michael_Novakhov (39 sites): Google Alert - coronavirus... |
| A woman took a Covid-19 test in Beijing this week as China battled an outbreak. Photo: mark r cristino/Shutterstock.... |
 Disease X-19 from Michael_Novakhov (12 sites) 15h Disease X-19 from Michael_Novakhov (12 sites) 15h |
| Disease X-19 Epidemiology from Michael_Novakhov (39 sites): Google Alert - coronavirus... |
| People play with water as they celebrate during the Songkran holiday which marks the Thai New Year during... |
 Disease X-19 from Michael_Novakhov (12 sites) 15h Disease X-19 from Michael_Novakhov (12 sites) 15h |
| Disease X-19 Epidemiology from Michael_Novakhov (39 sites): Google Alert - coronavirus... |
| The appeals court said orders by the state and Orange County to try to prevent the spread of COVID-19... |
 Disease X-19 from Michael_Novakhov (12 sites) 15h Disease X-19 from Michael_Novakhov (12 sites) 15h |
| Disease X-19 Epidemiology from Michael_Novakhov (39 sites): Google Alert - coronavirus... |
| ... two-dose, prospective, placebo-controlled trial of its Covid-19 messenger RNA (mRNA) vaccine, BNT162b2,... |
 Disease X-19 from Michael_Novakhov (12 sites) 15h Disease X-19 from Michael_Novakhov (12 sites) 15h |
| Disease X-19 Epidemiology from Michael_Novakhov (39 sites): Google Alert - coronavirus... |
| "We know that natural immunity from infection and immunity from vaccination against coronaviruses wanes... |
 Disease X-19 from Michael_Novakhov (12 sites) 15h Disease X-19 from Michael_Novakhov (12 sites) 15h |
| Disease X-19 Epidemiology from Michael_Novakhov (39 sites): Google Alert - coronavirus... |
| Neighbors part of the Elgin Oaks subdivision are under a boil water notice, ... KXAN is tracking COVID-19... |
 Disease X-19 from Michael_Novakhov (12 sites) 15h Disease X-19 from Michael_Novakhov (12 sites) 15h |
| Disease X-19 Epidemiology from Michael_Novakhov (39 sites): Google Alert - coronavirus... |
| HARRISONBURG, Va. (WHSV) - Masonry work to repair the damaged side of the Water Street parking deck will... |
 Disease X-19 from Michael_Novakhov (12 sites) 15h Disease X-19 from Michael_Novakhov (12 sites) 15h |
| Disease X-19 Regions from Michael_Novakhov (8 sites): Google Alert - coronavirus... |
| For example, as soon as the military confrontations began, the Israeli Minister of Immigration Pnina... |
 Disease X-19 from Michael_Novakhov (12 sites) 15h Disease X-19 from Michael_Novakhov (12 sites) 15h |
| Disease X-19 Regions from Michael_Novakhov (8 sites): Google Alert - coronavirus... |
| ... Italy), in a press release. The researchers note that the reported prevalence of definite/probable... |
 Disease X-19 from Michael_Novakhov (12 sites) 15h Disease X-19 from Michael_Novakhov (12 sites) 15h |
| Disease X-19 Regions from Michael_Novakhov (8 sites): Google Alert - coronavirus... |
| Report: Jordan's King Abdullah made the proposal to Israeli President Isaac Herzog during a meeting in... |
 Disease X-19 from Michael_Novakhov (12 sites) 15h Disease X-19 from Michael_Novakhov (12 sites) 15h |
| Disease X-19 Regions from Michael_Novakhov (8 sites): Google Alert - Coronavirus... |
| Russia warns of striking Kyiv if Ukraine continues attacks on Russian territory · Delhi sees 299 new... |
 Disease X-19 from Michael_Novakhov (12 sites) 15h Disease X-19 from Michael_Novakhov (12 sites) 15h |
| Disease X-19 Regions from Michael_Novakhov (8 sites): Google Alert - coronavirus... |
| JERUSALEM (AP) — Israeli forces shot and killed a Palestinian man during clashes on... Google Alert... |
 Disease X-19 from Michael_Novakhov (12 sites) 15h Disease X-19 from Michael_Novakhov (12 sites) 15h |
| Disease X-19 Regions from Michael_Novakhov (8 sites): Google Alert - coronavirus... |
| A member of Israel's Prime Minister Naftali Bennett's right-wing Yamina party, Amichai Chikli, attempted... |
 Disease X-19 from Michael_Novakhov (12 sites) 15h Disease X-19 from Michael_Novakhov (12 sites) 15h |
| Disease X-19 Regions from Michael_Novakhov (8 sites): Google Alert - coronavirus... |
| The Philippine consulate in Milan keeps the community posted about the delay in arrival of election materials.... |
 Disease X-19 from Michael_Novakhov (12 sites) 15h Disease X-19 from Michael_Novakhov (12 sites) 15h |
| Disease X-19 Regions from Michael_Novakhov (8 sites): Google Alert - Coronavirus... |
| Man Wanted in Brooklyn Subway Attack Arrested ... The photo shows the hood of a blue ambulance. Car Hits... |
 Disease X-19 from Michael_Novakhov (12 sites) 15h Disease X-19 from Michael_Novakhov (12 sites) 15h |
| Disease X-19 Regions from Michael_Novakhov (8 sites): Google Alert - Coronavirus... |
| Coronavirus Home Test (Circle Creative Studio/Getty Images) ... Many of us are using those at-home rapid... |
 Disease X-19 from Michael_Novakhov (12 sites) 15h Disease X-19 from Michael_Novakhov (12 sites) 15h |
 | Fourth Dose of BNT162b2 mRNA Covid-19 Vaccine in a Nationwide Setting |
| submitted by /u/icloudbug [link] [comments] |
| |
 | Covid-19 Boosters — Where from Here? |
| submitted by /u/icloudbug [link] [comments] |
| |
| Seamore's plans first expansion outside New York City - Nation's Restaurant News |
| Seamore's plans first expansion outside New York City Nation's Restaurant News |
 "Coronavirus in fish and seafood" - Google News 16h "Coronavirus in fish and seafood" - Google News 16h |
 | Active COVID-19 cases dip in Ulster, Dutchess counties - The Daily Freeman |
| Active COVID-19 cases dip in Ulster, Dutchess counties The Daily Freeman |
 "Covid-19" - Google News 16h "Covid-19" - Google News 16h |
| NEW: Clark County reports 356 COVID-19 deaths as it resolves backlog, 'data review'... |
| NEW: Clark County reports 356 COVID-19 deaths as it resolves backlog, 'data review' KLAS - 8 News Now |
 "Covid-19" - Google News 16h "Covid-19" - Google News 16h |
| Vaccinated Honolulu Mayor Tests Positive for COVID-19 | Hawaii News | US News - U.S.... |
| Vaccinated Honolulu Mayor Tests Positive for COVID-19 | Hawaii News | US News U.S. News & World... |
 "Covid-19" - Google News 16h "Covid-19" - Google News 16h |
| COVID-19 in NC: 1st weekly update shows uptick in cases, drop to 2-year low hospitalizations... |
| COVID-19 in NC: 1st weekly update shows uptick in cases, drop to 2-year low hospitalizations CBS17.com |
 "Covid-19" - Google News 16h "Covid-19" - Google News 16h |
 | COVID-19 Beliefs Are Influenced by Politicians, Not Scientists, Researchers Suggest... |
| COVID-19 Beliefs Are Influenced by Politicians, Not Scientists, Researchers Suggest Newswise |
 "Covid-19" - Google News 16h "Covid-19" - Google News 16h |
 | Gout Increases Risk of COVID-19-Related Death in Women - Rheumatology Network |
| Gout Increases Risk of COVID-19-Related Death in Women Rheumatology Network |
 "Covid-19" - Google News 16h "Covid-19" - Google News 16h |
| COVID hospitalizations in Texas at lowest total since records begin - KXAN.com |
| COVID hospitalizations in Texas at lowest total since records begin KXAN.com |
 "coronavirus news" - Google News 16h "coronavirus news" - Google News 16h |
| Alabama health officer tests positive for COVID-19 - The Associated Press - en Español |
| Alabama health officer tests positive for COVID-19 The Associated Press - en Español |
 "coronavirus news" - Google News 16h "coronavirus news" - Google News 16h |
| CDC extends travel mask requirement to May 3 as COVID rises - News-Gazette.com |
| CDC extends travel mask requirement to May 3 as COVID rises News-Gazette.com |
 "coronavirus news" - Google News 16h "coronavirus news" - Google News 16h |
| COVID Cases Reach 500 Million Worldwide - Consumer Health News | HealthDay - HealthDay... |
| COVID Cases Reach 500 Million Worldwide - Consumer Health News | HealthDay HealthDay News |
 "coronavirus news" - Google News 16h "coronavirus news" - Google News 16h |
| RI leads nation in COVID case growth. Here's why officials aren't worried yet - The... |
| RI leads nation in COVID case growth. Here's why officials aren't worried yet The Providence Journal |
 "COVID" - Google News 16h "COVID" - Google News 16h |
| State releases weekly data for new COVID infections, deaths - Hawaii News Now |
| State releases weekly data for new COVID infections, deaths Hawaii News Now |
 "COVID" - Google News 16h "COVID" - Google News 16h |
| Vermont long-term care facilities still struggling with COVID outbreaks - WCAX |
| Vermont long-term care facilities still struggling with COVID outbreaks WCAX |
 "COVID" - Google News 16h "COVID" - Google News 16h |
| Federal CDC extends travel mask requirement to May 3 as COVID cases rise - Press... |
| Federal CDC extends travel mask requirement to May 3 as COVID cases rise Press Herald |
 "COVID" - Google News 16h "COVID" - Google News 16h |
| Has omicron XE arrived in California? Here's what we know about the new coronavirus... |
| Has omicron XE arrived in California? Here's what we know about the new coronavirus subvariant San Francisco... |
 "Omicron" - Google News 16h "Omicron" - Google News 16h |
| Disease X-19 Publications from Michael_Novakhov (5 sites): Google Alert - new york... |
| 1 of 2 | Children and their caregivers arrive for school in New York on March 7. The Biden... (AP Photo/Seth... |
 Disease X-19 from Michael_Novakhov (12 sites) 16h Disease X-19 from Michael_Novakhov (12 sites) 16h |
| Disease X-19 General Issues from Michael_Novakhov (5 sites): Google Alert - sars... |
| The researchers produced nanoMIPs (molecularly imprinted polymer nanoparticles) against a fragment of... |
 Disease X-19 from Michael_Novakhov (12 sites) 16h Disease X-19 from Michael_Novakhov (12 sites) 16h |
| Disease X-19 General Issues from Michael_Novakhov (5 sites): Google Alert - sars... |
| COVID-19 diagnosis was defined as those with a positive SARS-CoV-2 test or ICD-10 code for confirmed... |
 Disease X-19 from Michael_Novakhov (12 sites) 16h Disease X-19 from Michael_Novakhov (12 sites) 16h |
| Disease X-19 Publications from Michael_Novakhov (5 sites): Google Alert - new york... |
| On the deadliest day of a horrific week in April 2020, COVID took the lives of 816 people in New York... |
 Disease X-19 from Michael_Novakhov (12 sites) 16h Disease X-19 from Michael_Novakhov (12 sites) 16h |
| Disease X-19 Publications from Michael_Novakhov (5 sites): Google Alert - new york... |
| ... than 85% of new coronavirus cases in the United States — was cited by the CDC as the reason for the... |
 Disease X-19 from Michael_Novakhov (12 sites) 16h Disease X-19 from Michael_Novakhov (12 sites) 16h |
| Disease X-19 General Issues from Michael_Novakhov (5 sites): Google Alert - sars... |
| The following is a summary of newly reported data on COVID-19 in ... 2022, negative rapid antigen and... |
 Disease X-19 from Michael_Novakhov (12 sites) 16h Disease X-19 from Michael_Novakhov (12 sites) 16h |
 | Expansion of L452R-Positive SARS-CoV-2 Omicron Variant, Northern Lombardy, Italy |
| submitted by /u/Peeecee7896 [link] [comments] |
| |
| Multivalent designed proteins neutralize SARS-CoV-2 variants of concern and confer... |
| submitted by /u/JaneSteinberg [link] [comments] |
| |
| Effectiveness of COVID-19 vaccines against hospitalization and death in Canada: A... |
| Background: A major goal of COVID-19 vaccination is to prevent severe outcomes (hospitalizations and... |
 bioRxiv Channel: COVID-19 SARS-CoV-2 preprints from medRxiv and bioRxiv 16h bioRxiv Channel: COVID-19 SARS-CoV-2 preprints from medRxiv and bioRxiv 16h |
 | How to find COVID-19 anti-viral medication - The Mercury News |
| How to find COVID-19 anti-viral medication The Mercury News |
 "Covid-19" - Google News 16h "Covid-19" - Google News 16h |
| Massachusetts COVID-19 Daily Report: 1 new death, 1,969 new cases - WWLP.com |
| Massachusetts COVID-19 Daily Report: 1 new death, 1,969 new cases WWLP.com |
 "Covid-19" - Google News 16h "Covid-19" - Google News 16h |
 | Rising again: Dane Co. very close to 'Very High' COVID-19 case activity - WMTV –... |
| Rising again: Dane Co. very close to 'Very High' COVID-19 case activity WMTV – NBC15 |
 "Covid-19" - Google News 16h "Covid-19" - Google News 16h |
 | Hidalgo County reports 2 coronavirus-related deaths, 101 cases of COVID-19 - KRGV |
| Hidalgo County reports 2 coronavirus-related deaths, 101 cases of COVID-19 KRGV |
 "Covid-19" - Google News 16h "Covid-19" - Google News 16h |
 | Myocarditis in Unvaxxed Patients Hospitalized With COVID-19: New Insights - TCTMD |
| Myocarditis in Unvaxxed Patients Hospitalized With COVID-19: New Insights TCTMD |
 "Covid-19" - Google News 16h "Covid-19" - Google News 16h |
 | Ingleside ISD purchases two UV-C light machines to help fight COVID-19, viruses -... |
| Ingleside ISD purchases two UV-C light machines to help fight COVID-19, viruses Caller Times |
 "Covid-19" - Google News 16h "Covid-19" - Google News 16h |
 | Desert Pain helps COVID-19 survivors recover sense of taste, smell with nerve injections... |
| Desert Pain helps COVID-19 survivors recover sense of taste, smell with nerve injections St George News |
 "Covid-19" - Google News 16h "Covid-19" - Google News 16h |
 | COVID-19: CDC extends coronavirus travel mask mandate to May 3 - KIRO Seattle |
| COVID-19: CDC extends coronavirus travel mask mandate to May 3 KIRO Seattle |
 "Covid-19" - Google News 16h "Covid-19" - Google News 16h |
 | Gilbert Gottfried didn't die from the COVID-19 vaccine - PolitiFact |
| Gilbert Gottfried didn't die from the COVID-19 vaccine PolitiFact |
 "Covid-19" - Google News 16h "Covid-19" - Google News 16h |
 | China is shutting down Shanghai in two phases to control Covid - CNBC |
| China is shutting down Shanghai in two phases to control Covid CNBC |
 "Covid-19" - Google News 16h "Covid-19" - Google News 16h |
| Midland COVID transmission remains slow despite spring break - Midland Daily News |
| Midland COVID transmission remains slow despite spring break Midland Daily News |
 "coronavirus news" - Google News 16h "coronavirus news" - Google News 16h |
| CDC extends travel mask requirement to May 3 as COVID rises - WISH TV Indianapolis,... |
| CDC extends travel mask requirement to May 3 as COVID rises WISH TV Indianapolis, IN |
 "coronavirus news" - Google News 16h "coronavirus news" - Google News 16h |
| Fourth Dose of BNT162b2 mRNA Covid-19 Vaccine in a Nationwide Setting | NEJM - nejm.org |
| Fourth Dose of BNT162b2 mRNA Covid-19 Vaccine in a Nationwide Setting | NEJM nejm.org |
 "COVID" - Google News 16h "COVID" - Google News 16h |
| Covid-19 Boosters — Where from Here? | NEJM - nejm.org |
| Covid-19 Boosters — Where from Here? | NEJM nejm.org |
 "COVID" - Google News 16h "COVID" - Google News 16h |
| Will Easter, Passover and Eid gatherings spur COVID spike in NJ? Here's what models... |
| Will Easter, Passover and Eid gatherings spur COVID spike in NJ? Here's what models show NorthJersey.com |
 "COVID" - Google News 16h "COVID" - Google News 16h |
| As Lamont exits quarantine, attorney general tests positive and COVID case rate rises... |
| As Lamont exits quarantine, attorney general tests positive and COVID case rate rises in CT CT Insider |
 "COVID" - Google News 16h "COVID" - Google News 16h |
| As COVID Cases Surge in NYC, Some Museums Are Lifting Their Mask Mandates - Hyperallergic |
| As COVID Cases Surge in NYC, Some Museums Are Lifting Their Mask Mandates Hyperallergic |
 "COVID" - Google News 16h "COVID" - Google News 16h |
| CDC extends travel mask requirement as COVID rises - KNOP |
| CDC extends travel mask requirement as COVID rises KNOP |
 "COVID" - Google News 16h "COVID" - Google News 16h |
| Disease X-19 Epidemiology from Michael_Novakhov (39 sites): Google Alert - coronavirus... |
| The new Minnesota Public Health Corps is looking for 150 Minnesotans to work for a year in local public... |
 Disease X-19 from Michael_Novakhov (12 sites) 16h Disease X-19 from Michael_Novakhov (12 sites) 16h |
| Disease X-19 Epidemiology from Michael_Novakhov (39 sites): Google Alert - coronavirus... |
| The number of outbreaks notified last week fell in nursing homes, hospitals and other residential care... |
 Disease X-19 from Michael_Novakhov (12 sites) 16h Disease X-19 from Michael_Novakhov (12 sites) 16h |
| Disease X-19 Epidemiology from Michael_Novakhov (39 sites): Google Alert - coronavirus... |
| COVID-19 will soon claim a million American lives. ... The following day, heading home after getting... |
 Disease X-19 from Michael_Novakhov (12 sites) 16h Disease X-19 from Michael_Novakhov (12 sites) 16h |
| Disease X-19 Epidemiology from Michael_Novakhov (39 sites): Google Alert - Covid-19:... |
| How Covid 19 Affected the BRCA1 & BRCA2 Gene Testing Market ... restraining factors that will define... |
 Disease X-19 from Michael_Novakhov (12 sites) 16h Disease X-19 from Michael_Novakhov (12 sites) 16h |
| Disease X-19 Epidemiology from Michael_Novakhov (39 sites): Google Alert - coronavirus... |
| The public health emergency was initially declared in January 2020, when the coronavirus pandemic began.... |
 Disease X-19 from Michael_Novakhov (12 sites) 16h Disease X-19 from Michael_Novakhov (12 sites) 16h |
| Disease X-19 Epidemiology from Michael_Novakhov (39 sites): Google Alert - Covid-19:... |
| A person's immunity to COVID-19 is influenced by multiple factors and ... better antibodies … and we... |
 Disease X-19 from Michael_Novakhov (12 sites) 16h Disease X-19 from Michael_Novakhov (12 sites) 16h |
| Disease X-19 Epidemiology from Michael_Novakhov (39 sites): Google Alert - Covid-19:... |
| Depression is influenced more by environmental factors than genetic ones, said a study conducted in Sri... |
 Disease X-19 from Michael_Novakhov (12 sites) 16h Disease X-19 from Michael_Novakhov (12 sites) 16h |
| Disease X-19 Epidemiology from Michael_Novakhov (39 sites): Google Alert - coronavirus... |
| The country is in a good place in the pandemic, but we should prepare for an unpredictable future, according... |
 Disease X-19 from Michael_Novakhov (12 sites) 16h Disease X-19 from Michael_Novakhov (12 sites) 16h |
| Disease X-19 Epidemiology from Michael_Novakhov (39 sites): Google Alert - coronavirus... |
| Noting that "pandemic fatigue'' has hit many area residents and politicians now that the virus is in... |
 Disease X-19 from Michael_Novakhov (12 sites) 16h Disease X-19 from Michael_Novakhov (12 sites) 16h |
| Disease X-19 Epidemiology from Michael_Novakhov (39 sites): Google Alert - coronavirus... |
| "Modeling the Probability of COVID-19 Based on Symptom Screening and Prevalence of Influenza and Influenza-Like... |
 Disease X-19 from Michael_Novakhov (12 sites) 16h Disease X-19 from Michael_Novakhov (12 sites) 16h |
| Disease X-19 and Security from Michael_Novakhov (10 sites): Google Alert - Coronavirus... |
| ... the residents of New York City and the surrounding tri-state area to honor the U.S. Navy (USN), Marine... |
 Disease X-19 from Michael_Novakhov (12 sites) 16h Disease X-19 from Michael_Novakhov (12 sites) 16h |
| Disease X-19 and Security from Michael_Novakhov (10 sites): Google Alert - Coronavirus... |
| The new task force will target smugglers in the Red Sea, a vital shipping lane [US Naval Forces Central... |
 Disease X-19 from Michael_Novakhov (12 sites) 16h Disease X-19 from Michael_Novakhov (12 sites) 16h |
| Disease X-19 and Security from Michael_Novakhov (10 sites): Google Alert - Coronavirus... |
| Scroll within to view all topics. Afghanistan · Congressional Oversight · Coronavirus · Counterterrorism... |
 Disease X-19 from Michael_Novakhov (12 sites) 16h Disease X-19 from Michael_Novakhov (12 sites) 16h |
| Disease X-19 and Security from Michael_Novakhov (10 sites): Google Alert - Coronavirus... |
| As the U.S. Navy gears up for 5G, a number of pilots are underway to evaluate the risks that come with... |
 Disease X-19 from Michael_Novakhov (12 sites) 16h Disease X-19 from Michael_Novakhov (12 sites) 16h |
| Disease X-19 and Security from Michael_Novakhov (10 sites): Google Alert - Coronavirus... |
| "Routine bilateral operations like this one reassure our allies and partners of the U.S. commitment to... |
 Disease X-19 from Michael_Novakhov (12 sites) 16h Disease X-19 from Michael_Novakhov (12 sites) 16h |
| Disease X-19 and Security from Michael_Novakhov (10 sites): Google Alert - Coronavirus... |
| After two years of pandemic living, Americans are collectively ready for a vacation. About 85% of people... |
 Disease X-19 from Michael_Novakhov (12 sites) 16h Disease X-19 from Michael_Novakhov (12 sites) 16h |
| Disease X-19 and Security from Michael_Novakhov (10 sites): Google Alert - Coronavirus... |
| COVID-19: Complete Coverage · Vaccine Information ... who led them to join a far-reaching criminal conspiracy... |
 Disease X-19 from Michael_Novakhov (12 sites) 16h Disease X-19 from Michael_Novakhov (12 sites) 16h |
| Health behaviours the month prior to COVID-19 infection and the development of self-reported... |
| Abstract Background Demographic and infection-related characteristics have been identified as risk factors... |
 bioRxiv Channel: COVID-19 SARS-CoV-2 preprints from medRxiv and bioRxiv 17h bioRxiv Channel: COVID-19 SARS-CoV-2 preprints from medRxiv and bioRxiv 17h |
| Different HMGCR-inhibiting statins vary in their association with increased survival... |
| Background In response to the challenge to rapidly identify treatment options for COVID-19, several studies... |
 bioRxiv Channel: COVID-19 SARS-CoV-2 preprints from medRxiv and bioRxiv 17h bioRxiv Channel: COVID-19 SARS-CoV-2 preprints from medRxiv and bioRxiv 17h |
| Multiplex RT-qPCR assay (N200) to detect and estimate prevalence of multiple SARS-CoV-2... |
| Wastewater-based surveillance (WBS) has become an effective tool around the globe for indirect monitoring... |
 bioRxiv Channel: COVID-19 SARS-CoV-2 preprints from medRxiv and bioRxiv 17h bioRxiv Channel: COVID-19 SARS-CoV-2 preprints from medRxiv and bioRxiv 17h |
| Health Economic Burden of COVID-19 in Saudi Arabia |
| Background: The coronavirus disease 2019 (COVID-19) pandemic has placed a massive economic burden on... |
 bioRxiv Channel: COVID-19 SARS-CoV-2 preprints from medRxiv and bioRxiv 17h bioRxiv Channel: COVID-19 SARS-CoV-2 preprints from medRxiv and bioRxiv 17h |
| Nowcasting and Forecasting COVID-19 Waves: The Recursive and Stochastic Nature of... |
| We propose a parsimonious, yet effective, susceptible-exposed-infected-removed-type model that incorporates... |
 bioRxiv Channel: COVID-19 SARS-CoV-2 preprints from medRxiv and bioRxiv 17h bioRxiv Channel: COVID-19 SARS-CoV-2 preprints from medRxiv and bioRxiv 17h |
| Slight increase in fomite route transmission risk of SARS-CoV-2 Omicron variant compared... |
| The Omicron SARS-CoV-2 variant has become the dominant lineage worldwide, and experimental study had... |
 bioRxiv Channel: COVID-19 SARS-CoV-2 preprints from medRxiv and bioRxiv 17h bioRxiv Channel: COVID-19 SARS-CoV-2 preprints from medRxiv and bioRxiv 17h |
| With Shanghai at a standstill, supply chain problems are compounding - Supply Chain... |
| With Shanghai at a standstill, supply chain problems are compounding Supply Chain Dive |
 "Coronavirus in meat plants" - Google News 17h "Coronavirus in meat plants" - Google News 17h |
 | COVID-19 loss of smell may be caused by inflammation, says new study - SILive.com |
| COVID-19 loss of smell may be caused by inflammation, says new study SILive.com |
 "Covid-19" - Google News 17h "Covid-19" - Google News 17h |
 | BA.2 variant not effecting BRHD COVID-19 Strategy - - CBS19 News |
| BA.2 variant not effecting BRHD COVID-19 Strategy - CBS19 News |
 "Covid-19" - Google News 17h "Covid-19" - Google News 17h |
| One Day Longer. One Day Stronger. One Year Later. - The Real News Network |
| One Day Longer. One Day Stronger. One Year Later. The Real News Network |
 "aggressive rats in new york city" - Google News 17h "aggressive rats in new york city" - Google News 17h |
| Before she was Tampa's police chief, Mary O'Connor oversaw two racially-biased programs,... |
| Before she was Tampa's police chief, Mary O'Connor oversaw two racially-biased programs, files show Creative... |
 "aggressive rats in new york city" - Google News 17h "aggressive rats in new york city" - Google News 17h |
| Department of Health | News | Governor Murphy Signs Executive Order Clarifying COVID-19... |
| Department of Health | News | Governor Murphy Signs Executive Order Clarifying COVID-19 Vaccine Requirements... |
 "coronavirus news" - Google News 17h "coronavirus news" - Google News 17h |
| Alabama Health Officer Tests Positive for COVID-19 - U.S. News & World Report |
| Alabama Health Officer Tests Positive for COVID-19 U.S. News & World Report |
 "coronavirus news" - Google News 17h "coronavirus news" - Google News 17h |
| Maine schools will end pooled coronavirus testing next month - Bangor Daily News |
| Maine schools will end pooled coronavirus testing next month Bangor Daily News |
 "coronavirus news" - Google News 17h "coronavirus news" - Google News 17h |
| Jenna Bush Hager Misses 'Today' After She Tested Positive For Covid - Deadline |
| Jenna Bush Hager Misses 'Today' After She Tested Positive For Covid Deadline |
 "COVID" - Google News 17h "COVID" - Google News 17h |
| Layered controls can significantly curb exposure to COVID-19: Mechanistic modeling... |
| Layered controls can significantly curb exposure to COVID-19: Mechanistic modeling study shows the combination... |
 "COVID" - Google News 17h "COVID" - Google News 17h |
| Pfizer May Have Omicron-Optimized Covid Vaccine Ready By Fall, CEO Says - Forbes |
| Pfizer May Have Omicron-Optimized Covid Vaccine Ready By Fall, CEO Says Forbes |
 "Omicron" - Google News 17h "Omicron" - Google News 17h |
| McMahon: Many CNY COVID-19 cases are subvariant of omicron - Spectrum News |
| McMahon: Many CNY COVID-19 cases are subvariant of omicron Spectrum News |
 "Omicron" - Google News 17h "Omicron" - Google News 17h |
| Protection conferred by vaccine plus previous infection (hybrid immunity) with vaccines... |
| Hybrid immunity (infection plus vaccination) provided high protection against infection and severe disease... |
 bioRxiv Channel: COVID-19 SARS-CoV-2 preprints from medRxiv and bioRxiv 17h bioRxiv Channel: COVID-19 SARS-CoV-2 preprints from medRxiv and bioRxiv 17h |
| Office of the Governor | Governor Murphy Signs Executive Order Clarifying COVID-19... |
| Office of the Governor | Governor Murphy Signs Executive Order Clarifying COVID-19 Vaccine Requirements... |
 "COVID-19" - Google News 17h "COVID-19" - Google News 17h |
 | AI can predict probability of COVID-19 vs flu based on symptoms - Science Daily |
| AI can predict probability of COVID-19 vs flu based on symptoms Science Daily |
 "COVID-19" - Google News 17h "COVID-19" - Google News 17h |
 | COW CREEK PUBLIC HEALTH OFFERING COVID-19 VACCINES AND BOOSTERS - kqennewsradio.com |
| COW CREEK PUBLIC HEALTH OFFERING COVID-19 VACCINES AND BOOSTERS kqennewsradio.com |
 "COVID-19" - Google News 17h "COVID-19" - Google News 17h |
| Warren County COVID-19 update for April 13 - NEWS10 ABC |
| Warren County COVID-19 update for April 13 NEWS10 ABC |
 "coronavirus news" - Google News 17h "coronavirus news" - Google News 17h |
| Actor Cuba Gooding Jr pleads guilty to forcible touching - News-Gazette.com |
| Actor Cuba Gooding Jr pleads guilty to forcible touching News-Gazette.com |
 "coronavirus news" - Google News 17h "coronavirus news" - Google News 17h |
| More Taiwan Firms Suspend Production in China as COVID Spreads - U.S. News & World... |
| More Taiwan Firms Suspend Production in China as COVID Spreads U.S. News & World Report |
 "coronavirus news" - Google News 17h "coronavirus news" - Google News 17h |
| A million empty spaces: Chronicling COVID's cruel U.S. death toll - Tampa Bay Times |
| A million empty spaces: Chronicling COVID's cruel U.S. death toll Tampa Bay Times |
 "COVID" - Google News 17h "COVID" - Google News 17h |
| Alabama State Health Officer Scott Harris tests positive for COVID-19 - Montgomery... |
| Alabama State Health Officer Scott Harris tests positive for COVID-19 Montgomery Advertiser |
 "COVID" - Google News 17h "COVID" - Google News 17h |
 | Covid 19 Omicron: Orange day dawns after curve flattened and return to office looms... |
| Covid 19 Omicron: Orange day dawns after curve flattened and return to office looms for many New Zealand... |
 "Omicron" - Google News 17h "Omicron" - Google News 17h |
 | South Korea finds first case of Omicron's newer version, XL - INQUIRER.net |
| South Korea finds first case of Omicron's newer version, XL INQUIRER.net |
 "Omicron" - Google News 17h "Omicron" - Google News 17h |
| Disease X-19 Regions from Michael_Novakhov (8 sites): Google Alert - coronavirus... |
| Madagascar, Mozambique, Malawi and Zimbabwe in southeast Africa were hit by devastating cyclones, affecting... |
 Disease X-19 from Michael_Novakhov (12 sites) 17h Disease X-19 from Michael_Novakhov (12 sites) 17h |
| Disease X-19 Regions from Michael_Novakhov (8 sites): Google Alert - coronavirus... |
| JOHANNESBURG (AP) — Flooding in South Africa's Durban area has taken at least 259 ... CDC extends travel... |
 Disease X-19 from Michael_Novakhov (12 sites) 17h Disease X-19 from Michael_Novakhov (12 sites) 17h |
| Disease X-19 Regions from Michael_Novakhov (8 sites): Google Alert - coronavirus... |
| As the Johns Hopkins University tracker tops half a billion covid ... resources and a lack of coronavirus... |
 Disease X-19 from Michael_Novakhov (12 sites) 17h Disease X-19 from Michael_Novakhov (12 sites) 17h |
| Disease X-19 Regions from Michael_Novakhov (8 sites): Google Alert - coronavirus... |
| US COVID deaths exceed WWII fatalities as Biden warns worst yet to come · Press TV News Roku. News. Iran... |
 Disease X-19 from Michael_Novakhov (12 sites) 17h Disease X-19 from Michael_Novakhov (12 sites) 17h |
| Disease X-19 Regions from Michael_Novakhov (8 sites): Google Alert - coronavirus... |
| The Code of Practice for Managing Exposure to Sars-CoV-2 in the Workplace 2022 ("COVID Code") will take... |
 Disease X-19 from Michael_Novakhov (12 sites) 17h Disease X-19 from Michael_Novakhov (12 sites) 17h |
| Disease X-19 Regions from Michael_Novakhov (8 sites): Google Alert - coronavirus... |
| Every day, Iranian cities witnessed protests by deprived people from all ... have lost their lives since... |
 Disease X-19 from Michael_Novakhov (12 sites) 17h Disease X-19 from Michael_Novakhov (12 sites) 17h |
 | Effectiveness of the BNT162b vaccine fourth dose in reducing SARS-CoV-2 infection... |
| submitted by /u/icloudbug [link] [comments] |
| |
| Effectiveness of the BNT162b vaccine fourth dose in reducing SARS-CoV-2 infection... |
| Abstract During December 2021 the fifth COVID-19 wave started in Israel, caused mostly by the Omicron... |
 bioRxiv Channel: COVID-19 SARS-CoV-2 preprints from medRxiv and bioRxiv 18h bioRxiv Channel: COVID-19 SARS-CoV-2 preprints from medRxiv and bioRxiv 18h |
 | Monroe County COVID-19 cases continue to increase daily - Spectrum News |
| Monroe County COVID-19 cases continue to increase daily Spectrum News |
 "Covid-19" - Google News 18h "Covid-19" - Google News 18h |
| 04-13-22 Weekly Summary of COVID-19 Activity in Lewis County - Lewis County |
| 04-13-22 Weekly Summary of COVID-19 Activity in Lewis County Lewis County |
 "COVID-19" - Google News 18h "COVID-19" - Google News 18h |
| Baker-Polito administration encourages COVID-19 vaccination and boosters at family-friendly... |
| Baker-Polito administration encourages COVID-19 vaccination and boosters at family-friendly events during... |
 "COVID-19" - Google News 18h "COVID-19" - Google News 18h |
| Church leaders give COVID-19 guidelines ahead of Easter - WJBF-TV |
| Church leaders give COVID-19 guidelines ahead of Easter WJBF-TV |
 "COVID-19" - Google News 18h "COVID-19" - Google News 18h |
 | COVID-19 Paid Leave Law: FAQ | Franczek PC - JDSupra - JD Supra |
| COVID-19 Paid Leave Law: FAQ | Franczek PC - JDSupra JD Supra |
 "COVID-19" - Google News 18h "COVID-19" - Google News 18h |
| Florida COVID-19 cases are rising - WJXT News4JAX |
| Florida COVID-19 cases are rising WJXT News4JAX |
 "coronavirus news" - Google News 18h "coronavirus news" - Google News 18h |
| Michigan Health Officials Report 7725 Coronavirus Cases, 81 Deaths - 9 & 10 News... |
| Michigan Health Officials Report 7725 Coronavirus Cases, 81 Deaths - 9 & 10 News 9&10 News |
 "coronavirus news" - Google News 18h "coronavirus news" - Google News 18h |
| Covid-19 Tracker: A guessing game - Mission Local |
| Covid-19 Tracker: A guessing game Mission Local |
 "COVID" - Google News 18h "COVID" - Google News 18h |
| Pfizer's CEO pushed employees to do what they thought impossible in fast-tracking... |
| Pfizer's CEO pushed employees to do what they thought impossible in fast-tracking a COVID vaccine Fortune |
 "COVID" - Google News 18h "COVID" - Google News 18h |
| EU excess mortality fell 20% during 2022 omicron surge - Courthouse News Service |
| EU excess mortality fell 20% during 2022 omicron surge Courthouse News Service |
 "Omicron" - Google News 18h "Omicron" - Google News 18h |
| Covid 19 Omicron outbreak: Southern healthcare hanging tough as cases linger - New... |
| Covid 19 Omicron outbreak: Southern healthcare hanging tough as cases linger New Zealand Herald |
 "Omicron" - Google News 18h "Omicron" - Google News 18h |
| Covid 19 Omicron: Simple RAT mistakes may be concealing Covid rates - New Zealand... |
| Covid 19 Omicron: Simple RAT mistakes may be concealing Covid rates New Zealand Herald |
 "Omicron" - Google News 18h "Omicron" - Google News 18h |
| COVID twice: Omicron reinfection symptoms tough to predict - CTV News |
| COVID twice: Omicron reinfection symptoms tough to predict CTV News |
 "Omicron" - Google News 18h "Omicron" - Google News 18h |
| Diagnosing sneezy symptoms: Is it a cold, COVID-19, or allergies? - NEWS10 ABC |
| Diagnosing sneezy symptoms: Is it a cold, COVID-19, or allergies? NEWS10 ABC |
 "COVID-19" - Google News 18h "COVID-19" - Google News 18h |
 | Michigan reports 7,725 new COVID-19 cases, 81 new deaths over past week - Detroit... |
| Michigan reports 7,725 new COVID-19 cases, 81 new deaths over past week Detroit Free Press |
 "COVID-19" - Google News 18h "COVID-19" - Google News 18h |
| Attorney General William Tong tests positive for COVID-19 - FOX61 Hartford |
| Attorney General William Tong tests positive for COVID-19 FOX61 Hartford |
 "COVID-19" - Google News 18h "COVID-19" - Google News 18h |
| Mexicans looking to dodge inflation, keep Lent tradition alive - La Prensa Latina |
| Mexicans looking to dodge inflation, keep Lent tradition alive La Prensa Latina |
 "Coronavirus in fish and seafood" - Google News 18h "Coronavirus in fish and seafood" - Google News 18h |
| Coronavirus updates for April 13: Here’s what to know in North Carolina this... |
| Coronavirus updates for April 13: Here's what to know in North Carolina this week Raleigh News &... |
 "coronavirus news" - Google News 18h "coronavirus news" - Google News 18h |
| Man arrested in Brooklyn subway attack charged with terror - News-Gazette.com |
| Man arrested in Brooklyn subway attack charged with terror News-Gazette.com |
 "coronavirus news" - Google News 18h "coronavirus news" - Google News 18h |
| WHO is tracking two new omicron COVID-19 subvariants - KIRO Seattle |
| WHO is tracking two new omicron COVID-19 subvariants KIRO Seattle |
 "coronavirus news" - Google News 18h "coronavirus news" - Google News 18h |
| Here's What You Can Do to Protect Yourself From COVID-19 Based on Community Spread... |
| Here's What You Can Do to Protect Yourself From COVID-19 Based on Community Spread WTTW News |
 "coronavirus news" - Google News 18h "coronavirus news" - Google News 18h |
| State Health Officer Dr. Scott Harris Tests Positive for COVID-19 - Alabama News... |
| State Health Officer Dr. Scott Harris Tests Positive for COVID-19 - Alabama News Alabama News Network |
 "coronavirus news" - Google News 18h "coronavirus news" - Google News 18h |
| Michigan adds 7,725 cases, 81 deaths from COVID-19 - Detroit News |
| Michigan adds 7,725 cases, 81 deaths from COVID-19 Detroit News |
 "COVID" - Google News 18h "COVID" - Google News 18h |
| Updated Guidelines for COVID-19 - Texas A&M University - Texas A&M University |
| Updated Guidelines for COVID-19 - Texas A&M University Texas A&M University |
 "COVID" - Google News 18h "COVID" - Google News 18h |
| Wellness Wednesday: How COVID impacts diagnosing autism - WSYR |
| Wellness Wednesday: How COVID impacts diagnosing autism WSYR |
 "COVID" - Google News 18h "COVID" - Google News 18h |
| Shopify Stock Trades At Pre-Covid Levels. Is It A Buy? - Forbes |
| Shopify Stock Trades At Pre-Covid Levels. Is It A Buy? Forbes |
 "COVID" - Google News 18h "COVID" - Google News 18h |
| Gunman opens fire on Brooklyn subway; at least 16 injured - Arab News |
| Gunman opens fire on Brooklyn subway; at least 16 injured Arab News |
 "aggressive squirrels in new york city" - Google News 18h "aggressive squirrels in new york city" - Google News 18h |
| First omicron XE subvariant detected in Japan - WXYZ 7 Action News Detroit |
| First omicron XE subvariant detected in Japan WXYZ 7 Action News Detroit |
 "Omicron" - Google News 18h "Omicron" - Google News 18h |
| BA2 Omicron variant continues to remain dominant strain in Telangana - Telangana... |
| BA2 Omicron variant continues to remain dominant strain in Telangana Telangana Today |
 "Omicron" - Google News 18h "Omicron" - Google News 18h |
| Mask Mandate On US Transit Set To Expire As Omicron Cases Tick Up - Financial Advisor... |
| Mask Mandate On US Transit Set To Expire As Omicron Cases Tick Up Financial Advisor Magazine |
 "Omicron" - Google News 18h "Omicron" - Google News 18h |
| New omicron subvariants: What are BA.4 and BA.5 COVID variants? - Deseret News |
| New omicron subvariants: What are BA.4 and BA.5 COVID variants? Deseret News |
 "Omicron" - Google News 18h "Omicron" - Google News 18h |
| Shaw Communications Suffers 2% Revenue Decline In Q2 As Omicron Variant Peaked In... |
| Shaw Communications Suffers 2% Revenue Decline In Q2 As Omicron Variant Peaked In Canada - Benzinga Benzinga |
 "Omicron" - Google News 18h "Omicron" - Google News 18h |
| Disease X-19 Regions from Michael_Novakhov (8 sites): Google Alert - coronavirus... |
| Italy reported 62037 COVID-19 related cases on Wednesday, against 83643 the day before, the health ministry... |
 Disease X-19 from Michael_Novakhov (12 sites) 18h Disease X-19 from Michael_Novakhov (12 sites) 18h |
| Disease X-19 Epidemiology from Michael_Novakhov (39 sites): Google Alert - mink:... |
| Sam Mink, the owner of the restaurant Oyster House, argued that the reinstated mask mandate in Philadelphia... |
 Disease X-19 from Michael_Novakhov (12 sites) 18h Disease X-19 from Michael_Novakhov (12 sites) 18h |
| Disease X-19 as the Bio-weapon from Michael_Novakhov (3 sites): Google Alert - CoronaVirus... |
| How did the world get sick, how did Covid really spread, and did the Satanic elite tell the world about... |
 Disease X-19 from Michael_Novakhov (12 sites) 18h Disease X-19 from Michael_Novakhov (12 sites) 18h |
| Disease X-19 Epidemiology from Michael_Novakhov (39 sites): Google Alert - mink:... |
| Also, Wendy Mink is a political scientist; I think she felt a little torn between doing something personal... |
 Disease X-19 from Michael_Novakhov (12 sites) 18h Disease X-19 from Michael_Novakhov (12 sites) 18h |
| Disease X-19 Publications from Michael_Novakhov (5 sites): Google Alert - covid-19... |
| The COVID-19 pandemic fueled the rise, with more than 400000 deaths. ... By Mansur Shaheen U.S. Deputy... |
 Disease X-19 from Michael_Novakhov (12 sites) 18h Disease X-19 from Michael_Novakhov (12 sites) 18h |
| Disease X-19 Regions from Michael_Novakhov (8 sites): Google Alert - coronavirus... |
| The 2022 Italian Spring Championships will conclude today with some of Italy's biggest swim stars in... |
 Disease X-19 from Michael_Novakhov (12 sites) 18h Disease X-19 from Michael_Novakhov (12 sites) 18h |
| Disease X-19 Regions from Michael_Novakhov (8 sites): Google Alert - coronavirus... |
| But in the wake of a loosening of its stance on Covid, Italy is now accessible to tourists via proof... |
 Disease X-19 from Michael_Novakhov (12 sites) 18h Disease X-19 from Michael_Novakhov (12 sites) 18h |
| Wisconsin trending the wrong way, adds over 775 new COVID-19 cases - WeAreGreenBay.com |
| Wisconsin trending the wrong way, adds over 775 new COVID-19 cases WeAreGreenBay.com |
 "Covid-19" - Google News 18h "Covid-19" - Google News 18h |
| Attorney General Tong tests positive for COVID-19 - WTNH.com |
| Attorney General Tong tests positive for COVID-19 WTNH.com |
 "Covid-19" - Google News 18h "Covid-19" - Google News 18h |
 | Covid-19 Second Boosters Available - Americus Times-Recorder - Americus Times-Recorder |
| Covid-19 Second Boosters Available - Americus Times-Recorder Americus Times-Recorder |
 "Covid-19" - Google News 18h "Covid-19" - Google News 18h |
| FLASH REPORT #207 - COVID-19 Response and Recovery | News | City of San Jose - City... |
| FLASH REPORT #207 - COVID-19 Response and Recovery | News | City of San Jose City of San Jose, CA |
 "COVID-19" - Google News 19h "COVID-19" - Google News 19h |
 | Covid-19 Related Inflation Surpasses 40 Year Record: How Long Will It Persist? -... |
| Covid-19 Related Inflation Surpasses 40 Year Record: How Long Will It Persist? Forbes |
 "COVID-19" - Google News 19h "COVID-19" - Google News 19h |
 | COVID cases are up in the US. What's happening in Iowa? - Des Moines Register |
| COVID cases are up in the US. What's happening in Iowa? Des Moines Register |
 "COVID-19" - Google News 19h "COVID-19" - Google News 19h |
 | When Is the Right Time to Get Your Second COVID-19 Booster? - MU Health Care |
| When Is the Right Time to Get Your Second COVID-19 Booster? MU Health Care |
 "COVID-19" - Google News 19h "COVID-19" - Google News 19h |
 | Global COVID-19 cases and deaths fall for 3rd consecutive week, WHO says - FOX 5... |
| Global COVID-19 cases and deaths fall for 3rd consecutive week, WHO says FOX 5 DC |
 "COVID-19" - Google News 19h "COVID-19" - Google News 19h |
 | COVID-19 cases are expected to increase in NC. Will wastewater help us know when?... |
| COVID-19 cases are expected to increase in NC. Will wastewater help us know when? The Progressive Pulse |
 "COVID-19" - Google News 19h "COVID-19" - Google News 19h |
| City mulling various options to address homelessness as weather warms - The Ithaca... |
| City mulling various options to address homelessness as weather warms The Ithaca Voice |
 "Coronavirus in rodents" - Google News 19h "Coronavirus in rodents" - Google News 19h |
| Man wanted in Brooklyn subway attack arrested, officials say - News-Gazette.com |
| Man wanted in Brooklyn subway attack arrested, officials say News-Gazette.com |
 "coronavirus news" - Google News 19h "coronavirus news" - Google News 19h |
| Bipartisan push on mental health crisis that COVID worsened - WCBD News 2 |
| Bipartisan push on mental health crisis that COVID worsened WCBD News 2 |
 "coronavirus news" - Google News 19h "coronavirus news" - Google News 19h |
| State adds 1200 COVID cases for second day in a row - Sunbury Daily Item |
| State adds 1200 COVID cases for second day in a row Sunbury Daily Item |
 "coronavirus news" - Google News 19h "coronavirus news" - Google News 19h |
| UK investigating puzzling spike in liver disease in children - Oil City Derrick |
| UK investigating puzzling spike in liver disease in children Oil City Derrick |
 "aggressive squirrels in new york city" - Google News 19h "aggressive squirrels in new york city" - Google News 19h |
| WHO: COVID cases and deaths fall for 3rd consecutive week - Spectrum News NY1 |
| WHO: COVID cases and deaths fall for 3rd consecutive week Spectrum News NY1 |
 "COVID" - Google News 19h "COVID" - Google News 19h |
| Why calling the highly contagious COVID-19 omicron BA.2 a 'stealth variant' is a... |
| Why calling the highly contagious COVID-19 omicron BA.2 a 'stealth variant' is a misnomer LimaOhio.com |
 "Omicron" - Google News 19h "Omicron" - Google News 19h |
| Omicron worries dominate Legislature's Health Committee - Halifax Examiner |
| Omicron worries dominate Legislature's Health Committee Halifax Examiner |
 "Omicron" - Google News 19h "Omicron" - Google News 19h |
| SpikImm, a Biotech Company Founded by Truffle Capital and Institut Pasteur, Announces... |
| SpikImm, a Biotech Company Founded by Truffle Capital and Institut Pasteur, Announces That Its Monoclonal... |
 "Omicron" - Google News 19h "Omicron" - Google News 19h |
 | New Initiatives Awarded $4.7 Million to Encourage COVID-19 Testing in Underserved... |
| New Initiatives Awarded $4.7 Million to Encourage COVID-19 Testing in Underserved Communities and Schools University... |
 "COVID-19" - Google News 19h "COVID-19" - Google News 19h |
 | Jenna Bush Hager Tests Positive for COVID-19, Misses 'Today' Taping - Hollywood Reporter |
| Jenna Bush Hager Tests Positive for COVID-19, Misses 'Today' Taping Hollywood Reporter |
 "COVID-19" - Google News 19h "COVID-19" - Google News 19h |
 | COVID-19 Risk Factors, Broken Down by Occupation - Contagionlive.com |
| COVID-19 Risk Factors, Broken Down by Occupation Contagionlive.com |
 "COVID-19" - Google News 19h "COVID-19" - Google News 19h |
 | Scientific statement from the American Heart Association on COVID-19 and cardiovascular... |
| Scientific statement from the American Heart Association on COVID-19 and cardiovascular complications... |
 "COVID-19" - Google News 19h "COVID-19" - Google News 19h |
 | Shanghai starts China's biggest COVID-19 lockdown in 2 years - The Associated Press... |
| Shanghai starts China's biggest COVID-19 lockdown in 2 years The Associated Press - en Español |
 "COVID-19" - Google News 19h "COVID-19" - Google News 19h |
| Covid test sites pop up ahead of Coachella Festival - kuna noticias y kuna radio |
| Covid test sites pop up ahead of Coachella Festival kuna noticias y kuna radio |
 "coronavirus news" - Google News 19h "coronavirus news" - Google News 19h |
| Bipartisan Push on Mental Health Crisis That COVID Worsened - U.S. News & World Report |
| Bipartisan Push on Mental Health Crisis That COVID Worsened U.S. News & World Report |
 "coronavirus news" - Google News 19h "coronavirus news" - Google News 19h |
| Philadelphia becomes first major US city to reinstate its indoor mask mandate as... |
| Philadelphia becomes first major US city to reinstate its indoor mask mandate as cases rise CNN |
 "coronavirus news" - Google News 19h "coronavirus news" - Google News 19h |
| Bollinger finishes 2nd in national speech contest | People | codyenterprise.com -... |
| Bollinger finishes 2nd in national speech contest | People | codyenterprise.com Cody Enterprise |
 "covid -19 origins" - Google News 19h "covid -19 origins" - Google News 19h |
| Uninsured face surprise medical bills for Covid testing, hospital treatment after... |
| Uninsured face surprise medical bills for Covid testing, hospital treatment after U.S. Congress fails... |
 "COVID" - Google News 19h "COVID" - Google News 19h |
| A million empty spaces: Chronicling COVID's ruthless U.S. toll - The Columbian |
| A million empty spaces: Chronicling COVID's ruthless U.S. toll The Columbian |
 "COVID" - Google News 19h "COVID" - Google News 19h |
| Hokie Health: Resources and support for those affected by long-haul COVID - Virginia... |
| Hokie Health: Resources and support for those affected by long-haul COVID Virginia Tech Daily |
 "COVID" - Google News 19h "COVID" - Google News 19h |
| Immune Responses Support COVID-19 Vaccination, Regardless of When Infection Occurred... |
| Immune Responses Support COVID-19 Vaccination, Regardless of When Infection Occurred Pharmacy Times |
 "COVID" - Google News 19h "COVID" - Google News 19h |
| In-Person VR Is a Crystal Ball to the Metaverse. COVID Tried to Shatter It - CNET |
| In-Person VR Is a Crystal Ball to the Metaverse. COVID Tried to Shatter It CNET |
 "COVID" - Google News 19h "COVID" - Google News 19h |
| April 13 COVID update: No need to fear repeat of delta, omicron surge, health experts... |
| April 13 COVID update: No need to fear repeat of delta, omicron surge, health experts say Charleston... |
 "Omicron" - Google News 19h "Omicron" - Google News 19h |
| China's foreign trade mirrors stable start in Q1 despite Omicron outbreak, Ukraine... |
| China's foreign trade mirrors stable start in Q1 despite Omicron outbreak, Ukraine crisis Global Times |
 "Omicron" - Google News 19h "Omicron" - Google News 19h |
 | Phillies' Corey Knebel: Returns from COVID-19 IL - CBS Sports |
| Phillies' Corey Knebel: Returns from COVID-19 IL CBS Sports |
 "Covid-19" - Google News 19h "Covid-19" - Google News 19h |
 | COVID-19 hospitalizations increase, while cases remain steady - The Gazette |
| COVID-19 hospitalizations increase, while cases remain steady The Gazette |
 "COVID-19" - Google News 20h "COVID-19" - Google News 20h |
 | Government funding for COVID-19 services is running out, leaving uninsured people... |
| Government funding for COVID-19 services is running out, leaving uninsured people hanging Prism |
 "COVID-19" - Google News 20h "COVID-19" - Google News 20h |
| Urgency of COVID-19 research put research for other diseases on hold - Denver 7 Colorado... |
| Urgency of COVID-19 research put research for other diseases on hold Denver 7 Colorado News |
 "COVID-19" - Google News 20h "COVID-19" - Google News 20h |
 | Jenna Bush Hager Absent from Today After Contracting COVID-19: 'She's Doing Great'... |
| Jenna Bush Hager Absent from Today After Contracting COVID-19: 'She's Doing Great' PEOPLE |
 "COVID-19" - Google News 20h "COVID-19" - Google News 20h |
 | Florida Gov. Ron DeSantis promises to block new COVID-19 restrictions for 'as long... |
| Florida Gov. Ron DeSantis promises to block new COVID-19 restrictions for 'as long as [he sits] in the... |
 "COVID-19" - Google News 20h "COVID-19" - Google News 20h |
 | Edinboro University Hosts COVID-19 Testing Site - erienewsnow.com |
| Edinboro University Hosts COVID-19 Testing Site erienewsnow.com |
 "COVID-19" - Google News 20h "COVID-19" - Google News 20h |
| Vaccinations urged as positive COVID-19 cases rise in county - oswegocountynewsnow.com |
| Vaccinations urged as positive COVID-19 cases rise in county oswegocountynewsnow.com |
 "COVID-19" - Google News 20h "COVID-19" - Google News 20h |
| Evolution of a globally unique SARS-CoV-2 Spike E484T monoclonal antibody escape... |
| Prolonged infections in immunocompromised individuals may be a source for novel SARS-CoV-2 variants,... |
 bioRxiv Channel: COVID-19 SARS-CoV-2 preprints from medRxiv and bioRxiv 20h bioRxiv Channel: COVID-19 SARS-CoV-2 preprints from medRxiv and bioRxiv 20h |
 | Bipartisan push on mental health crisis that COVID worsened - ABC News |
| Bipartisan push on mental health crisis that COVID worsened ABC News |
 "coronavirus news" - Google News 20h "coronavirus news" - Google News 20h |
| 'No Floridian will be restricted': DeSantis makes promises about COVID - WFLA |
| 'No Floridian will be restricted': DeSantis makes promises about COVID WFLA |
 "coronavirus news" - Google News 20h "coronavirus news" - Google News 20h |
 | Ontario COVID-19 news: 13 new deaths reported; hospitalizations fall - CP24 Toronto's... |
| Ontario COVID-19 news: 13 new deaths reported; hospitalizations fall CP24 Toronto's Breaking News |
 "coronavirus news" - Google News 20h "coronavirus news" - Google News 20h |
| Healthcare services coping in south as Omicron wave lingers - RNZ |
| Healthcare services coping in south as Omicron wave lingers RNZ |
 "Omicron" - Google News 20h "Omicron" - Google News 20h |
| U.S. to extend travel mask mandate as omicron cases rise - Crain's Chicago Business |
| U.S. to extend travel mask mandate as omicron cases rise Crain's Chicago Business |
 "Omicron" - Google News 20h "Omicron" - Google News 20h |
| Disease X-19 General Issues from Michael_Novakhov (5 sites): Google Alert - coronavirus:... |
| The world surpasses half a billion known coronavirus cases, amid concerns about testing. New Zealand... |
 Disease X-19 from Michael_Novakhov (12 sites) 20h Disease X-19 from Michael_Novakhov (12 sites) 20h |
| Disease X-19 General Issues from Michael_Novakhov (5 sites): Google Alert - coronavirus:... |
| * British Prime Minister Boris Johnson apologised but defied calls to resign on Tuesday after being fined... |
 Disease X-19 from Michael_Novakhov (12 sites) 20h Disease X-19 from Michael_Novakhov (12 sites) 20h |
| Disease X-19 General Issues from Michael_Novakhov (5 sites): Google Alert - Latest... |
| * Eikon users, see COVID-19: MacroVitals https://apac1.apps.cp.thomsonreuters.com/cms/?navid=1592404098... |
 Disease X-19 from Michael_Novakhov (12 sites) 20h Disease X-19 from Michael_Novakhov (12 sites) 20h |
 | Correlations between kidney and heart function bioindicators and the expressions... |
| submitted by /u/icloudbug [link] [comments] |
| |
 | Onondaga County is first in NY with new, more contagious Covid-19 strain, McMahon... |
| Onondaga County is first in NY with new, more contagious Covid-19 strain, McMahon says syracuse.com |
 "Covid-19" - Google News 20h "Covid-19" - Google News 20h |
 | 74 New COVID-19 Cases Identified in Camden County - Camden County |
| 74 New COVID-19 Cases Identified in Camden County Camden County |
 "COVID-19" - Google News 20h "COVID-19" - Google News 20h |
 | New Analysis Shows Fluvoxamine Has The Potential To Reduce Covid-19 Hospitalizations... |
| New Analysis Shows Fluvoxamine Has The Potential To Reduce Covid-19 Hospitalizations By More Than 90% Forbes |
 "COVID-19" - Google News 20h "COVID-19" - Google News 20h |
 | Prince Albert of Monaco Has COVID-19 for Second Time After Speaking Out on His Long... |
| Prince Albert of Monaco Has COVID-19 for Second Time After Speaking Out on His Long Recovery PEOPLE |
 "COVID-19" - Google News 20h "COVID-19" - Google News 20h |
 | NAPA Urges Better Fed-State Data Sharing in Critique of COVID-19 Response - MeriTalk |
| NAPA Urges Better Fed-State Data Sharing in Critique of COVID-19 Response MeriTalk |
 "COVID-19" - Google News 20h "COVID-19" - Google News 20h |
 | Gaston County's COVID cases fall 31.1%; North Carolina cases plummet 43.5% - Gaston... |
| Gaston County's COVID cases fall 31.1%; North Carolina cases plummet 43.5% Gaston Gazette |
 "COVID-19" - Google News 20h "COVID-19" - Google News 20h |
| How much more transmissible is Omicron's BA.2 sub-variant? - Sydney Morning Herald |
| How much more transmissible is Omicron's BA.2 sub-variant? Sydney Morning Herald |
 "Omicron" - Google News 20h "Omicron" - Google News 20h |
| Saugerties COVID swindler's brother pleas guilty to obstruction - NEWS10 ABC |
| Saugerties COVID swindler's brother pleas guilty to obstruction NEWS10 ABC |
 "COVID" - Google News 20h "COVID" - Google News 20h |
| N.J. reports 1,844 COVID cases, 9 deaths as mask mandate for public transit is extended... |
| N.J. reports 1,844 COVID cases, 9 deaths as mask mandate for public transit is extended NJ.com |
 "COVID" - Google News 20h "COVID" - Google News 20h |
| Two arraigned in $3 million COVID Unemployment Insurance Benefits scheme - Department... |
| Two arraigned in $3 million COVID Unemployment Insurance Benefits scheme Department of Justice |
 "COVID" - Google News 20h "COVID" - Google News 20h |
| Alabama's state health officer tests positive for COVID-19 - WAFF |
| Alabama's state health officer tests positive for COVID-19 WAFF |
 "COVID" - Google News 20h "COVID" - Google News 20h |
| WHO: COVID cases and deaths fall for 3rd consecutive week - Modern Healthcare |
| WHO: COVID cases and deaths fall for 3rd consecutive week Modern Healthcare |
 "COVID" - Google News 20h "COVID" - Google News 20h |
| New Drug Slashed Deaths Among Patients With Severe Covid, Maker Claims - The New... |
| New Drug Slashed Deaths Among Patients With Severe Covid, Maker Claims The New York Times |
 "COVID" - Google News 20h "COVID" - Google News 20h |
| Disease X-19 Epidemiology from Michael_Novakhov (39 sites): Google Alert - covid-19... |
| It is a recognition of how Covid-19 forced many companies to abandon office buildings and empty cubicles.... |
 Disease X-19 from Michael_Novakhov (12 sites) 20h Disease X-19 from Michael_Novakhov (12 sites) 20h |
| Disease X-19 Epidemiology from Michael_Novakhov (39 sites): Google Alert - covid-19... |
| There was a 6.5% drop in premature births from cesarean sections and induced deliveries in the United... |
 Disease X-19 from Michael_Novakhov (12 sites) 20h Disease X-19 from Michael_Novakhov (12 sites) 20h |
| Disease X-19 Epidemiology from Michael_Novakhov (39 sites): Google Alert - covid-19... |
| The Committee also noted with concern the growing fatigue among communities worldwide in response to... |
 Disease X-19 from Michael_Novakhov (12 sites) 20h Disease X-19 from Michael_Novakhov (12 sites) 20h |
| Disease X-19 Epidemiology from Michael_Novakhov (39 sites): Google Alert - covid-19... |
| Plant-based meat surrogates have been the rage for some time. "Impossible" has become a buzzword to tout... |
 Disease X-19 from Michael_Novakhov (12 sites) 20h Disease X-19 from Michael_Novakhov (12 sites) 20h |
| Disease X-19 Publications from Michael_Novakhov (5 sites): Google Alert - coronavirus... |
| Small Business. Looking for a Brand Name That Will Stand Out? Try Finnish · How Jack Dorsey Quit Twitter... |
 Disease X-19 from Michael_Novakhov (12 sites) 20h Disease X-19 from Michael_Novakhov (12 sites) 20h |
| Disease X-19 Publications from Michael_Novakhov (5 sites): Google Alert - coronavirus... |
| Scores of screen-grabbed posts from China's most popular social media platforms have been translated... |
 Disease X-19 from Michael_Novakhov (12 sites) 20h Disease X-19 from Michael_Novakhov (12 sites) 20h |
| Boron Citrate as a COVID-19 Ameliorant |
| submitted by /u/curiosfinds [link] [comments] |
| |
| Wyoming COVID-19 Death Toll Tops 1,800 - Kgab |
| Wyoming COVID-19 Death Toll Tops 1,800 Kgab |
 "Coronavirus in meat plants" - Google News 20h "Coronavirus in meat plants" - Google News 20h |
 | Study Calls into Question Link Between COVID-19 Vaccines and Myopericarditis - BioSpace |
| Study Calls into Question Link Between COVID-19 Vaccines and Myopericarditis BioSpace |
 "COVID-19" - Google News 20h "COVID-19" - Google News 20h |
 | COVID-19: New Subvariant Gains Traction and Hopeful News for the Immunocompromised... |
| COVID-19: New Subvariant Gains Traction and Hopeful News for the Immunocompromised BioSpace |
 "COVID-19" - Google News 20h "COVID-19" - Google News 20h |
 | COVID-19 pooled testing ending in Maine schools next month - WABI |
| COVID-19 pooled testing ending in Maine schools next month WABI |
 "COVID-19" - Google News 20h "COVID-19" - Google News 20h |
 | Adding Pulse Oximetry Shows No Benefit in COVID-19 - HealthDay News |
| Adding Pulse Oximetry Shows No Benefit in COVID-19 HealthDay News |
 "COVID-19" - Google News 20h "COVID-19" - Google News 20h |
| Florida bars lose appeal over COVID-19 shutdown - Wink News |
| Florida bars lose appeal over COVID-19 shutdown Wink News |
 "COVID-19" - Google News 20h "COVID-19" - Google News 20h |
 | Second COVID-19 boosters available to eligible Berrien County residents - Leader... |
| Second COVID-19 boosters available to eligible Berrien County residents - Leader Publications Leader... |
 "COVID-19" - Google News 20h "COVID-19" - Google News 20h |
 | Bill would block COVID-19 vaccine requirements in Louisiana - New Orleans CityBusiness |
| Bill would block COVID-19 vaccine requirements in Louisiana New Orleans CityBusiness |
 "COVID-19" - Google News 20h "COVID-19" - Google News 20h |
| Animals the latest frontier in COVID fight | State - Southernminn.com |
| Animals the latest frontier in COVID fight | State Southernminn.com |
 "Coronavirus in rodents" - Google News 21h "Coronavirus in rodents" - Google News 21h |
| Coronavirus Morning News Brief – April 13: Will Inflation Turn on a Dime, Apple Employees... |
| Coronavirus Morning News Brief – April 13: Will Inflation Turn on a Dime, Apple Employees Return to Campus Frequent... |
 "Coronavirus in rodents" - Google News 21h "Coronavirus in rodents" - Google News 21h |
| Correlations between kidney and heart function bioindicators and the expressions... |
| Abstract Background: COVID-19 impacts the cardiovascular system resulting in myocardial damage and also... |
 bioRxiv Channel: COVID-19 SARS-CoV-2 preprints from medRxiv and bioRxiv 21h bioRxiv Channel: COVID-19 SARS-CoV-2 preprints from medRxiv and bioRxiv 21h |
| U.S. Renews COVID-19 Public Health Emergency - U.S. News & World Report |
| U.S. Renews COVID-19 Public Health Emergency U.S. News & World Report |
 "coronavirus news" - Google News 21h "coronavirus news" - Google News 21h |
| Coronavirus daily news updates, April 13: What to know today about COVID-19 in the... |
| Coronavirus daily news updates, April 13: What to know today about COVID-19 in the Seattle area, Washington... |
 "coronavirus news" - Google News 21h "coronavirus news" - Google News 21h |
| COVID Cases Reach 500 Million Worldwide | Health News | US News - U.S. News & World... |
| COVID Cases Reach 500 Million Worldwide | Health News | US News U.S. News & World Report |
 "coronavirus news" - Google News 21h "coronavirus news" - Google News 21h |
| Oil jumps 6% on OPEC warning and easing of Shanghai COVID curbs - CNBC |
| Oil jumps 6% on OPEC warning and easing of Shanghai COVID curbs CNBC |
 "coronavirus news" - Google News 21h "coronavirus news" - Google News 21h |
| Indonesia passes landmark sexual violence bill - Arab News |
| Indonesia passes landmark sexual violence bill Arab News |
 "aggressive squirrels in new york city" - Google News 21h "aggressive squirrels in new york city" - Google News 21h |
| Why Covid cases are falling and whether Omicron means next spike will be 'when' not... |
| Why Covid cases are falling and whether Omicron means next spike will be 'when' not 'if' iNews |
 "Omicron" - Google News 21h "Omicron" - Google News 21h |
| When Hong Kong's “dynamic zero” covid-19 strategy met omicron, low vaccination... |
| When Hong Kong's "dynamic zero" covid-19 strategy met omicron, low vaccination rates sent deaths soaring The... |
 "Omicron" - Google News 21h "Omicron" - Google News 21h |
| What do we know about “stealth omicron" so far? - The Associated Press |
| What do we know about "stealth omicron" so far? The Associated Press |
 "Omicron" - Google News 21h "Omicron" - Google News 21h |
| Shanghai Cases Exceed 26,000 as China Covid Zero Rules Persist - Bloomberg |
| Shanghai Cases Exceed 26,000 as China Covid Zero Rules Persist Bloomberg |
 "COVID" - Google News 21h "COVID" - Google News 21h |
 | Strauss Proposes Strengthening Protections For Tenants In Aftermath Of COVID-19 -... |
| Strauss Proposes Strengthening Protections For Tenants In Aftermath Of COVID-19 Seattle Medium |
 "COVID-19" - Google News 21h "COVID-19" - Google News 21h |
 | US renews COVID-19 public health emergency - Reuters |
| US renews COVID-19 public health emergency Reuters |
 "COVID-19" - Google News 21h "COVID-19" - Google News 21h |
 | Test Positive for COVID-19 While Traveling? Here's What To Do - TIME |
| Test Positive for COVID-19 While Traveling? Here's What To Do TIME |
 "COVID-19" - Google News 21h "COVID-19" - Google News 21h |
| Alabama health officer Dr. Scott Harris tests positive for COVID-19 - WIAT - CBS42.com |
| Alabama health officer Dr. Scott Harris tests positive for COVID-19 WIAT - CBS42.com |
 "coronavirus news" - Google News 21h "coronavirus news" - Google News 21h |
| Is Covid-19 endemic yet? Experts aren't so sure - Henry Herald |
| Is Covid-19 endemic yet? Experts aren't so sure Henry Herald |
 "coronavirus news" - Google News 21h "coronavirus news" - Google News 21h |
| Second Omicron wave fizzles as daily cases drop by a third but deaths highest in... |
| Second Omicron wave fizzles as daily cases drop by a third but deaths highest in more than a year due... |
 "Omicron" - Google News 21h "Omicron" - Google News 21h |
| WHO says Covid still a global public health emergency even as deaths fall to lowest... |
| WHO says Covid still a global public health emergency even as deaths fall to lowest level in two years CNBC |
 "COVID" - Google News 21h "COVID" - Google News 21h |
| Pfizer's Bourla: COVID vaccines for new variants possible for Fall - Reuters |
| Pfizer's Bourla: COVID vaccines for new variants possible for Fall Reuters |
 "COVID" - Google News 21h "COVID" - Google News 21h |
| XE variant: What we know about the new COVID strain found in England - Euronews |
| XE variant: What we know about the new COVID strain found in England Euronews |
 "COVID" - Google News 21h "COVID" - Google News 21h |
| More Taiwan firms suspend production in China as COVID spreads - Reuters |
| More Taiwan firms suspend production in China as COVID spreads Reuters |
 "COVID" - Google News 21h "COVID" - Google News 21h |
| CDC to extend travel mask mandate to monitor uptick in COVID-19 cases - WFLA |
| CDC to extend travel mask mandate to monitor uptick in COVID-19 cases WFLA |
 "Covid-19" - Google News 21h "Covid-19" - Google News 21h |
| Disease X-19 and Security from Michael_Novakhov (10 sites): Google Alert - Coronavirus... |
| The U.S. Navy says it will begin a new task force with allied countries to patrol the Red Sea after a... |
 Disease X-19 from Michael_Novakhov (12 sites) 21h Disease X-19 from Michael_Novakhov (12 sites) 21h |
| Disease X-19 and Security from Michael_Novakhov (10 sites): Google Alert - Coronavirus... |
| The U.S. Navy's elite flight demonstration team, the Blue Angels, will be in Jacksonville Wednesday to... |
 Disease X-19 from Michael_Novakhov (12 sites) 21h Disease X-19 from Michael_Novakhov (12 sites) 21h |
| Disease X-19 and Security from Michael_Novakhov (10 sites): Google Alert - coronavirus... |
| ... in positive coronavirus cases among orchestra members as well as concerns about the rising number... |
 Disease X-19 from Michael_Novakhov (12 sites) 21h Disease X-19 from Michael_Novakhov (12 sites) 21h |
| Court backs Miami Dade College in COVID-19 shutdown case - Wink News |
| Court backs Miami Dade College in COVID-19 shutdown case Wink News |
 "COVID-19" - Google News 21h "COVID-19" - Google News 21h |
 | Central Texas health officials cautiously celebrate milestone of decline in COVID-19... |
| Central Texas health officials cautiously celebrate milestone of decline in COVID-19 KWTX |
 "COVID-19" - Google News 21h "COVID-19" - Google News 21h |
 | Case update: Arkansas COVID-19 cases increase by 556 over last 7 days - Fayetteville... |
| Case update: Arkansas COVID-19 cases increase by 556 over last 7 days Fayetteville Flyer |
 "COVID-19" - Google News 21h "COVID-19" - Google News 21h |
| Prevalence, Characteristics, and Outcomes of COVID-19–Associated Acute Myocarditis... |
| Prevalence, Characteristics, and Outcomes of COVID-19–Associated Acute Myocarditis AHA Journals |
 "COVID-19" - Google News 21h "COVID-19" - Google News 21h |
| Brain-inspired computing needs a master plan - Nature.com |
| Brain-inspired computing needs a master plan Nature.com |
 "Coronavirus Origins Are Still Uncertain - US Intel Probe" - Google News 22h "Coronavirus Origins Are Still Uncertain - US Intel Probe" - Google News 22h |
| Amid Exkivity launch, Takeda beefs up in-house digital content team, AI to educate... |
| Amid Exkivity launch, Takeda beefs up in-house digital content team, AI to educate oncologists FiercePharma |
 "Coronavirus Origins Are Still Uncertain - US Intel Probe" - Google News 22h "Coronavirus Origins Are Still Uncertain - US Intel Probe" - Google News 22h |
| Researchers detect the world's first wild river otter coronavirus case - YubaNet |
| Researchers detect the world's first wild river otter coronavirus case YubaNet |
 "covid -19 origins" - Google News 22h "covid -19 origins" - Google News 22h |
| Maine schools will end pooled coronavirus testing next month - observer-me.com |
| Maine schools will end pooled coronavirus testing next month observer-me.com |
 "coronavirus news" - Google News 22h "coronavirus news" - Google News 22h |
| Shanghai lockdown tests resilience of 'Zero-COVID' strategy, as economic and social... |
| Shanghai lockdown tests resilience of 'Zero-COVID' strategy, as economic and social tolls grow ABC News |
 "coronavirus news" - Google News 22h "coronavirus news" - Google News 22h |
| In India, cautious optimism on thaw in ties under new Pakistani PM - Arab News |
| In India, cautious optimism on thaw in ties under new Pakistani PM Arab News |
 "aggressive squirrels in new york city" - Google News 22h "aggressive squirrels in new york city" - Google News 22h |
| Sacramento shooting was gunfight among gang rivals: US police - Arab News |
| Sacramento shooting was gunfight among gang rivals: US police Arab News |
 "aggressive squirrels in new york city" - Google News 22h "aggressive squirrels in new york city" - Google News 22h |
 | Illinois Coronavirus Updates: New COVID Stats for Illinois, Mask Guidance, Symptoms... |
| Illinois Coronavirus Updates: New COVID Stats for Illinois, Mask Guidance, Symptoms NBC Chicago |
 "COVID" - Google News 22h "COVID" - Google News 22h |
| Dr. Scott Harris, Alabama's top health officer, tests positive for COVID-19 - AL.com |
| Dr. Scott Harris, Alabama's top health officer, tests positive for COVID-19 AL.com |
 "COVID" - Google News 22h "COVID" - Google News 22h |
| Allergies or COVID? How to know if your symptoms are seasonal allergies or COVID-19... |
| Allergies or COVID? How to know if your symptoms are seasonal allergies or COVID-19 The Olympian |
 "COVID" - Google News 22h "COVID" - Google News 22h |
 | Greece lifts COVID restrictions for summer tourism season - Reuters |
| Greece lifts COVID restrictions for summer tourism season Reuters |
 "COVID" - Google News 22h "COVID" - Google News 22h |
| Disease X-19 Regions from Michael_Novakhov (8 sites): Google Alert - coronavirus... |
| The world surpasses half a billion known coronavirus cases, amid concerns about testing. New Zealand... |
 Disease X-19 from Michael_Novakhov (12 sites) 22h Disease X-19 from Michael_Novakhov (12 sites) 22h |
| Disease X-19 Regions from Michael_Novakhov (8 sites): Google Alert - coronavirus... |
| With the state of disaster over, Murray Hunter questions what will happen to the ambitious, if chaotic,... |
 Disease X-19 from Michael_Novakhov (12 sites) 22h Disease X-19 from Michael_Novakhov (12 sites) 22h |
| Disease X-19 Regions from Michael_Novakhov (8 sites): Google Alert - coronavirus... |
| Israeli singer Aviv Geffen and his son Eliott were involved in a car crash in the ... Coronavirus in... |
 Disease X-19 from Michael_Novakhov (12 sites) 22h Disease X-19 from Michael_Novakhov (12 sites) 22h |
| Disease X-19 Regions from Michael_Novakhov (8 sites): Google Alert - coronavirus... |
| CAESAREA, Israel--(BUSINESS WIRE)--Apr 13, 2022-- Google Alert - coronavirus in israel Disease X-19... |
 Disease X-19 from Michael_Novakhov (12 sites) 22h Disease X-19 from Michael_Novakhov (12 sites) 22h |
| Disease X-19 Regions from Michael_Novakhov (8 sites): Google Alert - coronavirus... |
| Beyond Africa, scientists have confirmed cases in Belgium, Denmark, Germany and the United Kingdom. WHO... |
 Disease X-19 from Michael_Novakhov (12 sites) 22h Disease X-19 from Michael_Novakhov (12 sites) 22h |
| Disease X-19 Regions from Michael_Novakhov (8 sites): Google Alert - coronavirus... |
| On Wednesday, Iranian Health Ministry figures showed that 33 people died of Covid in the past 24 hours.... |
 Disease X-19 from Michael_Novakhov (12 sites) 22h Disease X-19 from Michael_Novakhov (12 sites) 22h |
| Department of Health Continues to Offer Free COVID-19 Testing, New Sites Available... |
| Department of Health Continues to Offer Free COVID-19 Testing, New Sites Available Pennsylvania Pressroom |
 "COVID-19" - Google News 22h "COVID-19" - Google News 22h |
 | You've Had COVID-19. Should You Still Get Vaccinated? A CDC-Epic Collaboration Provides... |
| You've Had COVID-19. Should You Still Get Vaccinated? A CDC-Epic Collaboration Provides the Latest Insight PR... |
 "COVID-19" - Google News 22h "COVID-19" - Google News 22h |
| Covid News: Biden Budget Plan Calls for More Pandemic Preparedness - The New York... |
| Covid News: Biden Budget Plan Calls for More Pandemic Preparedness The New York Times |
 "coronavirus news" - Google News 22h "coronavirus news" - Google News 22h |
| Baton Rouge doctor talks about COVID-19 variant XE - BRProud.com |
| Baton Rouge doctor talks about COVID-19 variant XE BRProud.com |
 "Covid-19" - Google News 22h "Covid-19" - Google News 22h |
| This Guelph master's student invites you to stroll with squirrels - CBC.ca |
| This Guelph master's student invites you to stroll with squirrels CBC.ca |
 "aggressive squirrels in new york city" - Google News 22h "aggressive squirrels in new york city" - Google News 22h |
| Washington health officials to consider requiring COVID vaccinations for students... |
| Washington health officials to consider requiring COVID vaccinations for students KING5.com |
 "COVID" - Google News 22h "COVID" - Google News 22h |
| How should COVID relief money be spent? What questions do you have? Take our survey... |
| How should COVID relief money be spent? What questions do you have? Take our survey Dayton Daily News |
 "COVID" - Google News 22h "COVID" - Google News 22h |
| No relaxation of COVID measures for China, says President Xi - Reuters |
| No relaxation of COVID measures for China, says President Xi Reuters |
 "COVID" - Google News 22h "COVID" - Google News 22h |
| Johns Hopkins researchers probe senseless COVID mystery: loss of smell - Baltimore... |
| Johns Hopkins researchers probe senseless COVID mystery: loss of smell Baltimore Sun |
 "COVID" - Google News 22h "COVID" - Google News 22h |
| RSU 5 Superintendent's Notebook: COVID challenges far from over for students, teachers,... |
| RSU 5 Superintendent's Notebook: COVID challenges far from over for students, teachers, parents Press... |
 "COVID" - Google News 22h "COVID" - Google News 22h |
| Global D-Psicose Market Growth Factors, Trends, Market Revenue and Forecasts: A Report... |
| Global D-Psicose Market Growth Factors, Trends, Market Revenue and Forecasts: A Report by Absolute Markets EIN... |
 "Coronavirus in meat plants" - Google News 22h "Coronavirus in meat plants" - Google News 22h |
 | Alabama's state health officer tests positive for COVID-19 - WSFA |
| Alabama's state health officer tests positive for COVID-19 WSFA |
 "COVID-19" - Google News 22h "COVID-19" - Google News 22h |
 | US Covid-19 Emergency Declaration Extended Another 90 Days - Bloomberg |
| US Covid-19 Emergency Declaration Extended Another 90 Days Bloomberg |
 "COVID-19" - Google News 22h "COVID-19" - Google News 22h |
 | Pulse Oximeters Offer No Added Benefits for Remote COVID-19 Monitoring - mHealthIntelligence.com |
| Pulse Oximeters Offer No Added Benefits for Remote COVID-19 Monitoring mHealthIntelligence.com |
 "COVID-19" - Google News 22h "COVID-19" - Google News 22h |
 | Calls for a New Approach to COVID-19 Vaccine Testing - Technology Networks |
| Calls for a New Approach to COVID-19 Vaccine Testing Technology Networks |
 "COVID-19" - Google News 22h "COVID-19" - Google News 22h |
| Disease X-19 Epidemiology from Michael_Novakhov (39 sites): Google Alert - coronavirus... |
| CDC Director Dr. Rochelle Walensky has previously said there's high enough level of immunity in the U.S.... |
 Disease X-19 from Michael_Novakhov (12 sites) 22h Disease X-19 from Michael_Novakhov (12 sites) 22h |
| Disease X-19 Epidemiology from Michael_Novakhov (39 sites): Google Alert - coronavirus... |
| The CT Mirror: Union Warns Five Nursing Homes Of Plans To Strike On April 22 ... of dollars into an industry... |
 Disease X-19 from Michael_Novakhov (12 sites) 22h Disease X-19 from Michael_Novakhov (12 sites) 22h |
| Disease X-19 Epidemiology from Michael_Novakhov (39 sites): Google Alert - coronavirus... |
| ... major nursing home strike last spring when they pumped hundreds of millions of dollars into an industry... |
 Disease X-19 from Michael_Novakhov (12 sites) 22h Disease X-19 from Michael_Novakhov (12 sites) 22h |
| Disease X-19 Epidemiology from Michael_Novakhov (39 sites): Google Alert - Covid-19:... |
| AP: COVID-19, Overdoses Pushed US To Highest Death Total Ever ... That's because genetic counselors —... |
 Disease X-19 from Michael_Novakhov (12 sites) 22h Disease X-19 from Michael_Novakhov (12 sites) 22h |
| Disease X-19 Epidemiology from Michael_Novakhov (39 sites): Google Alert - Covid-19:... |
| The data collected by My Reason will serve as a critical research tool linking ... impacts related to... |
 Disease X-19 from Michael_Novakhov (12 sites) 22h Disease X-19 from Michael_Novakhov (12 sites) 22h |
| Disease X-19 Epidemiology from Michael_Novakhov (39 sites): Google Alert - coronavirus... |
| The world surpasses half a billion known coronavirus cases, amid concerns about testing. New Zealand... |
 Disease X-19 from Michael_Novakhov (12 sites) 22h Disease X-19 from Michael_Novakhov (12 sites) 22h |
| Disease X-19 Epidemiology from Michael_Novakhov (39 sites): Google Alert - Sars Cov-2... |
| Illegal wildlife trafficking is the world's fourth largest illicit ... of disease from animals to humans... |
 Disease X-19 from Michael_Novakhov (12 sites) 22h Disease X-19 from Michael_Novakhov (12 sites) 22h |
| Disease X-19 General Issues from Michael_Novakhov (5 sites): Google Alert - Covid-19:... |
| The world surpasses half a billion known coronavirus cases, ... It is a recognition of how Covid-19 forced... |
 Disease X-19 from Michael_Novakhov (12 sites) 22h Disease X-19 from Michael_Novakhov (12 sites) 22h |
| Researchers detect the world's first wild river otter coronavirus case - Phys.org |
| Researchers detect the world's first wild river otter coronavirus case Phys.org |
 "Coronavirus in mink" - Google News 23h "Coronavirus in mink" - Google News 23h |
| Opinion | The argument over Twitter's edit button is all about vibes - The Washington... |
| Opinion | The argument over Twitter's edit button is all about vibes The Washington Post |
 "covid -19 origins" - Google News 23h "covid -19 origins" - Google News 23h |
| Statement on the eleventh meeting of the International Health Regulations (2005)... |
| Statement on the eleventh meeting of the International Health Regulations (2005) Emergency Committee... |
 "coronavirus news" - Google News 23h "coronavirus news" - Google News 23h |
| Police hunt gunman who wounded 10 in Brooklyn subway attack - News-Gazette.com |
| Police hunt gunman who wounded 10 in Brooklyn subway attack News-Gazette.com |
 "coronavirus news" - Google News 23h "coronavirus news" - Google News 23h |
| Thurston County adds 272 COVID-19 cases as virus activity remains moderate - The... |
| Thurston County adds 272 COVID-19 cases as virus activity remains moderate The Olympian |
 "Covid-19" - Google News 23h "Covid-19" - Google News 23h |
| US airlines, public transit passengers may travel without mask despite Omicron -... |
| US airlines, public transit passengers may travel without mask despite Omicron Hindustan Times |
 "Omicron" - Google News 23h "Omicron" - Google News 23h |
| WHO says omicron variant now accounts for 99.2% of global COVID cases and warns that... |
| WHO says omicron variant now accounts for 99.2% of global COVID cases and warns that people are still... |
 "Omicron" - Google News 23h "Omicron" - Google News 23h |
| Coronavirus tally: Omicron now accounts for 99.2% of all COVID cases as world passes... |
| Coronavirus tally: Omicron now accounts for 99.2% of all COVID cases as world passes half a billion confirmed... |
 "Omicron" - Google News 23h "Omicron" - Google News 23h |
| Broadway's Covid-Hit 'Plaza Suite', 'Paradise Square', 'A Strange Loop' Cancel Additional... |
| Broadway's Covid-Hit 'Plaza Suite', 'Paradise Square', 'A Strange Loop' Cancel Additional Performances,... |
 "COVID" - Google News 23h "COVID" - Google News 23h |
| Chronicling the cruel toll of COVID as US approaches 1 million deaths - Bangor Daily... |
| Chronicling the cruel toll of COVID as US approaches 1 million deaths Bangor Daily News |
 "COVID" - Google News 23h "COVID" - Google News 23h |
| UConn Professor: Alert US Executives Sold Stock Before COVID-Induced Price Plunge... |
| UConn Professor: Alert US Executives Sold Stock Before COVID-Induced Price Plunge - UConn Today UConn |
 "COVID" - Google News 23h "COVID" - Google News 23h |
| WHO: COVID cases and deaths fall for 3rd consecutive week - The Seattle Times |
| WHO: COVID cases and deaths fall for 3rd consecutive week The Seattle Times |
 "COVID" - Google News 23h "COVID" - Google News 23h |
 | Opinion: There's a drug to protect the most vulnerable from Covid-19. Why is it so... |
| Opinion: There's a drug to protect the most vulnerable from Covid-19. Why is it so hard to get? CNN |
 "COVID-19" - Google News 23h "COVID-19" - Google News 23h |
 | COVID-19 UPDATE: BA.2 Is 86% of All New Cases; 1761 New Cases Statewide; 1 Additional... |
| COVID-19 UPDATE: BA.2 Is 86% of All New Cases; 1761 New Cases Statewide; 1 Additional Kane Death kanecountyconnects.com |
 "COVID-19" - Google News 23h "COVID-19" - Google News 23h |
| Disease X-19 Epidemiology from Michael_Novakhov (39 sites): Google Alert - coronavirus... |
| They had no antibodies obtained from infection with the virus. As for 440 people who received three Pfizer... |
 Disease X-19 from Michael_Novakhov (12 sites) 23h Disease X-19 from Michael_Novakhov (12 sites) 23h |
| Disease X-19 Epidemiology from Michael_Novakhov (39 sites): Google Alert - coronavirus... |
| While PCR tests are still the gold standard for diagnosing COVID, ... Newcastle University created a... |
 Disease X-19 from Michael_Novakhov (12 sites) 23h Disease X-19 from Michael_Novakhov (12 sites) 23h |
| Disease X-19 Epidemiology from Michael_Novakhov (39 sites): Google Alert - coronavirus... |
| Over 15 Democrats have announced they have tested positive for Covid in the ... already have Covid antibodies... |
 Disease X-19 from Michael_Novakhov (12 sites) 23h Disease X-19 from Michael_Novakhov (12 sites) 23h |
| Disease X-19 Epidemiology from Michael_Novakhov (39 sites): Google Alert - Sars-Cov-2... |
| April 13 (Reuters) - China continued to battle sharp spikes in COVID-19 cases, pushing authorities to... |
 Disease X-19 from Michael_Novakhov (12 sites) 23h Disease X-19 from Michael_Novakhov (12 sites) 23h |
| Disease X-19 Epidemiology from Michael_Novakhov (39 sites): Google Alert - Coronavirus... |
| At the Kingston Health Sciences Centre, almost 200 of their 6,000 staff are currently off work sick or... |
 Disease X-19 from Michael_Novakhov (12 sites) 23h Disease X-19 from Michael_Novakhov (12 sites) 23h |
| Disease X-19 Epidemiology from Michael_Novakhov (39 sites): Google Alert - covid-19... |
| Boris Johnson is fined for breaking British lockdown rules. As pandemic-era remote work becomes permanent,... |
 Disease X-19 from Michael_Novakhov (12 sites) 23h Disease X-19 from Michael_Novakhov (12 sites) 23h |
| Disease X-19 Epidemiology from Michael_Novakhov (39 sites): Google Alert - Coronavirus... |
| Keltner said that after two years of operating at the covid political flashpoint, he's relieved the hospital... |
 Disease X-19 from Michael_Novakhov (12 sites) 23h Disease X-19 from Michael_Novakhov (12 sites) 23h |
| Disease X-19 Epidemiology from Michael_Novakhov (39 sites): Google Alert - covid-19... |
| Would you try pulled pork topped with Reese's peanut butter cups on a sandwich? https://www.fox7austin.com/news/bbq-reese ...... |
 Disease X-19 from Michael_Novakhov (12 sites) 23h Disease X-19 from Michael_Novakhov (12 sites) 23h |
| Disease X-19 Epidemiology from Michael_Novakhov (39 sites): Google Alert - coronavirus... |
| April 10, 2022. Editorial: Voter suppression gets deserved jolt in judge's ruling. When Florida's Republican... |
 Disease X-19 from Michael_Novakhov (12 sites) 23h Disease X-19 from Michael_Novakhov (12 sites) 23h |
| Disease X-19 Epidemiology from Michael_Novakhov (39 sites): Google Alert - Coronavirus... |
| A study out of the Rutgers School of Nursing shows that combined effects of COVID-19 and workplace racism... |
 Disease X-19 from Michael_Novakhov (12 sites) 23h Disease X-19 from Michael_Novakhov (12 sites) 23h |
| COVID: How do I know if I've been reinfected? - Verve Times |
| COVID: How do I know if I've been reinfected? Verve Times |
 "aggressive rats in new york city" - Google News 23h "aggressive rats in new york city" - Google News 23h |
| St. Louis man sentenced in coronavirus aid fraud scheme - KOMU 8 |
| St. Louis man sentenced in coronavirus aid fraud scheme KOMU 8 |
 "coronavirus news" - Google News 23h "coronavirus news" - Google News 23h |
 | New COVID-19 cases climb as Maine moves to end routine testing in schools - Press... |
| New COVID-19 cases climb as Maine moves to end routine testing in schools Press Herald |
 "COVID-19" - Google News 23h "COVID-19" - Google News 23h |
| Covid outbreaks in New York and DC infect senior officials as omicron BA.2 variant... |
| Covid outbreaks in New York and DC infect senior officials as omicron BA.2 variant sweeps the U.S. CNBC |
 "COVID" - Google News 23h "COVID" - Google News 23h |
| The Grief of 1 Million COVID Deaths Is Not Going Away - The Atlantic |
| The Grief of 1 Million COVID Deaths Is Not Going Away The Atlantic |
 "COVID" - Google News 23h "COVID" - Google News 23h |
| A million empty spaces: Chronicling COVID's cruel US toll - cleveland.com |
| A million empty spaces: Chronicling COVID's cruel US toll cleveland.com |
 "COVID" - Google News 23h "COVID" - Google News 23h |
| Covid, overdoses pushed US to highest death total ever - syracuse.com |
| Covid, overdoses pushed US to highest death total ever syracuse.com |
 "COVID" - Google News 23h "COVID" - Google News 23h |
| Disease X-19 Publications from Michael_Novakhov (5 sites): Google Alert - new york... |
| Visit the U.S. Centers for Disease Control and Prevention for more on COVID-19 cases. SOURCE: The New... |
 Disease X-19 from Michael_Novakhov (12 sites) 1d Disease X-19 from Michael_Novakhov (12 sites) 1d |
| Disease X-19 Publications from Michael_Novakhov (5 sites): Google Alert - coronavirus... |
| China's crude oil imports slipped 14% from a year earlier, extending a two-month slide, as strict coronavirus... |
 Disease X-19 from Michael_Novakhov (12 sites) 1d Disease X-19 from Michael_Novakhov (12 sites) 1d |
| Disease X-19 Publications from Michael_Novakhov (5 sites): Google Alert - new york... |
| Prime Minister Boris Johnson of Britain is fined for breaking lockdown rules. Here's what you need to... |
 Disease X-19 from Michael_Novakhov (12 sites) 1d Disease X-19 from Michael_Novakhov (12 sites) 1d |
| Disease X-19 Publications from Michael_Novakhov (5 sites): Google Alert - new york... |
| ... has landed in the number one spot on the New York Times. ... First, Matthew Broderick tested positive... |
 Disease X-19 from Michael_Novakhov (12 sites) 1d Disease X-19 from Michael_Novakhov (12 sites) 1d |
| RTE and RTC driving the North America Frozen Seafood Market in the Forecast Period... |
| RTE and RTC driving the North America Frozen Seafood Market in the Forecast Period of 2021-2026 | EMR... |
 "Coronavirus in fish and seafood" - Google News 1d "Coronavirus in fish and seafood" - Google News 1d |
Comments
Post a Comment